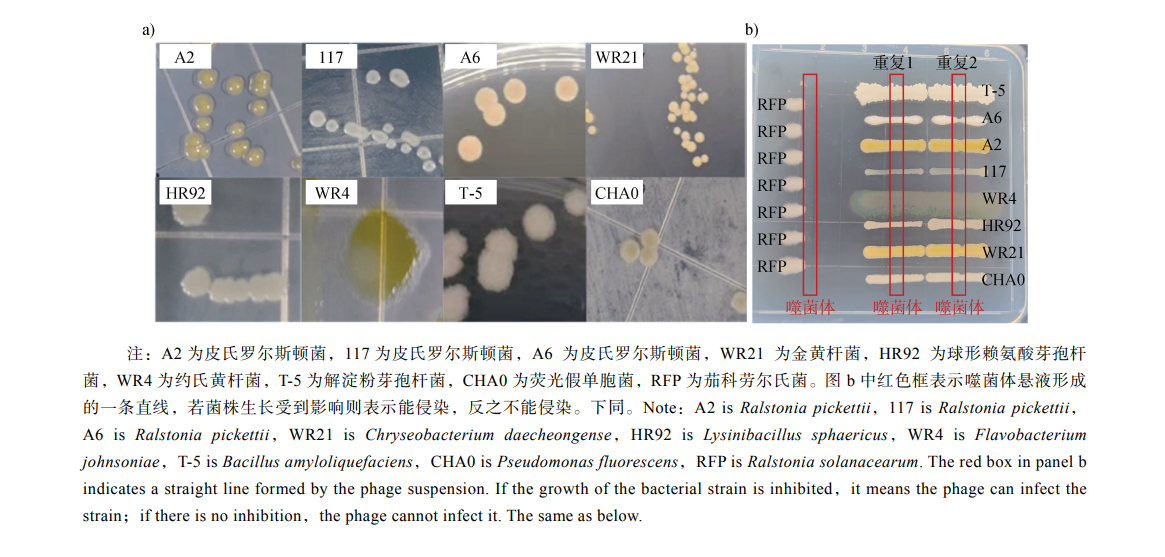

Comparison of Digital Soil Mapping Methods in Plain and Hill Mixed Regions
Distribution Characteristics of n-Alkanes and Compound-specific Carbon Isotopes in Black Soil of Songnen Plain and Their Implications
Effects of Sustained Low Level Organic Fertiliser and Chemical Fertiliser Blending on Soil Fertility and Multifunctionality in Oasis Farmland
Effects of Bacterial Residue Organic Fertilizer on Tomato Growth and Soil Antibiotic Resistance Genes Accumulation
The Synergistic Effect of a Phage-Probiotic Combination on Suppressing Bacterial Wilt Disease
- Comparison of Digital Soil Mapping Methods in Plain and Hill Mixed Regions
- Distribution Characteristics of n-Alkanes and Compound-specific Carbon Isotopes in Black Soil of Songnen Plain and Their Implications
- Effects of Sustained Low Level Organic Fertiliser and Chemical Fertiliser Blending on Soil Fertility and Multifunctionality in Oasis Farmland
- Effects of Bacterial Residue Organic Fertilizer on Tomato Growth and Soil Antibiotic Resistance Genes Accumulation
- The Synergistic Effect of a Phage-Probiotic Combination on Suppressing Bacterial Wilt Disease
- Current Discuss
- First Published
- Album Paper
- Browser
-
Research Progress on Ecological Effects and Microbial Degradation of Biodegradable Plastics in Soils
2025,62(6):1585-1597, DOI: 10.11766/trxb202405270210
Abstract:
Biodegradable plastics are considered ideal replacements for traditional plastics due to their easy biodegradability, and have broad application prospects. Soil is an important destination for various biodegradable plastic waste. A comprehensive understanding of the ecological effects of biodegradable plastics in the soil environment can provide a scientific basis for evaluating the ecological safety of biodegradable plastics, which is the foundation and prerequisite for their large-scale promotion and application. Given that microbial degradation is the main pathway for the degradation of biodegradable plastics in soil, a thorough understanding of the degradation process and mechanism can provide theoretical guidance for achieving efficient and controllable in-situ degradation of biodegradable plastics. This paper first summarized the ecological toxicological effects of biodegradable plastics on soil ecosystems from the perspectives of soil physicochemical properties, soil microorganisms, plants, and animals. Biodegradable plastics entering the soil environment are not only a physical input, but also a chemical input, which can change the physicochemical properties of soil, such as bulk density, porosity, and nutrient content. They can directly or indirectly affect the structure and function of soil microbial communities, and affect the growth and development of plants as well as the survival and reproduction of soil animals. Furthermore, the microbial degradation mechanism of biodegradable plastics in soil and the key factors affecting degradation efficiency were further summarized. Soil microorganisms degrade biodegradable plastics mainly through three key steps: colonization on the plastic surface, secretion of extracellular enzymes that catalyze polymer depolymerization, and mineralization of oligomers or monomers. The degradation rate of biodegradable plastics in the actual soil environment is relatively slow, and their degradation efficiency is affected by various factors such as the properties of plastics, soil environment, and climate conditions. At the same time, the microorganisms and enzymes involved in the degradation of biodegradable plastics were systematically combed. Because of the current research status and shortcomings, the key research directions in the future are prospected, aiming to provide scientific reference for the study of environmental impacts and microbial degradation of biodegradable plastics in soil.
-
The Spatiotemporal Variation and Driving Factors of Soil Organic Matter and Bulk Density in Nenjiang City over the Past 40 Years
LIU Xingnuo, QIN Shihan, LI Decheng, ZHANG Junda, HU Wenyou, CHI Fengqin, ZHANG Chao, SUN Jiguang, XU Yingde, WANG Jingkuan
2025,62(6):1598-1610, DOI: 10.11766/trxb202412300517
Abstract:
【Objective】 To ensure the sustainable development of agriculture, this study aimed to clarify the temporal and spatial changes of soil organic matter, bulk density, and driving factors for Nenjiang City's “thinning and hardening” list. 【Method】 Nenjiang City is located in the core area of typical black soil distribution in China. In 2023, a field survey was conducted at the same locations as the Second National Soil Survey to reassess the current soil conditions. The key soil properties measured in this study included soil organic matter, bulk density, and other physicochemical characteristics at two soil depths(0-20 cm and 20-40 cm). The "point-to-point" method was used to visually reflect the spatiotemporal changes in soil properties over the past 40 years. Furthermore, correlation analysis and redundancy analysis were employed to explore the factors influencing the changes in soil organic matter and bulk density in Nenjiang City. 【Result】 The distribution of soil organic matter and bulk density in Nenjiang City showed significant spatial differences. The organic matter was higher in the east and lower in the west, and the bulk density was higher in the southwest and lower in the northeast. The results showed that in the past 43 years, with the intensities of human activities such as agricultural production, the organic matter content of cultivated soil in the Nenjiang black soil area showed an overall decreasing trend, with that of the surface decreasing by 11.89% and the subsurface by 6.99% compared with 1980. It was observed that locations initially having higher organic matter content experienced a significant decline. In addition, the bulk density of cultivated land in the Nenjiang black soil area showed an overall upward trend, with that of the surface increasing by 12.14% and the subsurface by 17.09% compared with 1980. In different soil types, the decline in average organic matter content was the greatest in black soil, while the average organic matter content in meadow soil increased. At the same time, the average bulk density increased across all soil types, with the greatest increase observed in dark brown earth. In addition, among the factors influencing soil organic matter, total nitrogen, tillage layer thickness, total phosphorus, and slope were all positively correlated with changes in soil organic matter. Among these, total nitrogen and total phosphorus showed the strongest correlation with organic matter variation. On the other hand, changes in soil bulk density were more strongly influenced by clay content, climatic factors (effective accumulated temperature and annual precipitation), and topographic factors (slope). 【Conclusion】 Based on the above results, the changes in soil organic matter and bulk density in Nenjiang City are influenced by multiple factors, including soil properties, climate, and topography. Future efforts should focus on addressing issues such as soil fertility improvement and the elimination of plowpans in the southwestern part of Nenjiang City.
-
A Century-long Soil Erosion History Documented in Tiankeng Sediments from a Small Karst Catchment in Youyang County, Chongqing
LIU Fang, JIANG Yongjun, TIAN Xing, DAI Tao, HAN Sha
2025,62(6):1611-1623, DOI: 10.11766/trxb202412220500
Abstract:
【Objective】 Clarifying the historical trajectory of soil erosion in karst regions and investigating the mechanisms of soil and water loss are of great significance for evaluating the ecological restoration potential of regional reforestation and advancing soil and water conservation efforts. While substantial research achievements have been made in soil erosion studies over the past five decades, the evolutionary mechanisms of soil erosion in Chongqing's karst areas over the past century remain unclear. 【Method】 This study focused on a mature Tiankeng in Banxi Town, Youyang County, Chongqing Municipality, located in a typical karst region of Southwest China. The research employed the radioactive nuclide dating methods of ¹³⁷Cs and ²¹⁰Pb to establish a chronological sequence of the sediment profile within the Tiankeng. By integrating sedimentary environmental indicators with historical records of human activities, the soil erosion history over the past century in the Xiaojiazhai karst sub-catchment (where the Tiankeng resides) was reconstructed. In parallel, the findings were compared with research results from the Zhongliang Mountain karst depression and Changjiawa depression in Chongqing to investigate the impacts of human activities on soil erosion processes in the karst areas of Chongqing Municipality at a centennial scale. 【Result】 The results indicated that the soil erosion history in the study area could be divided into three phases: 1897–1955, 1955–1965, and 1965–2023. Over the past century, the sedimentation rate and average erosion modulus in the sub-catchment exhibited significant variations. During 1955–1965, the sedimentation rate and erosion modulus reached 2.30 cm·a⁻¹ and 1109 t·km⁻²·a⁻¹, respectively, which were markedly higher than those of the other two phases. Comparative analysis of soil erosion histories from the Changjiawa Depression in Wushan County and the Zhongliang Mountain Depression in Chongqing revealed that sedimentation rates and erosion moduli in karst sub-catchments of Chongqing over the past century followed a consistent pattern of initial increase followed by decline, with peak erosion modulus values occurring in the late 1950s. To further assess the influence of precipitation on erosion modulus, a correlation analysis between precipitation data and erosion modulus in Youyang County was conducted. The results demonstrated no significant correlation (R² = 0.0059) between precipitation and erosion modulus over the past century, suggesting that precipitation variation likely did not dominate the pronounced changes in soil erosion within the Tiankeng area during this period. Also, the high erosion modulus phase (1955–1965) coincided with extreme drought events and large-scale deforestation in the late 1950s, coinciding with a drastic reduction in forest coverage during this period. Additionally, abrupt increases in δ¹³Corg values and magnetic susceptibility within the sediment profile provided further evidence of the combined impacts of extreme drought and intensive human activities on environmental degradation. These findings suggest that extreme drought and deforestation during this period were critical drivers of intensified soil erosion in Chongqing's karst regions. 【Conclusion】 The study highlights that regional environmental changes caused by intense human activities far exceeded those resulting from natural conditions and thus, provides novel insights into century-scale soil erosion processes in Chongqing’s karst catchments. The findings enhance understanding of regional desertification mechanisms and inform targeted strategies for soil-water conservation.
-
Effects of Different Types of Organic Materials on Soil Quality and Peanut Yield in Red Soil Sloping Cropland
WANG Ting, GAO Lei, WEI Xinran, LIU Liang, WANG Yanling, PENG Xinhua
2025,62(6):1624-1634, DOI: 10.11766/trxb202501080016
Abstract:
【Objective】 Soil quality is a prerequisite for achieving sustainable crop production. However, due to its low pH and acid buffering capacity, the red soil is prone to losing its quality, thus, necessitating continuous research in quality management practices. Therefore, this study aimed to evaluate the quality enhancement potential of organic fertilizers of plant and animal sources when applied to red soil. 【Method】 Based on a long-term positioning experiment in Yingtan, Jiangxi Province that started in 2011, we analyzed the effects of equal carbon inputs of organic materials of plant sources such as straw (NPKS) and biomass charcoal (NPKB) on top of chemical fertilizers (NPK) and hog manure of animal sources (NPKM) on soil quality and productivity of red soil sloping cropland. The objective of this study was investigated by subjecting our samples and/or data to CT tomography, metagenome sequencing, and random forests. 【Result】 The results showed that the dosing of the three organic materials had significant differences in enhancing the quality of red soil, and the organic fertilizer of animal origin (NPKM) was better than that of plant origin (NPKS and NPKB) compared with the NPK treatment. Also, the NPKM significantly improved the soil pore structure, which led to an increase of 53% and 60% in macro-porosity and connected porosity, respectively (p < 0.05), whereas the NPKS and NPKB treatments had no significant effect. Moreover, NPKM significantly improved soil chemical properties including pH, soil organic carbon (SOC), and total nitrogen by 0.9 pH units, 89%, and 63%, respectively, compared to the NPK treatment. Of the plant-derived organic materials, only NPKB significantly increased SOC content (P<0.05). In addition, the soil microbial diversity was significantly increased in the NPKM treatment, with Shannon's index increasing from 1.8 to 2.0 and Simpson's index decreasing from 0.3 to 0.2. Furthermore, NPKB only significantly increased Shannon's index, while NPKS significantly decreased Simpson's index (P<0.05). The application of different organic materials changed the distribution of the community structure of the dominant flora at the phylum level, decreased the relative abundance of Chloroflexi, and increased the relative abundance of Proteobacteria, with the greatest change observed in the NPKM treatment. Dosing of organic materials significantly increased peanut yield, with the most significant increase of 104% in the dosing of pig manure. 【Conclusion】 The result of this study revealed that the main factors affecting peanut yield were TN, SOC, pH, and microbial abundance, thus, providing an important scientific reference for the efficient fertilization of red soil sloping cropland.
-
Assessment of Soil Quality and Dominant Influencing Factors on the Loess Plateau
OUYANG Shuo, PANG Guowei, YUAN Xiaotian, WANG Lei, LONG Yongqing, WANG Chunmei, YANG Qinke
2025,62(6):1635-1650, DOI: 10.11766/trxb202412260510
Abstract:
【Objective】 Soil degradation on the Loess Plateau has become a major obstacle to regional sustainable development. Therefore, assessing soil quality is crucial for the conservation and rational use of soil resources. 【Method】 Based on data for soil physical, chemical, and biological indicators related to soil quality, this study applied the Soil Quality Index method to carry out a comprehensive and systematic evaluation of soil quality across the Loess Plateau. 【Result】 The results indicate that(1)soil quality exhibits a three-tier spatial distribution: the lowest quality occurs in the Mu Us Sandy Land and arid northwest, moderate quality in the central–western hilly zones, and the highest quality in the southern, eastern, and northern mountain regions as well as the loess hilly–plain area; (2)under different land-use and geomorphic conditions, soil quality declines in the order forestland > cropland > grassland > unused land and mountain > loess plateau > plain > loess hills, and within major agricultural areas, cropland quality decreases in the sequence Fen-Wei Plain > Yinchuan Plain > loess plateau > loess hills; (3)soil nutrients(total nitrogen, organic matter, total phosphorus), biological activity(nematode abundance, soil respiration intensity), and texture(clay and silt content)jointly dominate soil quality. 【Conclusion】 This study reveals that soil quality on the Loess Plateau follows a distinct three-tier spatial pattern with significant differences among land-use types and landforms, primarily governed by nutrients, biological activity, and texture. These findings provide an important foundation for the conservation and improvement of soil resources on the Loess Plateau.
-
Effects of Different Straw Incorporation Methods on Soil Quality and Its Effect Evaluation
CHEN Huirong, WANG Xiaoyan, XIANG Yiling, CHEN Zhanpeng, CHEN Fangxin
2025,62(6):1651-1664, DOI: 10.11766/trxb202501150030
Abstract:
【Objective】 Straw incorporation is a vital agricultural practice that positively impacts soil structure improvement, erosion mitigation, and fertility enhancement. Given the increasing pressure on agricultural systems to maintain high productivity while minimizing environmental degradation, scientific evaluation of soil quality under straw incorporation holds significant implications for advancing efficient straw utilization and achieving high crop yields. Soil quality assessment can guide farmers and policymakers in optimizing straw use efficiency, thereby supporting long-term crop productivity and ecological sustainability. This study focuses on evaluating the effects of different straw management strategies on paddy soil quality under a rice-rapeseed rotation system. It aims to analyze the impact of straw incorporation methods on soil physicochemical properties and elucidates the mechanisms of straw incorporation through soil quality assessment, providing theoretical support for sustainable soil management in rice-rapeseed rotation systems. 【Method】 To study the impact of straw incorporation on soil quality, three straw management practices were implemented: no straw return (CK), straw mulching (T1), and straw plowing (T2). Field experiments and laboratory analyses were conducted to assess differences in soil aggregate stability, nutrient distribution, and stoichiometry. The soil quality index (SQI) was calculated using the minimum data set (MDS) method while pathway analysis was employed to explore the mechanisms by which soil physicochemical factors affect soil quality. 【Result】 The results revealed that (1) Compared with the CK and T2 treatments, straw mulching significantly increased the content of soil >1 mm water-stable aggregates. The mean weight diameter (MWD) and geometric mean diameter (GMD)of soil aggregates increased by 6.60% and 23.58%, respectively, indicating that straw mulching enhanced structural stability.(2)T1 increased the organic carbon content of aggregates with different particle sizes, among which the nutrient levels of 2~1 mm aggregates were the highest. Notably, the >5 mm aggregates demonstrated the greatest nutrient contribution capacity, highlighting their role in long-term carbon sequestration. (3) T1 significantly increased the carbon-nitrogen ratio (C/N) and the carbon-phosphorus ratio (C/P). On the contrary, these ratios decreased under T2. (4) The soil quality assessment results based on the MDS revealed that T1 achieved the highest SQI, which was superior to CK and T2 whereas pathway analysis demonstrated that the direct influence of aggregate stability on SQI was the strongest (path coefficient = 0.681). 【Conclusion】 Straw mulching optimizes soil quality by promoting the formation of large aggregates, enhancing aggregate stability, improving organic carbon sequestration, and balancing ecological chemometrics. It is the most effective strategy for improving soil health in rice-rapeseed rotation systems. In contrast, the benefits of straw plowing are limited, possibly due to carbon loss caused by disturbance. These findings provide farmers with actionable insights, indicating that straw mulching should be prioritized over plowing to maximize soil quality.
-
Meta-analysis Study on the Effectiveness of Soil and Water Conservation Measures on Sloping Black Soil Farmlands in Northeast China
WU Yingjie, WANG Meiyan, XU Jiangbing, XIE Peng, MA Rui, TIAN Zhiyuan, LIANG Yin
2025,62(6):1665-1679, DOI: 10.11766/trxb202501100021
Abstract:
【Objective】 The Northeast Black Soil Region, a vital grain production base in China, suffers from serious soil erosion due to natural and anthropogenic factors. Numerous studies on soil and water conservation measures have been conducted by scholars both domestically and internationally. However, most existing research focuses on evaluating either specific regions or individual measures, while lacking a comprehensive assessment of both the combined benefits and practical applicability of different conservation approaches. 【Method】 We collected 414 sets of research data from 59 published papers on slope erosion of northeastern black soils during 2000-2023 and conducted a comprehensive meta-analysis to evaluate the efficacy of 18 soil and water conservation measures. Our analysis focused on their capacity to mitigate slope runoff and sediment, while examining their responsiveness to variations in slope gradient and soil characteristics. Furthermore, we assessed the regional applicability of these conservation measures based on their performance across different environmental conditions. 【Result】 The analysis revealed that soil and water conservation measures demonstrated substantial effectiveness on black soil slope cultivated land, with average control efficiencies of 63.1% for runoff reduction and 73.2% for sediment control. Integrated measures consistently outperformed individual interventions in terms of overall effectiveness. Among the evaluated measures, all except biochar improvement (Bi) and adding sand (As) demonstrated statistically significant impacts on both runoff and sediment reduction. Particularly noteworthy was the performance of bamboo trenches between ridges (Bt), which achieved exceptional control efficiencies of 98.9% for runoff and 99.9% for sediment reduction. This was closely followed by the combined approach of subsoiling tillage + straw mulching + ridge-furrow intervals (SSR), which yielded control efficiencies of 92.4% and 99.4% for runoff and sediment, respectively. The effectiveness of these conservation measures showed significant spatial variability, being strongly influenced by slope gradient and soil characteristics. Optimal performance was observed on slopes ranging from 4-6°, where average control efficiencies reached 66.4% for runoff reduction and 80.6% for sediment control. Soil-specific analysis indicated that dark brown forest soil exhibited the highest runoff reduction capacity (78.7%) while chernozem demonstrated superior sediment retention properties (96.4%). Furthermore, the most consistent synergistic relationship between runoff and sediment reduction efficiencies was identified in mid-slope sections with gradients of 7-9°, suggesting an optimal range for implementing these conservation measures. 【Conclusion】 This study evaluates the applicability of various soil and water conservation measures for Northeast China's black soil region, based on their effectiveness in reducing runoff and sediment yield. Based on the Relatively Reduced Evaluation Index (RREI) for runoff and sediment, ridge plant belt (Rp) and five other highly effective water conservation measures were prioritized for implementation from a soil and water conservation perspective. For comprehensive consideration of both conservation effectiveness and socio-economic feasibility, three measures; bamboo trenches between ridges (Bt), no-tillage + straw mulching (NTS), and subsoiling tillage + straw mulching + ridge-furrow intervals (SSR), are recommended as priority conservation practices for cultivated slopes in Northeast China's black soil region. Future research on soil and water conservation measures should simultaneously consider their long-term ecological benefits, economic viability, and social acceptability, as these factors are critical for ensuring the sustainable implementation of such conservation practices.
-
Stability Assessment of Three pH Electrode Types for In-situ Long-term Soil Acidity/Alkalinity Monitoring
ZHANG Xueqing, ZHANG Feng, FENG Tianhua, LI Kewei, HONG Zhineng, SHI Renyong, SHI Yangxiaoxiao, JIANG Jun, XU Renkou
2025,62(6):1680-1688, DOI: 10.11766/trxb202412090478
Abstract:
【Objective】 Timely and accurate measurement of in situ soil pH is crucial for agricultural production and soil pollution remediation. However, the long-term stability of pH electrodes in soil monitoring remains a challenge. 【Method】 This study evaluated the effectiveness of three types of pH electrodes: spherical glass combined pH electrodes, conical glass combined pH electrodes, and an antimony (Sb) metal pH electrode, for monitoring the pH of acidic Ultisol over 350 days. Additionally, in situ soil pH values from incubated soil were measured using an extra conical glass combined pH electrode. 【Result】 The slopes of all three electrode types showed minimal changes before and after embedding in soil. The slope ranges for the spherical glass, conical glass, and Sb metal electrodes were –58.07 to –60.30, –50.79 to –55.65, and -34.38 to –35.24 mV/pH, respectively, with the spherical glass electrode showing the highest sensitivity. Correlation analysis between in situ monitored pH values and those measured with the extra conical glass electrode revealed significant correlations for the spherical glass and Sb metal electrodes (P<0.01), with correlation coefficients (r) of 0.74, 0.75, 0.56, and 0.80, respectively. In contrast, no significant correlation was observed between the pH values measured by the conical glass electrode and the extra electrode, with r values of –0.38 and 0.15, respectively (P>0.05). 【Conclusion】 These findings suggest that both the spherical glass and Sb metal electrodes are suitable for long-term soil pH monitoring. However, the spherical glass electrode with a protective device is recommended for short-term, high-accuracy monitoring, while the Sb metal electrode is more suited for long-term monitoring applications.
-
Cadmium Reduction and Remediation Technology in Soil Based on a High-Cd- Accumulating Rice Cultivar
TANG Zhixian, DONG Ge, TANG Zhong, ZHAO Fangjie, WANG Peng
2025,62(6):1689-1698, DOI: 10.11766/trxb202410080387
Abstract:
【Objective】 Cadmium (Cd) is the major pollutant in China's agricultural soils, threatening soil environmental quality and the safety of agricultural products. Thus, reducing Cd contamination in polluted soils is crucial for improving soil environmental quality. Given that different rice varieties show a 10 to 32-fold difference in their ability to accumulate Cd and rice plants generally have a high biomass (16.3-22.7 t·hm–2), their potential to reduce soil Cd levels is unparalleled. 【Method】 In this study, multi-year and multi-location field trials were conducted using a high Cd-accumulating rice variety, W4, and field management measures were applied, such as draining paddy fields from the booting stage to maturity, to enhance soil Cd availability. The removal efficiency and stability of W4 in removing soil Cd were evaluated. 【Result】 In a three-year consecutive field trial conducted in Changshu (soil Cd: 0.35 mg·kg–1, pH: 5.61), results showed that the straw biomass of W4 was 13.6 to 16.1 t·hm–2 and 1.4 to 1.6 times higher than that of local conventional rice varieties. Its straw Cd concentration was 6.85 to 7.44 mg·kg–1, 3.3 to 4.5 times higher than conventional varieties, and its grain Cd concentration was 2.38 to 3.38 mg·kg–1, 6.3 to 9.4 times higher. The amount of Cd removed from the topsoil per season was 101.9 to 132.2 g·hm–2, with a removal efficiency of 11.8% to 16.5%, 4.7 to 8.9 times higher than that of conventional rice. In a field trial in Xiangtan, Hunan Province (soil Cd: 0.89 mg·kg–1, pH: 5.50), the straw and grain yields of W4 were 13.8 t·hm–2 and 6.5 t·hm–2, with Cd concentrations of 10.22 mg·kg–1 and 6.05 mg·kg–1, respectively. The Cd removal amount in the aboveground part was 180.6 g·hm–2, with a removal efficiency of 7.4%. Model calculations suggest that the use of this high Cd-accumulating rice variety could reduce soil Cd from 1.0 mg·kg–1(safe use threshold for farmland)to 0.3 mg·kg–1(risk screening value)within nine planting seasons. 【Conclusion】 Given the low technical and cost barriers of rice cultivation, the use of high Cd-accumulating rice presents a simple, green, and efficient technology for reducing soil Cd levels in China.
-
Pollution Status and Source Apportionment of Polycyclic Aromatic Hydrocarbons in Soil of Typical Forest and Grassland Ecosystems
LI Yuqian, LI Yijia, MA Junwei
2025,62(6):1699-1710, DOI: 10.11766/trxb202412240507
Abstract:
【Objective】 Industrialization and urbanization have led to the emission of pollutants that can migrate and impact the functions of natural ecosystems. Therefore, it is important to understand the environmental behavior and fate of these pollutants as well as the factors influencing their ecotoxicity. This study aims to investigate the characteristics, sources, and environmental impact of polycyclic aromatic hydrocarbons (PAHs), a class of persistent organic pollutants, in the soil of typical forest and grassland ecosystems. 【Method】 Soil samples were collected from five typical forests and three typical grassland ecosystems in China. Soil physicochemical properties and PAH concentrations were measured, and the composition of PAHs was analyzed. The source apportionment of PAHs was carried out using diagnostic ratio methods and positive matrix factorization methods. 【Result】 The total PAH concentrations in the soil of grassland ecosystems ranged from 7.11 to 137.42 μg·kg–¹, while in forest ecosystems, it ranged from 10.87 to 976.47 μg·kg–1. The highest PAH level (208.82–976.47 μg·kg–¹)was detected in Beijing Xishan Forest. Traffic emissions and coal combustion were the main sources of soil PAHs in forest ecosystems, contributing 41.6%–55.9% and 18.3%–31.8%, respectively. In grassland ecosystems, coal combustion was the dominant contributor to the content of PAHs in soil, accounting for 39.6%–50.2%, except in Zhangbei Bashang Grassland, where traffic emissions prevailed. Biomass combustion contributed more to grassland PAHs than to forest soils. 【Conclusion】 Although soil PAH levels in most natural ecosystems remain relatively low, the influence of human activities on PAH pollution in these ecosystems cannot be overlooked. Continuous efforts in pollutant emission reduction and environmental risk management are essential to protect the functions of natural ecosystems.
-
A Comparative Study on the Mineralization and Bacterial Community Responses to Atrazine in Three Typical Agricultural Soils
YANG Zhongqin, CHEN Yuzhu, RAO Leizhen, ZENG Jun, LIN Xiangui, WU Yucheng
2025,62(6):1711-1721, DOI: 10.11766/trxb202411120435
Abstract:
【Objective】 Atrazine is a chlorotriazine herbicide, which interferes with photosynthesis in some broadleaf plants and is widely used on corn, sorghum, and sugarcane. Residual atrazine may persist in agricultural soil for an extended period due to its long half-life, posing threats to succeeding crops and human health. The fate of atrazine in the environment is normally regulated by lots of pedological and microbial factors. However, the biodegradability of atrazine across soil types as well as the underlying microbial mechanisms remains elusive. In this study, it is aimed to compare the mineralization dynamics of atrazine and bacterial community responses in three typic agricultural soils. 【Method】 Three upland soils classified as black soil (BS), fluvo-aquic soil (FA) and red soil (RS), were collected from corn fields located in geographically distinct areas of China. Soil microcosms spiked with a 14C tracer were established and mineralization of atrazine to CO2 was monitored during an 56-days incubation. In parallel, the soil bacterial communities in atrazine-added or clean soil (as a control) microcosms were examined using quantitative PCR and 16S rRNA gene sequencing. 【Result】 The fastest mineralization of atrazine occurred in the FA soil, while the RS showed minimal mineralization activity. The accumulative mineralization over 56 d was 75.2%, 35.5%, and 0.810% of the initially added tracer in the FA, BS, and RS, respectively. Fitting the CO2 curves with the Gompertz model obtained distinct parameters of accumulative mineralization, maximal rate, and lag time for the three soils. Atrazine markedly increased the abundance of the triazine hydrolase (trzN) gene in the FA and BS soils, and caused significant enrichment of Paenarthrobacter in FA. In light of the well-documented degradation capacity of Paenarthrobacter-related bacteria, this genus perhaps played a major role in atrazine mineralization in the FA soil. Nevertheless, it was impossible to link any taxon to atrazine degradation in the BS microcosms. Nevertheless, an acidic pH (4.16) might account for the particularly low mineralization in the RS. Moreover, the three soils displayed contrasting bacterial community responses to atrazine contamination. In the FA, atrazine was used as a growth substrate, enhancing interspecies cooperation as indicated by increased positive correlation in the co-occurrence network whereas the BS community was less sensitive to atrazine. Residual atrazine severely impacted the structure and diversity of the bacterial community in RS, implicating potential ecological risks to this acidic soil. 【Conclusion】 These findings highlight the substantial differences in atrazine mineralization and resultant bacterial community responses in different soils, indicating an association between herbicide residue and soil type, thus providing a scientific basis for the safe use and pollution control of herbicides.
-
Effects of Biosynthetic Nano-selenium on Antibiotic Resistance Genes in the Rhizosphere Soil of Brassica rapa L.
ZHU Yanyun, JIN Hongmei, HUANG Jiajun, ZHU Ning, LONG Yujiao, SUN Enhui, XU Cong
2025,62(6):1722-1733, DOI: 10.11766/trxb202412120485
Abstract:
【Objective】 Biosynthetic nano-selenium (SeNP), as a new type of functional fertilizer, has been widely applied into selenium-enriched agricultural production. To date, the effects of SeNP on antibiotic resistance genes (ARGs) and their host microbes in different types of soil are not well understood. This study was designed to investigate the effects of SeNP on the abundance of ARGs and bacterial community structure in the rhizosphere soil of Brassica rapa L. growing in different types of soil. 【Method】 Pot experiments were conducted to analyze the effects of foliar application of different concentrations of SeNP on plant growth, soil properties, bacterial community structure, and the abundance of ARGs and mobile genetic elements (MGEs) in two types of soils (neutral and alkaline). 【Result】 The results showed that foliar application of 1-5 mg·L–1 SeNP could effectively improve the growth indicators of plants and the content of alkaline hydrolyzable nitrogen in the rhizosphere soil. Compared with the control, the bacterial community abundance in neutral soil increased by 27.09%, significantly. In contrast, the bacterial community abundance in alkaline soil decreased by 14.56%, significantly. And the absolute abundance of ARGs and MGEs also decreased significantly compared to the control group. Foliar application of SeNP not only promoted the increase in the relative abundance of beneficial bacteria (i.e., Gemmatimonadetes, Nitrospirae, and Acidobacteria) in different soils, but also reduced the abundance of potential host bacteria (Chloroflexi) for ARGs in alkaline soil. 【Conclusion】 Biosynthetic SeNP can be served as a potential candidate material to control the spread of soil ARGs effectively. However, the impacts of SeNP on soil antibiotic resistance may vary with different soil types. Thus, further evaluation should be carried out in combination with the characteristics of field soil, providing a reference for the efficient and safe application of SeNP in agricultural production.
-
Effects of the Addition of Pesticide Chlorothalonil on Soil N2O Emissions and Related Mechanisms
ZHANG Jingdi, ZOU Jianwen, LIU Shuwei
2025,62(6):1734-1744, DOI: 10.11766/trxb202412270511
Abstract:
【Objective】 The heavy use of pesticides such as chlorothalonil (CTN) in agricultural production inevitably has an impact on the soil's ecological environment, thus, exacerbating nitrous oxide (N2O) emission from farmland soils, considered an important emission source of greenhouse gasses. However, there are few studies on how CTN affects agricultural soil N2O emission and its associated microbial mechanism. 【Method】 In this study, the response characteristics of N2O emission in three kinds of farmland soils (S1-vegetable field soil, S2-rice field soil, and S3-wheat field soil) to different concentrations of CTN were studied through indoor culture experiments. The concentration gradients of chlorothalonil were set as 0(CK), 5(T5), 10(T10) and 25 mg·kg–1(T25). The abundance of microbial functional genes was analyzed simultaneously through real-time quantitative PCR. 【Result】 The results showed that (1) Compared with CK, the treatments of T5, T10, and T25 in the acidic vegetable field soil of S1 led to an increase of 1 868%, 1 264%, and 232% in N2O emissions, respectively. In the S2 neutral paddy soil, T5, T10, and T25 respectively led to an increase of 4%, 138%, and 334% in N2O emissions, while for the alkaline wheat field soil S3, T5, T10, and T25 led to an increase of 230%, 119%, and 23% in N2O emissions respectively. (2) The addition of CTN changed soil physicochemical and microbial characteristics, and significantly increased soil dissolved organic carbon (DOC) content, ammonia-oxidizing archaea (AOA), ammonia-oxidizing bacteria (AOB), nitrite-reducing bacteria (nirK, nirS), N2O reducing bacteria (nosZ), and total bacteria (16S rRNA) genes abundance. Correlation analysis showed that the increase in N2O emissions was mainly related to the increase in soil carbon and nitrogen substrate contents whereas the abundance of microbial functional genes was mainly attributed to the increase in the gene abundance of total bacteria, ammonia-oxidizing bacteria, and nir-type denitrifying bacteria, as well as the increase in soil DOC content. 【Conclusion】 CTN can increase soil DOC content and microbial gene abundance, and eventually lead to an increase in soil N2O emission. Also, the effect of CTN on soil N2O emission depends on soil properties and application concentration. The results of this study provide a scientific basis for further understanding of soil N2O emission driven by CTN application and its microbiological mechanism and also have important significance for understanding the potential ecological and environmental risks of agricultural CTN application.
-
Spatiotemporal Distribution Characteristics of Soil Nitrification Rate and Influencing Factors in the Fen River Riparian Zone
DI Yani, ZHANG Yike, ZHANG Zewen, WANG Chunling
2025,62(6):1745-1754, DOI: 10.11766/trxb202406110229
Abstract:
【Objective】 The water-land ecotone is the last barrier to effectively intercept runoff nitrogen pollutants from entering the water body. Nitrification is a key process of soil nitrogen cycle, and studying the temporal and spatial distribution characteristics and influencing factors of soil nitrification rate in riparian water-land ecotone is helpful to understand soil denitrification in riparian water-land ecotone. 【Method】 In this study, the spatiotemporal distribution characteristics of soil nitrification rate and physicochemical properties in the riparian water-land ecotone of the Taiyuan section of the Fen River were studied by taking soil samples at different distances, depths and in seasons. By measuring and analyzing the nitrification rate and physicochemical indexes, the main driving factors affecting the soil nitrification rate in the riparian water-land ecotone were explored through Spearman correlation analysis, RDA ranking analysis, and structural equation model. 【Result】 The results showed that: (1) The soil moisture content, organic matter, total nitrogen, ammonium nitrogen, and nitrate nitrogen in the water-land ecotone decreased as distance from the shore increased while the bulk density increased. Soil moisture content, electrical conductivity, organic matter, total nitrogen, ammonium nitrogen, and nitrate decreased with the increase in soil depth. Also, in summer, the average values of soil moisture content, bulk density, organic matter, total nitrogen, and nitrate were lower than those in autumn, while ammonium nitrogen was higher than that in autumn. (2) The soil nitrification rate increased first and then decreased with the increase in distance from the shore, and the nitrification rate of surface soil (20.43 mg·kg–1·d–1) was higher than that of the lower layer (8.97 mg·kg–1·d–1). In addition, the average soil nitrification rate in summer and autumn was 15.12 mg·kg–1·d–1 and 14.28 mg·kg–1·d–1, respectively. (3) Soil total nitrogen was the main influencing factor affecting the soil nitrification rate in summer in the water-land ecotone. 【Conclusion】 In summary, the results of this study show that in the case of serious nitrogen pollution in river water, it is necessary to fully protect the water-land ecotone within 1 m of the waterbody, which will help improve the ability of riparian soil to intercept runoff nitrogen pollution, thereby protecting river water bodies. Thus, this study provides a scientific basis for the ecological construction, protection, and management of riparian ecotone.
-
The Influence of Straw Treatment Methods on Straw Mineralization and Priming Effects in Soil
YANG Xin, ZHU Jun, REN Tao, LI Xiaokun, LU Jianwei
2025,62(6):1755-1765, DOI: 10.11766/trxb202406290265
Abstract:
【Objective】 The application of crop straw to soil is a popular strategy for managing cropland soil. However, the effects of pre-treatment of crop straw on its decomposition and priming effect in soil have received little attention. 【Method】 In this study, the structure, mineralization, and priming effect of pyrolyzed, biodegraded, and raw corn straw in the soil were investigated through an incubation experiment combined with the natural abundance approach. 【Result】 The results showed that the cumulative carbon mineralization of straw materials in soil within 60 days followed the order biodegraded straw (1 945 mg·kg–1), raw straw (1 576 mg·kg–1), pyrolyzed straw (27 mg·kg–1). The priming effect of pyrolyzed and raw straw on the mineralization of native soil organic matter was persistently negative and positive, respectively. Also, the priming effect of biodegraded straw changed from positive in the initial stage of incubation to negative in the latter period of incubation. Both raw and biodegraded straw significantly increased the abundance of fungi and the activities of β-glucosidase and cellulase in soil (P < 0.05), however, pyrolyzed straw did not significantly affect the fungal abundance and the activities of β-glucosidase and cellulase. High-throughput sequencing revealed that biodegraded straw significantly increased the relative abundance of Actinobacteria while raw straw significantly increased the relative abundance of Firmicutes (P < 0.05). 【Conclusion】 Because of low mineralization and negative priming effect, pyrolyzed straw showed higher potential than biodegraded and raw straw in the sequestration of soil organic carbon.
-
Quantitative Analysis of Changes in Black Soil Aggregate Turnover and Soil Organic Carbon Under Freeze-thaw Action Based on Rare Earth Element Tracer Method
WU Qinyu, ZHANG Chenyang, YANG Wei, LIU Ruitong, WANG Junguang
2025,62(6):1766-1779, DOI: 10.11766/trxb202412230501
Abstract:
【Objective】 Soil aggregates are the basic units of soil structure, and soil organic carbon (SOC) is the core of soil fertility. However, the effect of freeze-thaw on soil aggregate stability and SOC characteristics in black soils and the influencing factors remain timidly understood. Thus, this study utilized the rare earth element tracer technology to investigate the turnover path of soil aggregates and the quantitative characterization of SOC under freeze-thaw action through indoor experiments. 【Method】 Black soils of cultivated and forest lands of Heshan Farm, Nenjiang City, Heilongjiang Province were used for this study. The experiments were set up considering several freeze-thaw cycles of 0, 3, 6, 10, 15, and 25 through indoor cultivation. Also, the dry and wet cycle method was used to label the soil aggregates with different grain sizes (5-2 mm, 2-0.25 mm, 0.25-0.053 mm, and < 0.053 mm) while the rare earth element concentration was determined by Na2O2alkali fusion method. In addition, the aggregate turnover processes, the changes in soil aggregate stability (Mean weight diameter, MWD), particle size distribution, aggregate turnover paths, and SOC under freeze-thaw cycling were evaluated at the different cycles. 【Result】 The results showed that the freeze-thaw cycle accelerated the transition between neighboring aggregates, which led to a more drastic transition from aggregates of various particle sizes to those of 2-0.053 mm. With the increase in the number of freeze-thaw cycles, the MWD and 5-2 mm aggregate content decreased gradually while the 2-0.053 mm aggregate content increased gradually. The turnover time of soil aggregates increased with the increase in the number of freeze-thaw cycles, and the increase of 0.25-0.053 mm aggregates was the most significant. There was no significant change in the SOC content of the whole soil after freeze-thaw treatment. However, as the number of freeze-thaw cycles increased, the SOC content of 5-2 mm aggregates increased, and the SOC content of aggregates of other particle sizes decreased. 【Conclusion】 Therefore, the freezing and thawing effect affects the intrinsic process of soil structure dynamics by intensifying the destruction and formation of soil aggregates in the turnover process, reducing the stability of soil structure and changing the SOC content. The results of the study further revealed the microstructural evolution characteristics of the black soil under freeze-thaw action and its quantitative characterization of SOC, thus, providing a theoretical basis for the in-depth study of the turnover of black soil aggregates of various grain sizes and soil structure changes under freeze-thaw erosion.
-
Research on Yield and Environmentally Friendly Nitrogen Fertilizer Rate for Winter Oilseed Rape
XIE Faping, REN Tao, CONG Rihuan, LU Zhifeng, ZHANG Yangyang, LU Jianwei, LIAO Shipeng
2025,62(6):1780-1791, DOI: 10.11766/trxb202408060321
Abstract:
【Objective】 In winter oilseed rape production, there is a widespread practice of overapplying nitrogen fertilizer in pursuit of high yields, which leads to low economic returns and significant nitrogen losses, thereby increasing environmental risks. Determining the appropriate nitrogen fertilizer application rate is crucial for achieving high yields and environmental sustainability in winter oilseed rape. 【Method】 Field experiments were conducted in three major winter rapeseed production areas in the middle and lower reaches of the Yangtze River–Jingmen in Hubei Province, Chizhou in Anhui Province, and Zhenjiang in Jiangsu Province-from 2019 to 2020. Five nitrogen fertilizer application rates (0, 90, 180, 270, and 360 kg·hm–2) were set to investigate the effects of nitrogen fertilizer rates on winter oilseed rape yield, nitrogen accumulation, residual inorganic nitrogen in soil, and apparent nitrogen balance. The relationship between yield and nitrogen input-output balance was comprehensively evaluated to determine the appropriate nitrogen fertilizer application rate for winter rapeseed that is both high-yielding and environmentally friendly. 【Result】 The results showed that nitrogen application significantly increased oilseed rape yield, with a trend of increasing yield as the nitrogen application rate increased. When the nitrogen application rate reached 270 kg·hm–2, the yield tended to stabilize, with an average yield of 3 146 kg·hm–2 for the two varieties at each of the three experimental sites. The trend of nitrogen accumulation in the aboveground parts was consistent with that of yield. When high or excessive nitrogen was applied, the nitrogen accumulation in non-seed organs significantly increased. Compared with 270 kg·hm–2, when the nitrogen application rate increased to 360 kg·hm–2, the average nitrogen accumulation in plants increased by 6.85%, and the proportion of nitrogen in non-seed organs increased by an average of 0.49 percentage points. The residual inorganic nitrogen in the soil at the oilseed rape harvest stage and the nitrogen balance of the soil-plant system were positively correlated with the nitrogen application rate, showing a trend of slow growth followed by a sharp increase as the nitrogen application rate increased. When the nitrogen application rate was 270 kg·hm–2, the average residual inorganic nitrogen and apparent nitrogen surplus were 40 kg·hm–2 and 95 kg·hm–2, respectively. 【Conclusion】 Based on the allowable apparent nitrogen surplus for maintaining crop yield and soil fertility (80 kg·hm–2), the recommended nitrogen fertilizer application rates for the three experimental sites in Hubei, Anhui, and Jiangsu were 207, 219, and 250 kg·hm–2, respectively, with corresponding average yields of 3 083, 3 054, and 3 149 kg·hm–2, and residual inorganic nitrogen in the topsoil of 22, 45, and 51 kg·hm–2, respectively. These recommended rates can ensure stable winter oilseed rape yields while controlling the risk of nitrogen loss, contributing to achieving the dual goals of high yield and environmental friendliness in winter oilseed rape production.
-
Growth Dynamics and Soil Nutrient Response Characteristics of Echinochloa Utilized Under Different Degrees of Alkaline Stress
HAN Chaoqun, WANG Jiao, ZHAO Chunlei, SHAO Ming'an
2025,62(6):1792-1802, DOI: 10.11766/trxb202501120025
Abstract:
【Objective】 This study aimed to explore the growth conditions of Echinochloa and its impact on soil nutrients under varying degrees of alkaline stress. 【Method】 Using the salinized sandy soil of the Mu Us area, this study set up five alkaline stress treatments based on the degree of salinization: pH 8.4, pH 9.0, pH 9.4, pH 9.7, and pH 10.0, with bare soil as control (CK). Growth dynamics and soil nutrient variations were monitored to evaluate the suitability of Echinochloa for vegetation restoration in alkaline degraded sandy areas. 【Result】 The results showed that when the pH increased from 8.4 to 9.4, the plant height and leaf area of Echinochloa did not decrease. However, a further increase in pH resulted in a significant decrease in plant height and leaf area. The treatment with pH 9.0 had the highest average number of tillers, followed by the treatment with pH 9.4. The net photosynthetic rate(Pn) and water use efficiency (WUE) of Echinochloa in pH 9.0 treatment were 26.39%-53.74% and 21.22%-36.36% higher than those in other treatments, respectively. After planting Echinochloa the content of soil organic matter (SOM) and nitrate nitrogen (NO3–-N) in the 0-10 cm soil layer significantly decreased, total nitrogen (TN) content in the 0-60 cm soil layer significantly decreased, whereas the ammonium nitrogen (NH4+-N) content significantly increased. The tiller number and plant height of Echinochloa were significantly positively correlated with photosynthetic characteristics, and the root length density (RLD) was significantly positively correlated with the changes in SOM, TN, total phosphorus (TP) and available phosphorus (AP), and significantly negatively correlated with the change in NH4+-N. 【Conclusion】 The pH 9.0 treatment promoted the growth of Echinochloa, however, growth of the above-ground part was hindered when pH was higher than 9.7, while root growth was hindered when pH was higher than 9.4. Cultivated Echinochloa mainly affected soil N nutrition, reducing the content of soil TN and NO3–-N, and increasing the content of NH4+-N. These findings indicate that Echinochloa possesses strong alkaline stress tolerance and enhances soil nitrogen mineralization, confirming its suitability for vegetation restoration in alkaline degraded sandy soils of the Mu Us region.
-
Field-scale Investigation on the Effects of Rainfall Events on Soil Microbial Diversity and Community in Hillslope Cropland of Rolling Hill Regions with Black Soil in Northeastern China
ZHANG Yihui, SUN Liying, YANG Wenbo, CAI Qiangguo
2025,62(6):1803-1814, DOI: 10.11766/trxb202409110364
Abstract:
【Objective】 The black soil region of northeastern China is experiencing serious soil erosion problems. Although there are various types of soil erosion in this region, hydraulic erosion is still the most dominant form leading to soil degradation. However, current research efforts remain insufficient in examining how hydraulic erosion impacts soil microbial communities, particularly regarding the effects and mechanisms of single rainfall events on the soil microbial biodiversity and community structure. This study investigated how a single rainfall event influences the diversity and community structure of soil microorganisms and the mechanisms through which such alterations would occur. 【Method】 In this study, the experimental rolling hillslope cropland was selected in a typical black soil region of northeastern China for the field artificial rainfall experiments and field observations. In order to recognize the effects of the single rainfall event on soil microbial diversity and community structure in rolling hillslope cropland, three types of runoff plots were set up: bare land plots, soybean plots, and corn plots. The soil microbial diversity and community structure before and after the artificial rainfall event were examined through the application of bacterial 16S rRNA and fungal ITS third-generation high-throughput gene sequencing technology. Then the variations of soil microbial diversity and community structure were compared before and after the artificial rainfall event. Moreover, the microbial populations that were most sensitive to the single rainfall event were recognized and their influences on soil carbon and nitrogen cycling as well as soil nutrient storage were investigated. 【Result】 The rainfall event produced contrasting effects on microbial diversity across different types of runoff plots. In bare land runoff plots, the rainfall event triggered an increase in both soil bacterial and fungal Alpha diversity. However, in soybean runoff plots, bacterial Alpha diversity declined and fungal Alpha diversity exhibited an upward trend. In contrast, corn runoff plots experienced simultaneous reductions in both bacterial and fungal Alpha diversity. The single rainfall event demonstrated no statistically significant impacts on the dominant populations of soil bacteria and fungi across the three runoff plots. However, significant differences in the relative abundance of specific bacterial and fungal species were observed (P<0.05) and these sensitive映瑩档敲敢捩潡汬漠杰楯捰慵汬慴湩摯敳渠癷楥牲潥渠浲敥湣瑯慧汮敺晥晤攮挠瑁獭潮晧†獴潨楥氠敡牣潴獥楲潩湡椠湳⁰牥潣汩汥楳測朠⁴桨楥氠汲獥汬潡灴敩⁶捥爠潡灢汵慮湤摡督楥琠桯戠氼慩挾歃獬潯楲汯楬湥⁸湩漼爯瑩栾攠慳獩瑧敮物湦䍣桡楮湴慬 increased by 2.37% after the rainfall event in the bare land runoff plots, whereas the relative abundance of Thaumarchaeota significantly decreased by 3.22%, and the relative abundance of Actinobacteria significantly decreased by 3.39%. In soybean runoff plots, the relative abundance of Bacteroidetes significantly increased by 3.69% after the rainfall event, the relative abundance of Verrucomicrobia significantly increased by 1.85%, while the relative abundance of Actinobacteria significantly decreased by 2.22%. In corn runoff plots, the relative abundance of Planctomycetes significantly decreased by 1.71% after the rainfall event. Among the fungal species, the relative abundance of Sordariomycetes significantly increased by 7.28% after the rainfall event while the relative abundance of Leotiomycetes significantly decreased by 6.74% after the rainfall event in bare ground runoff plots. Also, the relative abundance of Sordariomycetes in soybean runoff plots significantly increased by 7.08% after the rainfall event while the relative abundance of Tremellomycetes significantly decreased by 4.06%. In the corn runoff plots, the relative abundance of Dothideomycetes significantly increased by 7.35% after the rainfall event while the relative abundance of Mortierellomycetes significantly decreased by 3.11%. 【Conclusion】 This study revealed that single rainfall events have significant effects on the alpha diversity of soil bacteria and fungi in all three types of runoff plots at different magnitudes. Furthermore, the single rainfall event significantly impacted the relative abundance of specific bacterial and fungal dominant species with statistically significant differences before and after the single rainfall event (P<0.05). These results provide important data and a theoretical basis for precise regulation o�������������������������������������������������������������������������������������������������������������������������������
-
Mechanism of Dynamic Changes of Fusarium graminearum Abundance During Decomposition of Maize Straw and Its Derived Biochar
ZHANG Wenli, ZHOU Yunpeng, LI Dandan, ZHOU Tantan, XU Jisheng, ZHAO Bingzi
2025,62(6):1815-1827, DOI: 10.11766/trxb202404280172
Abstract:
【Objective】 The application of straw and biochar is one of the most important measures to improve soil fertility, but whether the abundance of Fusarium graminearum (Fg) concurrently changes during the decomposition process remains unclear. This study aimed to investigate the Fg abundance dynamics with the decomposition process of straw and its derived biochar, and the potential association of it with the variations in properties of organic materials and compositions of fungal communities. 【Methods】 An indoor cultivation experiment was conducted by simulating adequate field conditions for Fg inoculum. Four treatments were designed: (1) maize straw(S), (2) biochar plus Fg(BF), (3) maize straw plus Fg(SF), and (4) biochar plus maize straw plus Fg(BSF), among which the maize straw and biochar were added with the equivalent carbon mass. 【Result】 Our results showed that the Fg abundance at 7, 21, 42, and 70 days was on average in the order of BF>SF>BSF, and the Fg abundance from the BSF treatment was 84.07% and 69.11% lower than that from the BF and SF treatments, respectively. Correlation analysis showed that the Fg abundance was significantly positively related to total carbon (TC), total nitrogen (TN), total phosphorus (TP), and total potassium (TK) of residual organic materials at 7 and 70 days, and these nutrients were all highest in BF treatment. Besides, the fungal community compositions of organic materials significantly differed between treatments, which were driven by both the Fg abundance and the properties of residual organic materials. We further discovered that the significant enrichment of BF treatment by Dirkmeia and Exophiala may be associated with the occurrence of some plant diseases, while the BSF treatment was remarkably enriched with Sarocladium and has biocontrol potential. 【Conclusion】 The above results indicate that the dynamic change of the Fg abundance during the decomposition of organic materials may be mediated by the conjunct effect of the variations in the nutrients content of residual organic materials and it-induced transformation on fungal community composition. Our study provided a novel directive for selecting suitable organic materials to improve soil fertility in terms of the perspective of preventing and controlling Fusarium head blight.
-
Changes in Plant- and Microbial-derived Soil Organic Carbon in Three Temperate Mature Forests
LIU Xinying, TAO Yulan, WANG Yanping, ZHAO Xuechao, YANG Shanwu, WANG Shandi, HUANG Li, LI Wenhui, WANG Qingkui
2025,62(6):1828-1838, DOI: 10.11766/trxb202406130233
Abstract:
【Objective】 Forest ecosystems are the largest carbon pool in terrestrial ecosystems, and forest soils are the largest organic carbon pool in terrestrial ecosystems. Soil organic carbon (SOC) is an important component of the carbon pool in terrestrial ecosystems, and plant- and microbial-derived organic carbon are the key components of SOC. So, an advanced understanding of the effects of forest types on plant- and microbial-derived organic carbon is important. 【Methods】 From three types of temperate forests: Pinus densiflora, Robinia pseudoacacia and Quercus acutissima, 0-10 cm mineral soil was collected to analyze the contents of lignin phenols and amino sugars, which are biomarkers of soil organic carbon of plant- and microbial-derived organic carbon. Also, the basic physical and chemical properties of soil, and the community structure and activity of microorganisms were investigated. 【Result】 The soil total amino sugars, amino glucans, amino galactose, and cytosolic acids were significantly lower in P. densiflora than in R. pseudoacacia and Q. acutissima, Also, the bacterial, fungal, and microbial residue carbon was significantly lower in P. densiflora than in Q. acutissima and R. pseudoacacia, and the content of microbial residue carbon in R. pseudoacacia and Q. acutissima was 1.9 and 2.3 times higher than that in P. densiflora. The contribution of microbial residue carbon to SOC in R. pseudoacacia, Q. acutissima, and P. densiflora was 56.79%, 57.41%, and 52.55%, respectively. In addition, the content of fungal residue carbon was 12.76-16.56 times higher than that of bacterial residue carbon, and its contribution to organic carbon was much larger than that of bacterial residue carbon. Furthermore, it was observed that the content of total lignin phenol and its three types of monomers (V, S and C) followed R. pseudoacacia>Q. acutissima>P. densiflora with, the content of total lignin phenol in R. pseudoacacia and Q. acutissima being 3 and 2.8 times higher than that in P. densiflora. Also, the acid-aldehyde ratios of Vanillyl-based ((Ad/Al)v) and Syringyl-based ((Ad/Al)s) in the soil of R. pseudoacacia were significantly higher than those in Q. acutissima and P. densiflora, suggesting that the decomposition of soil lignin was higher in the R. pseudoacacia.Random forest model predictions showed that total nitrogen, organic carbon, total phosphorus, pH, and xylanase were the main factors affecting soil microbial, bacterial, fungal residue carbon and lignin phenols. Following the structural equation modeling, it was recorded that soil physicochemical and microbial properties are latent variables that have a strong influence on soil microbial residual carbon and lignin content, 【Conclusion】 Our results indicate that microbial growth can be promoted by improving soil nutrients and microbial properties. Eventually, increasing microbial and plant-derived organic carbon content and contribution to the SOC pool in temperate forest management can maximize its carbon sequestration potential.
-
The Influence of Mycorrhizal Types on the Soil Microbial Biomass Carbon and Its Distribution
MA Zhenyi, SUN Yichun, SHI Zhaoyong, GAO Jiakai, WEI Wenjing
2025,62(6):1839-1849, DOI: 10.11766/trxb202406120230
Abstract:
【Objective】 Soil microbial biomass carbon (SMBC) is an important indicator of microbial activity, and the type of mycorrhizal has a potential impact on SMBC content. The objective is to explore the impact of different mycorrhizal types on soil microbial biomass carbon and clarity their functions under global climate changes. 【Method】 Based on the SMBC database established by predecessors, the SMBC content and its distribution of plants of different mycorrhizal types were explored by dividing different soil layers (0-100 cm, 0-40 cm, 40-100 cm) and determining the mycorrhizal types of plants in the database. 【Result】 The results showed significant differences in SMBC between different layers of arbuscular mycorrhiza (AM) and ectomycorrhiza (ECM) plants, among which ECM plant soil SMBC was significantly higher than that of AM plant. There were also differences in the response of SMBC to soil parameters (soil depth, soil total nitrogen) and climate parameters (average annual temperature, average annual rainfall). At soil depth of 0-40 cm, the effects of factors (48.9%, 47.99%) on SMBC were significantly higher than that of climate factors under both AM and ECM plants (8.45%, 2.25%). Also, at soil depth of 40-100 cm, the SMBC of the ECM plant was more affected by climate factors (53.94%) than soil factors (25.32%), while the AM plant was affected differently, with the soil factor (45.17%) showing a more significant effect than climate factors (25.32%). 【Conclusion】 Under the influence of different types of mycorrhiza, SMBC was significantly positively correlated with soil organic carbon and total nitrogen (P<0.01), among which ECM was more affected by soil organic carbon and total nitrogen. The analysis of variance decomposition found that with the increase in soil depth, AM plant SMBC in deep soil was mainly affected by soil factors, while ECM plant SMBC was mainly affected by climate factors. In summary, the SMBC content of the ECM plant was significantly higher than that of the AM plant, and the response to organic carbon and soil total nitrogen was also higher than that of the AM plant.
-
Effect of Nitrogen and Phosohorus Addition After Straw Input on the Microbial Community Structure and the Accumulation of Necromass in Paddy Soil
LU Mengya, WANG Zhiquan, ZHANG Kun, DING Xueli
2025,62(6):1850-1861, DOI: 10.11766/trxb202406220253
Abstract:
【Objective】 Paddy soil has enormous potential for carbon sequestration and straw inputs in these soils strongly influence the microorganism-mediated turnover of soil organic carbon (SOC). This study aims to explore the microbial processes involved in the formation of SOC in response to straw inputs and to determine the regulatory effects of nitrogen and phosphorus on these microbial processes. 【Method】 A 300-day laboratory experiment was conducted to investigate the effects of straw (S) and straw combined with nitrogen and phosphorus nutrient additions (S+NP) on soil microbial communities and their necromass accumulation processes, in a subtropical red loam rice soil. Phospholipid fatty acids (PLFA) and amino sugars (AS) were used as microbial biomarkers to indicate living microbial biomass community and necromass, respectively. 【Result】 The results showed that compared to the control (CK) treatment, the S and S+NP treatments significantly increased the total soil PLFA content (P < 0.05) and the increase in fungal biomass (65.1%-130.1%) was greater than that of bacterial biomass (22.7%-34.3%). Fungal biomass was significantly higher in the S+NP treatment than that in the other treatments at the later incubation stage of 300 d, and the ratio of fungal/bacterial biomass (F/B) also significantly increased in straw plus high rate of nutrient supply (P < 0.05). Our results suggested that nitrogen and phosphorus application may affect soil microbial community structure over a longer time after straw amendment, which gradually shifted towards a fungal-dominated community structure with time. The accumulation of microbial necromass was significantly higher in both S and S+NP treatments than in the control throughout the incubation period (P < 0.05), and the dynamics of fungal necromass mirrored the total microbial necromass. However, bacterial necromass reduced remarkably at the end of the incubation and their content was significantly lower in the S+NP treatment than that in the S treatment (P < 0.05), suggesting its decomposition in the later stages of incubation. Further correlation analysis showed significant positive correlations between microbial biomass, microbial necromass and SOC (P < 0.05). This demonstrates the importance of microbial mediated mechanisms driving SOC formation and transformation in paddy fields following exogenous straw application. 【Conclusion】 In conclusion, the impact of straw return on soil organic carbon pool in paddy fields is closely related to microbial community structure and its mediation of necromass accumulation process, which may be regulated by extraneous nutrient supply. Furthermore, supplementation with moderate amounts of nitrogen and phosphorus nutrients can facilitate the accumulation of organic carbon fractions of microbial origin over longer time scales, especially the fungal necromass carbon. This will be of significant importance in regulating microbial-mediated organic carbon sequestration processes through on-farm nutrient management practices.
-
Changes of Community Diversity and Assembly Processes of Culturable Potassium-Solubilizing Bacteria in Soil Under Different Enrichment Strategies
ZENG Tao, BA Mengya, XIA Weiwei, ZHANG Yaohong, CAI Yuanfeng, CHEN Xiaofen, JIA Zhongjun
2025,62(6):1862-1876, DOI: 10.11766/trxb202406230255
Abstract:
【Objective】 Potassium-solubilizing bacteria (KSB) are considered key plant growth-promoting bacteria for the sustainable development of ecological agriculture due to their unique advantage of potassium solubilization. To fully explore the resources of potassium-solubilizing bacteria in the environment, the changes in the characteristics of soil potassium-solubilizing bacterial communities were investigated in this study under various enrichment strategies. 【Methods】 By using a potassium-solubilizing bacteria enrichment medium (KM), with a bacterial enrichment medium (BM) as a control, the study employed liquid (L) and solid (S) culture methods to continuously enrich and culture potassium-solubilizing bacteria in the test soil samples through three consecutive passages(1st, 2nd, and 3rd). The culturable microbial enrichments from each passage were collected, and high-throughput sequencing technology was used to analyze the 16S rRNA genes in the soil background and the enrichments. This analysis aimed to evaluate the proportion of culturable bacteria or potassium-solubilizing bacteria in the soil background bacterial community, as well as the community composition and diversity patterns under different enrichment strategies. 【Results】 The results indicated that the bacterial diversity enriched by both media BM and KM was significantly lower than that in the background soil and the bacterial diversity in KM enrichments was significantly higher than that in BM enrichments. A total of 17 phyla, 38 classes, 91 orders, 145 families, and 267 genera of bacteria were detected in both L-KM and S-KM enrichments, with the most significant proportion at the phylum level accounting for approximately 29.31% of the soil background bacteria. The number of bacterial taxa enriched with L-KM medium was higher than S-KM at all levels. At the phylum level, the dominant phyla in L-KM were Firmicutes and Proteobacteria while in S-KM, the dominant phyla were Actinobacteriota and Proteobacteria. At the genus level, groups with distinct physiological and metabolic characteristics were enriched through three consecutive passages. Among them, the dominant genera in L-KM were Aminobacter, Chelatococcus, Cupriavidus, Hydrogenophilus, Microvirga, Paenibacillus, and Phenylobacterium. The only genus in S-KM that overlapped with L-KM was Cupriavidus, while other dominant genera included Burkholderia, Luteibacter, Massilia, Pseudomonas, and Ralstonia. Compared with known potassium-solubilizing bacteria databases, only 50 known genera were enriched in the KM medium, while unknown potassium-solubilizing bacteria accounted for over 81%. Using null model inversions to analyze the bacterial community assembly process during continuous passaging enrichment under different media, it was found that deterministic processes dominated the changes in community structure from the soil suspension inoculation to the first-generation media, while stochastic processes, mainly genetic drift, governed the intergenerational bacterial community succession. 【Conclusion】 These results indicate that the composition and form of the medium are the main factors influencing the culturable potassium-solubilizing bacterial community, but continuous passaging enrichment does not lead to homogenization and simplification of the community structure. A relatively large number of both known and unknown potassium-solubilizing bacterial genera can be obtained under different enrichment strategies and used to enrich the existing resource bank of potassium-solubilizing bacteria. This can provide valuable insights for further development and utilization of these bacteria.
-
Extraction of Biofilms and Mineral Response Characteristics of Interspecific Interaction in Acidic Purple Paddy
YAN Guili, WEN Yi, ZHAO Sheng, XIONG Xuan, LIU Shanpeng, JIANG Yu, TANG Yuqing, OUYANG Kai
2025,62(6):1877-1887, DOI: 10.11766/trxb202406210252
Abstract:
【Objective】 Soil minerals, as the main carrier of biofilms, regulate the formation of multi-species biofilms in soil and profoundly affect the types of bacterial interactions within the biofilm. 【Method】 To further reveal the interaction mechanism between soil active components and multi-species biofilms, this study selected common minerals such as kaolinite, montmorillonite, and goethite in soil, as well as strains extracted from paddy soil, as research objects. Single strains were paired and co-cultured with soil minerals. In situ monitoring was carried out using confocal laser scanning microscopy (CLSM) combined with the crystal violet staining method, to explore the formation of multi-species biofilms and the response of bacterial species interactions within biofilms to soil minerals. 【Result】 Compared with the pure bacterial system, both kaolinite and montmorillonite treatments significantly inhibited the formation of multi-species biofilms, and the S-1+S-14 combination in the kaolinite treatment system was most inhibited, with a decrease of 42.57% in biofilm biomass. The addition of kaolinite changed the interaction between the S-1+S-2 strain combination from synergistic to neutral and adjusted the S-1+S-8 combination from neutral to antagonistic. However, montmorillonite alleviated the antagonistic interaction between the S-1+S-14 and S-1+S-15 strains, and their interaction relationship shifted to neutrality. The treatment of goethite significantly promoted the formation of multi-species biofilms in the four groups, with the S-1+S-14 combination showing the greatest increase in biofilm biomass (46.45%). Also, the addition of goethite significantly enhanced the synergistic effect of the S-1+S-2 mixed microbial community, causing the interaction between microbial communities in the S-1+S-8 and S-1+S-14 combinations to shift from neutral and antagonistic to synergistic, and adjusting the S-1+S-15 combination from antagonistic to neutral. 【Conclusion】 This study clarifies the effects of different types of soil minerals on the formation of multi-species biofilms and reveals the potential mechanisms for the transformation of interactions between microbial communities within biofilms. The results of this study can provide theoretical guidance for a deeper understanding of the microbial effects of soil components and soil biological processes, as well as further exploration of soil biological resources.
-
Effects of Constructing Mixed Forests on Extracellular Enzyme Activities and Stoichiometry in Soil After Clear-cutting of Eucalyptus grandis
WAN Renping, TANG Jiandong, HE Bo, Fan Ji, ZHAO Zhi, LIANG Zhengchuan, ZOU Xingcheng, HU Junxi, ZHOU Shixing, HUANG Congde
2025,62(6):1888-1901, DOI: 10.11766/trxb202410170399
Abstract:
【Objective】 Extracellular enzymes in soil play a crucial role in mediating the ecosystem's responses to environmental drivers, and their stoichiometry can be used to assess the resource limitation for microorganisms. The conversion from pure forest plantations to mixed forest plantations is an important approach to achieve sustainable forest development. The current study on ecosystem responses to forest conversion has predominantly concentrated on soil nutrients, carbon (C) sequestration capacities, timber productivity metrics, and silvicultural landscape attributes. However, the effects of this conversion on extracellular enzymes and their stoichiometric characteristics in soil remain poorly understood. 【Method】 Here, the 5-year-old mixed forests of Prunus persica ‘Atropurpurea’ + Malus × micromalus, Cunninghamia lanceolata + Phoebe zhennan + P. persica ‘Atropurpurea’ and Cinnamomum camphora + Metasequoia glyptostroboides as well as pure forest plantation soil of E. grandis were investigated. All forest plantations were recently constructed after clear-cutting the E. grandis plantations. It was determined the effect of mixed forests on soil physical and chemical properties, microbial biomass, extracellular enzymes, and their stoichiometric characteristics. Moreover, the correlation between soil extracellular enzymes and stoichiometry with various soil properties was analyzed, and the main controlling factors affecting the extracellular enzymes and stoichiometry in soil were explored. 【Result】 The results showed that: (1) The three mixed forests increased β-1, 4-N-acetylglucosaminidase and l-leucine aminopeptidase activities, but decreased that of β-1, 4-glucosidase and acid phosphatase activities in soil. (2) The vector length of extracellular enzymes ranged from 0.68 to 0.88, while the vector angle ranged from 72.59° to 81.18°, indicating that microorganisms were co-limited by C and phosphorus (P) in all the forest plantation soils. (3) The three mixed forest plantations reduce microbial C and P limitations by increasing organic C, total nitrogen (N) content, pH, microbial biomass C: N ratio in soil, and C: P and N: P ratios in soil. However, the microorganisms were still co-limited by C and P. Therefore, in the early stage of mixed forest plantation construction, organic and P fertilizer can be applied to reduce resource limitations of soil microorganisms in the study area. (4) Total N and microbial biomass N were the key controlling factors influencing extracellular enzyme activity and enzyme stoichiometry in all the forest plantation soils. 【Conclusion】 Collectively, these findings suggest that the conversion of pure forest plantations to mixed forest plantations alleviates the microbial C and P limitations in soil. Notably, extracellular enzymes and their stoichiometric characteristics in soil are influenced by interactions among vegetation, soil properties, and forest microclimate factors. Thus, future studies should prioritize analyzing how mixed forest plantations affect these parameters through plant diversity assessments (e.g., tree and understory vegetation), and understory microclimate monitoring.
-
A Programming Idea for Solving One-dimensional Unsaturated Infiltration Equation by Finite Element Method
ZHANG Qingqing, LI Xiang, WANG Zhongfu
2025,62(6):1902-1909, DOI: 10.11766/trxb202412010459
Abstract:
Some Key Research Fields of Chinese Soil Physics in the New Era: Progresses and Perspectives pointed out that one of the reasons for the lack of original research on soil physics in China is that Chinese scholars engaged in soil physics research lack a strong mathematical foundation. This makes it difficult to achieve breakthroughs in the numerical simulation of soil physical processes. The key equation for numerical simulation of soil physical processes is the Richards equation. Although there are many papers on solving the Richards equation using the finite element method, most are highly theoretical and lack practicality, posing significant challenges for researchers with limited mathematical and physical backgrounds in understanding and programming implementation. Therefore, this paper aims to present a programming framework incorporating detailed derivation steps for solving the one-dimensional Richards equation using the finite element method. The weak form of the Richards equation was derived by establishing the weighted residual equation. Subsequently, the weak form equation was transformed into a nonlinear algebraic equation by employing Jacobian transformation and Gaussian numerical integration. Finally, the nonlinear algebraic equation was solved using the Newton-Raphson method with boundary condition substitution. The corresponding code developed based on this programming framework demonstrated simulation results validated by experimental data from soil infiltration tests. The programming framework and code provided in this paper enable researchers with limited mathematical and physical backgrounds to efficiently implement numerical simulation of the one-dimensional Richards equation using the finite element method. This effort aims to facilitate potential breakthroughs in numerical modeling of soil physical processes in China, thereby contributing positively to future advancements in this field.
Reviews and Comments
Research Articles
Communications and Comments
-
Research Progress on Soil Particulate versus Mineral-Associated Organic Carbon dynamics Mediated by Microorganisms
LIU Lei, ZHANG Yunlong, ZHANG Junling, WANG Ling, SUN Shiyou
DOI: 10.11766/trxb202505260240
Abstract:
The turnover and stabilization of soil organic carbon (SOC) play a crucial role in the terrestrial carbon cycle, contributing approximately 25% to natural climate solutions. Particulate organic carbon (POC) and mineral-associated organic carbon (MAOC) are pivotal in the soil carbon dynamics. Soil microorganisms are the primary drivers of the carbon cycle, by decomposing plant residues to form POC via the “ex vivo modification” pathway and accumulating microbial residual carbon via “in vivo turnover” pathway, which then combines with soil minerals to form MAOC. However, the role of microorganisms in POC and MAOC formation is constrained by multiple factors, including nutrient management practices, soil properties, and climatic conditions, which limit the microbial regulation of carbon sequestration in agricultural soils. This article systematically introduced the framework of POC and MAOC. The contributions of growth anabolism (living and residual microorganisms) and non-growth anabolism (enzymes and extracellular polymers) to POC and MAOC were described. This study elucidated the regulatory mechanisms governing POC and MAOC through microbial community structure and physiological functions, whilst analyzing the influencing factors. On this basis, the study systematically considered the mechanisms and approaches by which microorganisms regulate and increase SOC, providing an important basis for constructing a theory of SOC increase based on physical-biological synergistic regulation.
-
Green Intelligent Fertilizers: Innovative Approaches to Intelligent Regulation and Industrialization Pathways
ZHANG Fusuo, CHENG Lingyun, HUANG Chengdong, ZHANG Lin, WANG Jianchao, LYU Yang, LU Zhenya, WEI Changzhou, MA Wenqi, Ma Hang, SHEN Jianbo
DOI: 10.11766/trxb202508230411
Abstract:
As global agriculture evolves alongside the increasing demand for environmental protection, green intelligent fertilizers have emerged as a novel approach to enhancing crop productivity and resource use efficiency. This paper reviews the core concepts and development status of green intelligent fertilizers, exploring the principles of intelligent regulation within plant-microbe-environment interactions and the design and application strategies based on the rhizobiont theory. Green intelligent fertilizers operate by maximizing the biological potential of crops and microorganisms to regulate the integrated plant-microbe-soil system, thereby promoting plant growth and minimizing environmental impact. Looking ahead, breakthroughs in material innovation, process optimization, and intelligent fertilizer formulation will enable intelligent fertilizers to drive agricultural green transformation, providing critical support for global food security and environmental sustainability.
-
Effects of elevated CO2 concentration on phosphorus uptake and distribution in rice for multiple generations*
guxinyue, caichuang, yinbin, zhuchunwu
DOI: 10.11766/trxb202502280084
Abstract:
Abstract:[Objective] With the intensification of human activities since the Industrial Revolution, there is a continuous rise in carbon dioxide concentration ([CO2]) in the atmosphere, which has become the main feature of global climate change. Rice being an important staple crop, it is important to explore its absorption and distribution of phosphorus under a long-term elevated CO2 environment. [method] In this study, a multigenerational experiment was carried out cultivating Yangdao 6 (indica) and Wuyungeng 23 (japonica) in the Free Atmospheric CO2 Enrichment System (FACE) in Changshu, Jiangsu Province. The experiment was carried out under ambient [CO2] and elevated [CO2] (increased by 200 μmol?mol-1) conditions for seven generations, and the differences in phosphorus concentration, phosphorus uptake, and phosphorus distribution ratio between the single-generation and multigenerational rice plants were evaluated. [Result] (1) Long-term elevated [CO2] had no significant effect on the phosphorus concentration of multigenerational rice plants in Yangdao 6 and Wuyungeng 23. (2) The long-term elevated [CO2] significantly increased the phosphorus uptake of shoots in single-generation and multigenerational rice plants. However, the average increase in phosphorus uptake of the shoot and panicle of the offspring plant of Yangdao 6 was lower than that of the single-generation plant. On the contrary, the average increase in phosphorus uptake of shoot, straw, and panicle of the offspring plant of Wuyungeng 23 was higher than that of the single-generation plant under elevated [CO2]. (3) The average increasing effect of elevated [CO2] on the distribution ratio of phosphorus in the straw of Wuyungeng 23 increased significantly with the increase in generations of maternal seeds under elevated [CO2] treatment. [Conclusion] The results indicate that in the past, based on the single-generation short-term FACE studies, the real effect of long-term elevated [CO2] on phosphorus uptake and distribution in rice plants could not be accurately predicted in the future. Therefore, this study provides guidelines for field-level phosphorus fertilizer management in a future high-CO2 world.
-
The Impact of anoxic Microsites on Soil Respiration and Their Distribution Characteristics in Soil Aggregates
zhang xu sheng, wang xia, zhao yun fei, yuan meng han, wang fei, xia jie yi, li liu jun
DOI: 10.11766/trxb202501050008
Abstract:
Anoxic microsites are potential significant contributors to the inhibition of soil organic carbon loss. Soil aggregates, as potential suitable sites for the development of anoxic microsites, are closely related to the accumulation of soil organic carbon. However, few studies have investigated the impact of anoxic microsites on organic carbon within soil aggregates. This study collected dryland soils from four types of vegetation restoration and employed soil incubation and gas chromatography to measure and calculate the extent of anoxic protection. Anaerobic conditions were used to obtain soil samples from the internal and external layers of macroaggregates through the dry dissection method, and their anoxic microsite abundance and organic matter composition were compared. The results indicate that the extent of anoxic protection was 33.5% and 36% of natural shrubland and natural grassland, respectively. Planted forest exhibited a lower protection value at 15.9%, while farmland exhibited the most negligible anoxic protection at ?8.9%. And the internal layer of macroaggregates generally exhibits a high concentration of Fe2+, consequently, this region is characterized by a greater prevalence of hypoxic microenvironments. Organic matter, such as aromatics, lipids, and lignin, protected by anoxic microsites, is relatively abundant in the inner layer of aggregates. Soil respiration rate was significantly negatively correlated with the extent of anoxic protection. The aforementioned results reveal the formation mechanism, stability, and protective role of anoxic microsites within the inner layers of soil aggregates towards organic matter. The extent of anoxic protection is contingent upon a stable soil environment. These microsites selectively conserve the reducing organic matter within macroaggregates, significantly reducing the loss of soil organic carbon. This finding contributes a nuanced understanding of soil carbon cycling and carbon sequestration processes.
-
Characteristics and Mechanism of Polystyrene Microplastic Uptake and Transport in Maize Seeds and Seedlings
YANG Changlang, HUI Yayun, LI Wenshan, WANG Pengyang, ZHAO Zeying, Xiong Youcai
DOI: 10.11766/trxb202508150399
Abstract:
【Objective】This study aimed to investigate the absorption and transport characteristics and mechanism of microplastics of different concentrations and particle sizes in maize seeds and seedlings.【Method】Maize was used as the test material and fluorescent-labelled polystyrene microplastics (PS-MPs) microspheres were added to the seeds during germination and to the seedlings during hydroponic exposure. This platform quantified growth-suppressive impacts of the test compound on germinative capacity and early seedling establishment, and clarified its mechanism of action.【Result】The effects of microplastics on the germination of maize seeds and the growth of seedlings exhibited significant dependence on concentration and particle size. At the seed germination stage, when examined using laser confocal electron microscopy, it was found that PS-MPs fluorescent microspheres were enriched at the position of the root hairs on the embryonic root. Furthermore, some of the microspheres penetrated the root epidermis and entered the cortical tissue, ultimately reaching the xylem vessels that are responsible for transporting water and nutrients. Their presence in these critical conductive tissues disrupted the seed germination process and induced oxidative damage. This experiment demonstrated that low concentrations (20 mg·L-1) of fluorescent PS-MPs promoted germination, whereas medium-to-high concentrations (50 and 100 mg·L-1) inhibited it.【Conclusion】This study verified the internalization and shootward translocation of microplastics in maize plants and provided preliminary insights into the absorption and translocation characteristics of microplastics within maize plants. It also sheded light on the toxic mechanisms of microplastics on maize, providing a vital experimental basis for understanding the migration and transformation patterns of microplastics within plants, thus providing scientific evidence with which to assess the impact of microplastics on agricultural ecosystems and food safety.
-
Soil Health Evaluation of Farmland in Arid Areas Based on Minimum Data Set
JING Yili, HUANG Bin, SU Xinyue, WU Lei, LI Jianhua, XU Minggang
DOI: 10.11766/trxb202509010431
Abstract:
【Objective】 Soil health assessment is a critical technical approach for achieving sustainable farmland management. However, existing evaluation systems often suffer from limitations such as indicator redundancy and high operational costs, which hinder their widespread application. This study aims to construct a cost-effective and efficient minimum data set (MDS) for soil health evaluation in the semi-arid farmland regions of the Loess Plateau, and to scientifically validate its reliability and applicability under local ecological conditions. 【Method】A total of 100 soil samples were collected from dryland farmlands in Wuzhai County, Shanxi Province, a representative area of the Loess Plateau. A comprehensive set of 23 soil indicators covering physicochemical and biological properties was analyzed. The MDS was established through an integrated statistical procedure that combined the principal component analysis (PCA), norm value calculation, and Pearson correlation analysis to identify the most representative and non-redundant indicators. The soil health index (SHI) was subsequently calculated using both linear and nonlinear scoring functions based on the MDS and the total data set (TDS). The performance of the MDS was evaluated by comparing SHI values derived from both data sets and further validated through correlation analysis with crop yield data. 【Result】The MDS was successfully established and included six key indicators: soil bulk density, total nitrogen, urease, cellobiohydrolase, bacterial Shannon index, and fungal Shannon index. These indicators accounted for 82.47% of the total variance explained by the TDS. Notably, biological indicators constituted two-thirds of the MDS, underscoring the vital role of microbial processes in soil health within arid regions. The SHI values calculated using the MDS showed a strong and significant positive correlation with those from the TDS under both nonlinear and linear scoring functions (P < 0.001), confirming the MDS’s capability to effectively represent the full data set. Validation with crop yield data further demonstrated that the nonlinear scoring function applied to the MDS provided a better fit (r = 0.70) than the linear function (r = 0.64), indicating its superior suitability for soil health assessment in the regions. The average SHI across the studied area was 0.49, reflecting a moderate overall soil health status. Spatially, soil health exhibited a pattern of lower values in the north and higher values in the south, largely influenced by the high erodibility of loess soils and more pronounced aridity in the northern part. 【Conclusion】This study developed a simplified yet robust MDS for soil health evaluation in semi-arid farmland systems of the Loess Plateau, effectively balancing comprehensiveness and feasibility. The results highlight the essential role of microbial diversity and functional indicators, such as enzyme activities and bacterial/fungal diversity, in evaluating soil health under dryland conditions. The spatial variation in soil health calls for region-specific management strategies, particularly in northern areas where soil erosion and moisture limitation are more severe. It is recommended that future research place greater emphasis on incorporating microbial functional parameters into soil health assessment frameworks. Moreover, integrating emerging technologies such as soil sensing and molecular tools could further enhance the efficiency and predictive power of soil health monitoring in arid and semi-arid agricultural landscapes.
-
Recent Advances in the Impact of Microplastics on the Function of Agricultural Soil Ecosystems
XU Yongfeng, TENG Ying, TENG Ying, HU Wenbo, LI Yanning, LU Wancheng, LUO Yongming
DOI: 10.11766/trxb202509170457
Abstract:
Microplastics have emerged as a widespread pollutant in agricultural soils, entering primarily through plastic film mulching, sewage irrigation, and the application of organic fertilizers. Their continuous accumulation poses a growing threat to soil ecosystem health and functionality. Therefore, a deep understanding of the impact process and mechanism of microplastics on the functioning of agricultural soil ecosystems is of great scientific significance and practical value for scientifically assessing their ecological and environmental risks, developing pollution control and remediation strategies. This review systematically examines the migration and transformation behavior of microplastics in agricultural soil and analyzes their diverse ecological effects, including alterations to soil physicochemical properties, shifts in microbial communities, impacts on soil fauna, and influence on crop growth. It also synthesizes current knowledge regarding the broader implications of microplastics on soil nutrient cycling, greenhouse gas emissions, crop productivity, and overall soil health. On this basis, key scientific questions are identified in areas such as the complex environmental behavior mechanisms of microplastics in real environments, inter-trophic interactive effects, and the systematic assessment of ecological risks and soil health. Finally, future research priorities and directions are proposed to provide a theoretical foundation for risk prevention and green remediation of microplastic pollution in agricultural soils.
-
Precision and Economic Analysis of Determining Different Forms of Soil Iron Contents Using Spectroscopic Techniques
TANG Yun, GAO Weichang, PAN Wenjie, CAI Kai, ZENG Yuntao, YANG Jing, JIANG Chaoying, ZHENG Gaunghui, LI Decheng, ZENG Rong
DOI: 10.11766/trxb202503280144
Abstract:
【Objective】Iron (Fe) is an essential micronutrient for plant growth. Accurate monitoring of different forms of iron (Total Fe, Available Fe, Free Fe) is essential for soil health management and agricultural production optimization. Total iron and free iron are also necessary indicators to identify certain soil types. Compared with traditional soil determination methods, spectral technology is rapid, cost-effective, and environmentally friendly, and is gradually becoming an alternative for soil Fe determination in recent years. However, there are few reports on the systematic inversion of different forms of iron by spectral technology.【Method】Based on the color parameter (CP), visible near infrared (VNIR), mid infrared (MIR) , and fusion spectrum (SF) were used to obtain data of 501 typical farmland tillage layer (0~20cm) soil samples in Guizhou Province. The spectrum was smoothed by Savitzky-Golay (SG) denoising, and then the baseline was corrected by the standard normalization (SNV) method. Partial least squares regression (PLSR) and support vector machine (SVM) were used for modeling, respectively. The system compared the predictive performance of single spectra and fused spectra for the three types of iron fractions. Moreover, the relationship between accuracy and cost of different prediction strategies was quantified using two indicators: Cost-Efficiency Ratio (CER) and Efficiency Index (EI).【Result】The results show that: (1) in the single spectral model, VNIR spectrum performed best in the prediction of total iron (determination coefficient R2 = 0.85, relative analysis deviation RPD = 2.59, root mean square error RMSE = 5.48 g·kg-1), while MIR spectrum had the highest accuracy in the prediction of free iron (R2 = 0.80, RPD = 2.23, RMSE = 4.15 g·kg-1). Also, the decision level fusion (SF3) spectrum further improved the prediction accuracy of the three forms of iron, among which the effective iron increased the most, but it was still difficult to achieve effective prediction (RPD = 1.37). Thus, using spectral technology to predict soil available iron is not recommended. (2) The cost accuracy analysis showed that the spectral technology can significantly reduce the cost (by 40%~85%) of soil iron characterization. VNIR and MIR technologies had high accuracy and were cost-effective in the prediction of total iron and free iron, and were suitable for scenarios requiring comprehensive consideration of accuracy and cost. However, the accuracy improvement of fused spectrum (SF) was limited, and the cost increased more, which is suitable for scenarios requiring higher accuracy. 【Conclusion】This study shows that spectral technology can significantly reduce the cost of soil iron content measurement on the basis of ensuring a certain prediction accuracy, and can replace the traditional methods to achieve efficient monitoring of total iron and free iron, so as to provide effective technical support for the implementation of precision agriculture.
-
Occurrence Characteristics and Risk Assessment of Microplastics in the Soil-groundwater System of Non-standard Landfill
DU Yuntian, TANG Simeng, DING Ling, SHAN Xiaoling, QIU Xinran, ZHANG Bin, LIANG Xujun, GUO Xuetao
DOI: 10.11766/trxb202504300202
Abstract:
【Objective】 A large amount of plastic waste is produced globally every year, and landfill is the most common way to deal with plastic waste. However, plastic waste that enters landfills will continuously generate microplastics under the influence of physical, chemical, and biological factors, thereby affecting the surrounding ecological environment and human health.【Method】 In this study, the occurrence characteristics of microplastics in the soil-groundwater system of a landfill in Taizhou, Zhejiang Province, were investigated, and the ecological risk of microplastics in this area was assessed by pollution load index (PLI), polymer risk index (H), and potential ecological risk index (PERI). 【Result】 The results showed that the abundance of microplastics was 28313±7687 microplastics/kg, 7789±585 microplastics/L, 25660±2614 microplastics/kg, 183±41 microplastics/L in landfill, leachate, soil, and groundwater, respectively. The microplastics were mainly thin film and of a small size (0-50 μm). Also, the polymer composition was mainly polyethylene (PE) and polypropylene (PP). In addition, the microplastic ecological risks of the landfill""s waste, soil, leachate, and groundwater were respectively at extremely high risk, high risk, high risk, and medium risk. 【Conclusion】 Landfill sites, as an important source of microplastics, have potential impacts on the surrounding environment. This study can provide theoretical support for the assessment and control of microplastic pollution in the soil-groundwater system of landfill sites.
-
The Growth and Metabolic Response Mechanism of Tobacco under Polystyrene Nanoplastics Stress
TAN Miaomiao, SUN Xiaodong, WANG Yue, XING Rongxiang, MENG Ge, YUAN Xianzheng
DOI: 10.11766/trxb202507310366
Abstract:
【Objective】Micro- and nanoplastics have emerged as pervasive contaminants in terrestrial ecosystems. However, current research remains disproportionately focused on aquatic environments and food crops, leaving a significant knowledge gap regarding their effects on economically important non-food cash crops like tobacco, which possess high economic value and complex secondary metabolic pathways. This study systematically investigates the physiological and metabolic responses of Nicotiana benthamiana to root exposure of polystyrene nanoplastics (PS-NPs), with a particular focus on organ-specific adaptations in carbon and nitrogen metabolism under stress. Understanding these mechanisms is critical for ecological risk assessment and for safeguarding the productivity and quality in non-food cash crop systems, which have been largely neglected in the current nanoplastic research paradigm. 【Method】We employed a dual experimental approach integrating both pot cultivation and hydroponic systems to comprehensively evaluate PS-NPs effects on N. benthamiana seedlings. This integrated design enabled us to distinguish direct particle-plant interactions under controlled hydroponic conditions from more complex soil-mediated effects in pot environments. We employed metabolomics analysis coupled with detailed physiological analyses, including oxidative stress markers, antioxidant enzyme activities, and biomass measurements, to unravel the metabolic and defense networks activated under PS-NPs stress. 【Result】Pot experiments revealed a clear dose-dependent inhibition of plant growth, with PS-NPs concentrations of 150, 500, and 800 mg·kg-1 reducing plant height by 18.80%, 29.42%, and 30.67%, respectively. Hydroponic exposure induced even more striking morphological alterations, characterized by significant shoot suppression accompanied by a remarkable 43.52% and 47.20% increase in root elongation at 50 and 150 μg·mL-1. Paradoxically, the shoot fresh weight increased while dry weight accumulation was markedly reduced, indicating fundamental disruptions in carbon partitioning and structural biomass synthesis. Physiological analyses demonstrated severe oxidative stress in N. benthamiana roots, evidenced by elevated hydrogen peroxide and malondialdehyde levels alongside significantly enhanced superoxide dismutase activity, indicating activation of the antioxidant defense system. Metabolomic profiling identified extensive perturbations across multiple pathways, particularly in amino acid metabolism, carbohydrate dynamics, and organic acid transformation. It indicated that PS-NPs exposure disrupted central carbon metabolism, including carbon metabolism, galactose metabolism, and energy production pathways through glycolysis and oxidative phosphorylation. Moreover, N. benthamiana roots exhibited substantial downregulation of critical TCA cycle intermediates, including citrate and α-ketoglutarate, coupled with reduced glycolytic intermediates such as glucose-6-phosphate and fructose-6-phosphate, while simultaneously accumulating compatible solutes like isoleucine and valine. This result indicates strategic reallocation of nitrogen resources toward osmotic protection and fundamental defense mechanisms. Conversely, N. benthamiana leaves implemented an efficient carbon sequestration strategy, accumulating hexose phosphates and soluble sugars, and upregulating the biosynthesis of specialized defensive compounds, including flavonoid secondary metabolites and non-protein amino acids, demonstrating organ-specific metabolic specialization. Importantly, nitrogen metabolism of N. benthamiana leaves also shifted toward active defense and signal transduction. The pronounced upregulation of 4-aminobutyric acid (GABA) and its derivative 2,4-diaminobutyric acid marked the activation of the GABA pathway, a pivotal stress-response pathway. This pathway plays a crucial role in the reconstruction of carbon and nitrogen balance, and also assumes core functions in mitigating oxidative stress and regulating signal transduction within the N. benthamiana defense network. 【Conclusion】 This study demonstrates that PS-NPs root exposure initiates a complex adaptive response in N. benthamiana seedlings, characterized by inhibited shoot growth and dry matter accumulation, and stimulated root elongation as a stress-avoidance mechanism. PS-NPs root exposure also induced oxidative damage and triggered the comprehensive reorganization of metabolic networks. The research reveals an organ-specific defense strategy wherein roots prioritize immediate survival through osmotic adjustment and basic defense, while the leaves activate advanced chemical defense pathways, coordinated in part through GABA-mediated signaling. This study provides novel mechanistic insights into the metabolic adaptation of plants under nanoplastic stress and offers an important scientific basis for assessing the potential ecological risks of micro- and nanoplastics in terrestrial environments.
-
Advances in Understanding the Interaction Between Soil Iron Oxides and Organic Carbon and its Effect on Carbon Stabilization
TIAN Yihui, XU Yun, HOU Jingtao, HUANG Chuanqin, TAN Wenfeng
DOI: 10.11766/trxb202502020044
Abstract:
Soil serves as a crucial terrestrial reservoir of organic carbon, plays a significant role in mitigating climate change and ensures sustainable agricultural production. Iron oxides, as important active components in soil, are integral to the stabilization and turnover of soil organic carbon. These oxides interact with organic carbon through processes such as adsorption, co-precipitation, and other mechanisms, forming relatively stable iron-carbon complexes. Additionally, iron acts as a catalyst in the polymerization of organic carbon, facilitating the transformation of organic carbon into more stable forms via the Maillard reaction. However, these protective functions of iron oxides can be modulated by environmental factors, which may reduce their effectiveness under fluctuating conditions. During redox cycling of iron, iron oxides can also accelerate the organic carbon turnover by releasing reactive oxygen species and transferring electrons. This review provides a systematic examination of the mechanisms by which soil iron oxides influence carbon turnover and sequestration, while also exploring the reciprocal effects of organic carbon on iron cycling. This study further evaluates the role of environmental factors and key biological processes in regulating iron-carbon cycling. Particular emphasis is placed on the critical roles of mineral protection and biological activity constraints in maintaining soil carbon pool stability. Finally, the review proposes several directions for future research in the iron-carbon field. These include the verification and quantification of soil organic carbon polymerization reactions, understanding the regulatory role of soil microzone biological processes on iron-carbon coupling, exploring the trade-offs between organic carbon fixation and morphological transformation during iron redox processes, and integrating a cross-scale model for iron-carbon coupling and carbon sink potential assessment. Conducting these studies will facilitate the accurate analysis of physical-chemical-biological mechanisms of soil iron-carbon coupling and furnish insights to promote a more profound understanding of iron-carbon dynamics and formulate strategies for enhancing soil carbon sequestration.
-
Distribution of Photosynthetic Carbon in Corn-soil System and Its Effect on Maize Biomass under Biological Fertilization
GONG Yong-qi, FAN Cong-cong, YIN Chang, ZHU Guo-fan, ZHAO Li-xia, SHEN Ren-fang, WANG Xiao-yue, JIANG Yu-ji
DOI: 10.11766/trxb202503060105
Abstract:
【Objective】To investigate the effects of different biological fertilization practices on photosynthetic carbon (C) allocation and maize biomass, a field experiment was conducted at the Red Soil Ecological Experimental Station of the Chinese Academy of Sciences. 【Method】Four treatments were selected from a long-term biological fertilization trial: ① Chemical fertilizer + Organic manure (FO), ② Chemical fertilizer + Organic manure + Microbial inoculant (FOP), ③ Chemical fertilizer + Organic manure + Nematode inoculation (FON), and ④ Chemical fertilizer + Organic manure + Microbial inoculant + Nematode inoculation (FOPN). After soil samples were collected from the four treatments, a pot experiment using 13CO? pulse labeling was performed to study the allocation of photosynthetically fixed carbon within the maize-soil system. 【Result】The 13C pulse labeling results showed that, compared with the FO treatment, the FOPN treatment significantly increased the total amount of photosynthetic carbon in both aboveground and belowground parts, with a more pronounced increase in the aboveground portion. This led to a reduced belowground-to-aboveground allocation ratio of photosynthetic carbon. Moreover, the trends of maize biomass in aboveground and belowground parts under different treatments were consistent with the trends in carbon allocation. All biofertilization treatments significantly increased total and available soil nutrients, the total abundance of nematodes, and altered nematode community composition, with the most pronounced effects observed under the FOPN treatment. Random forest analysis and structural equation modeling jointly revealed that biofertilization enhances nutrient availability and increases aboveground photosynthetic carbon allocation by elevating nematode abundance and shifting community composition, ultimately promoting maize aboveground biomass.【Conclusion】 This study clarifies the mechanism by which nematode predation influences maize productivity and provides important theoretical guidance for biological fertilization technologies in red soil ecosystems.
-
Plant–soil feedback driven mechanisms and regulation strategies for soil health
Wang Guangzhou, Shen Jianbo, Zhang Junling, Zhang Fusuo
DOI: 10.11766/trxb202506290314
Abstract:
A healthy soil is the foundation for ensuring food security and serves as a core pillar for achieving agricultural green development. However, current intensive agricultural systems are primarily focused on maximizing crop yields, relying heavily on high-yielding crop varieties and external inputs such as synthetic fertilizers and pesticides. This overreliance often overlooks the impact of crops and field management practices on soil health, leading to various forms of soil degradation that negatively affect crop productivity and food quality. Drawing on the ecological concept of plant-soil feedback (PSF), this paper proposes a new systematic research paradigm that places soil health as the key to the co-improvement of farmland quality and crop productivity. Future sustainable agriculture urgently requires the development of system-based strategies and solutions grounded in PSF theory, integrating aboveground crop management with belowground soil processes in a tightly coupled manner. By elucidating the reciprocal interactions among different components of the soil ecosystem, we can develop soil health management technologies based on positive plant-soil feedback, thereby enhancing the synergy between productivity and other soil multifunctionalities. Specifically, at the individual plant level, modern molecular breeding and functional genomics can be leveraged to modify root architecture, root exudate composition, and signal transduction properties in a targeted way. This enables the precise recruitment of beneficial microbes and suppression of pathogens, triggering cascade amplification effects that reinforce positive feedback loops and mitigate negative ones. At the field management level, integrated strategies such as crop-microbiome holobiont breeding, optimized nutrient management, conservation tillage, and diversified cropping systems can promote beneficial interactions between crops and soils. These approaches reduce dependence on external inputs, improve internal system efficiency, and ultimately achieve the co-enhancement of crop yield and soil health.
-
Research Progress on Occurrence Patterns, Source Apportionment, and Environmental Risk Assessment for Microplastics in Soil
zhao yue, zou li, jiang xiaoxu, guo manlin, wu chao, sang yinqing, luo haijiang
DOI: 10.11766/trxb202507070332
Abstract:
Plastic waste degradation in the environment generates microplastics (<5 mm), posing potential risks to soil physicochemical properties, terrestrial ecosystems, and human health. However, current research on the occurrence patterns, source apportionment methods, and environmental risk assessment of soil microplastics remains limited. To support soil microplastic pollution management and remediation, this review synthesizes the occurrence patterns of microplastics from various perspectives including abundance, polymer types, particle size, color and shape. Source apportionment methods, including pollution characteristic analysis, emission inventory, multivariate statistical modeling, and co-pollutant assisted identification are systematically introduced. Furthermore, this review evaluates the advantages and limitations of various risk assessment frameworks for soil microplastics, identifies the main challenges therein, and proposes future research directions. Firstly, there is need to accelerate the establishment of standardized analytical protocols for soil microplastics to provide multidimensional and accurate information for source identification and risk assessment; Secondly, strengthening fundamental research on source apportionment and establishing a robust source information database for soil microplastics is paramount; Thirdly, enhancing the research on risk assessment methods by developing a comprehensive toxicological database, quantifying the synergistic effects of composite pollution and clarifying the influence of factors on environmental risks, such as particle size, shape, color, and aging degree is necessary. These efforts will provide a scientific basis for the effective prevention and control of soil microplastic pollution risks.
-
Microplastic Interface Transformation in Agricultural Soil–Crop Systems and Food Chain Transfer Risks
LUO Yongming, TU Chen, PAN Yanshuo, YANG JIE, HAO Zheng, LIU Ying
DOI: 10.11766/trxb202508190404
Abstract:
Microplastic pollution has emerged as an environmental issue requiring urgent attention in farmland ecosystems, involving multiple interdisciplinary fields such as soil science, environmental science, plant physiology, and ecotoxicology. This review systematically summarizes the transformation processes of microplastics at different interfaces within farmland soil–crop systems, with a focus on the transformation mechanisms and migration pathways occurring at the soil–liquid, soil–root, and root–stem interfaces. It further outlines the accumulation characteristics of microplastics within plants and their transfer behaviors in the “soil–crop–animal” food chain. The behavior of microplastics in the rhizosphere and within plants exhibits pronounced particle size effects, material-specific properties, and bioregulation features, enabling them to cross plant root barriers and migrate to edible tissues, thereby potentially posing risks to animal and human health via food chain exposure. Future research should strengthen the understanding of interface transformation mechanisms and in-plant migration pathways of microplastics in farmland soil–crop systems, with particular emphasis on their ecotoxicity, bioavailability, and risk thresholds. Such efforts will facilitate comprehensive assessments of food chain exposure and the development of pollution control technologies, providing a scientific basis for agricultural environmental safety and human health protection.
-
Effects of Microplastics on the Composition and Characteristics of Dissolved Organic Matter in Paddy Soils with Different Properties
Cai Yimin, Deng min, Liu Ting, Ouyang Da, Zhang Haibo
DOI: 10.11766/trxb202505300251
Abstract:
【Objective】Dissolved organic matter (DOM) plays a crucial role in maintaining soil carbon cycling and ecological functions. The accumulation of microplastics (MPs) in agricultural soils may alter the composition and stability of DOM. However, the mechanisms by which MPs of different polymer types affect DOM characteristics in soils with distinct physicochemical properties remain unclear. 【Method】In this study, two representative paddy soils, including acid paddy soil from Jinhua (JH, pH 5.03) and alkaline paddy soil from Cixi (CX, pH 8.26), were used as test soils. A 60-day microcosm incubation experiment was conducted by adding 0% and 0.5% of polyethylene (PE), polyvinyl chloride (PVC), and polylactic acid-Poly (butyleneadipate-co-terephthalate) (PLA+PBAT, Bio) MPs to investigate the effects of different MPs on soil basic physicochemical properties and DOM characteristics. Ultraviolet-visible (UV-Vis) spectroscopy and Three-Dimensional Excitation-Emission Matrix combined with parallel factor analysis (PARAFAC) were used to characterize variations in the DOM aromaticity, molecular weight, and fluorescent components under different treatments. 【Result】The results revealed that MP-induced effects were more pronounced in acidic JH soil than in alkaline CX soil. Among the treatments, Bio microplastic exerted the strongest influence. Compared to the control, Bio treatment in JH soil increased pH, dissolved organic carbon (DOC) concentration, and spectral slope (SR) by 2.09%, 4.58%, and 8.26%, respectively, while PE and PVC showed relatively minor effects. In the early stage (15 days), MPs significantly decreased SUVA254 values in JH soil, suggesting enhanced degradation or transformation of aromatic DOM components. This inhibitory effect gradually diminished over time. In contrast, no significant effects were observed in CX soil under any treatment. Furthermore, JH soil exhibited continuous declines in pH and SUVA values and an increase in SR during the incubation, indicating a trend toward lower molecular weight and simpler DOM structures. Meanwhile, CX soil maintained relatively stable DOM characteristics throughout the experiment. 【Conclusion】The impact of MPs on soil DOM was strongly influenced by both polymer type and soil properties. Biodegradable MPs, such as Bio, had a more substantial effect on DOM structure than traditional MPs such as PE and PVC. Acidic and coarser-textured JH soil was more vulnerable to MP interference and temporal changes, resulting in increased DOM reactivity and instability. In contrast, alkaline, fine-textured CX soil exhibited greater resistance to MPs-induced perturbations and maintained higher DOM structural stability.
-
Research Progress in Environmental Behavior of Biodegradable Plastic Mulches in Soils
YAN Qi, ZHUANG Jiahe, HU Qiuning, LIU Yan, HE Defu
DOI: 10.11766/trxb202505290248
Abstract:
Agricultural plastic mulch films, while enhancing crop yields, also cause severe "white pollution." As an environmentally friendly alternative, biodegradable mulches (BDMs) have attracted significant attention in recent years. This paper systematically reviews research progress on the environmental behavior of BDMs in soil, with a focus on analyzing their degradation mechanisms, the release characteristics of microplastics and additives, and their associated environmental risks. BDMs can be degraded through the synergistic action of chemical hydrolysis, photo-oxidation, and microbial enzymatic breakdown; however, the degradation rate is influenced by environmental factors such as soil temperature, moisture, and microbial communities. The degradation process of BDMs typically leads to concentrated releases of microplastics, with their abundance increasing by 30%-50% compared to conventional mulch films. These microplastic fragments can further adsorb other pollutants. BDMs additives are characterized by their diverse types and high actual leaching potential in soil, yet their actual toxicity risks remain unclear. Current research still has shortcomings regarding the "degradation-release-response" cascade mechanism of BDMs, their cross-media migration, and risk assessment. Future efforts require material innovation, in-depth analysis of environmental behavior, and policy coordination to optimize the degradability of BDMs and reduce ecological risks.
-
Differential Responses of Net Nitrogen Transformations in Rhizosphere Soil with Different Root Diameters to Nitrogen Deposition
Lu Lu, Zhou Jiake, Wang Jing, Jing Hang, Cheng Yi
DOI: 10.11766/trxb202503200125
Abstract:
【Objective】Under the influence of root, rhizosphere soil has rich nutrients and active microbial biochemical activities, and its nitrogen (N) cycling process is significantly faster than that of non-rhizosphere soil. However, whether rhizospheric N transformation characteristics differ among root diameters, and whether their responses to N deposition are significant remain unclear. 【Method】This study focused on non-rhizosphere and rhizosphere soil with different root diameters of Pinus tabuliformis on the Loess Plateau of China (very fine root, 0-0.5 mm; medium fine root, >0.5-1.0 mm; coarse fine root, >1.0-2.0 mm). Additionally, long-term experimental plots were established with four simulated N deposition levels (N 0, 3, 6, 9 g·m-2·a-1). An indoor incubation experiment was carried out to determine changes in soil net N mineralization and nitrification rates of non-rhizosphere soil and rhizosphere soil with different root diameters, as well as their responses to N deposition. 【Result】The results showed that: 1) The net N transformation rates in rhizosphere soil varied significantly among different root diameters (P<0.05), and the highest rates were observed in rhizosphere soil of very fine root (2.16 mg·kg-1·d-1 for mean net N mineralization rate and 6.67 mg·kg-1·d-1 for mean net nitrification rate). 2) With the increase of N addition, net N mineralization and net nitrification rates decreased first and then increased, peaking at N 6 g·m-2·a-1 or 9 g·m-2·a-1 treatment. In contrast, the net N transformation rates of non-rhizosphere soil were significantly inhibited by N addition (P<0.05). Moreover, net N transformation rate of rhizosphere soil of very fine root was more sensitive to N addition than that of coarse root and non-rhizosphere soil. 3) Correlation analysis and structural equation model showed that low N addition inhibited net N transformation rates through its significant association with soil ammonium content, whereas high N addition enhanced rates via significant linkage to soil carbon-nitrogen ratio. 【Conclusion】N deposition significantly altered the N transformation process of rhizosphere soil, with distinct variations observed among different root diameters. Therefore, strengthening the study of N transformation process in plant rhizosphere soil is helpful to refine the rhizosphere effect and the assessment of forest soil N cycle.
-
Study on the Process of Nitrite-Dependent Anaerobic Methane Oxidation in Rhizosphere and Bulk Soils of Paddy Fields
dailei, wangyanping, baiyanan, shenlidong
DOI: 10.11766/trxb202503250136
Abstract:
【Objective】Paddy fields are significant anthropogenic sources of methane emissions, and anaerobic oxidation of methane (AOM) is an important pathway for mitigating methane emissions from paddy fields. The application of nitrogen fertilizers in paddy fields makes nitrite a primary electron acceptor for AOM. However, existing studies have focused on nitrite-dependent AOM in bulk soils of paddy fields, leaving the activity and functional microbial community characteristics of nitrite-dependent AOM in rhizosphere soils poorly understood. 【Method】Through indoor slurry incubation experiments combined with 13CH4 stable isotope tracing, quantitative PCR, and high-throughput sequencing, this study systematically investigated the nitrite-dependent AOM activity, NC10 bacterial gene abundance, and community structure in rhizosphere soils and bulk soils at different depths (0-10, 10-20 and 20-30 cm) under different fertilization treatments (CF: chemical fertilizer; OF: organic fertilizer combined with chemical fertilizer; SF: straw return combined with chemical fertilizer). 【Result】The results showed that the nitrite-dependent AOM activity in rhizosphere soils ranged from 1.03 to 2.42 nmol·g-1·d-1, which was significantly higher than that in 0-10 cm, 10-20 cm, and 20-30 cm bulk soils, respectively. The pH, soil organic carbon (SOC), and nitrite contents were identified as the main environmental factors influencing nitrite-dependent AOM activity. The NC10 bacterial gene abundance in 0-10 cm bulk soils ranged from 7.44×106 to 2.39×107 copies·g-1, which was significantly higher than that in rhizosphere soils, 10-20 cm, and 20-30 cm bulk soils, respectively. Correlation analysis revealed that SOC was the primary factor affecting NC10 bacterial abundance. Additionally, high-throughput sequencing revealed significant differences in NC10 bacterial community structure between rhizosphere and bulk soils. PCoA analysis indicated that soil water content, pH, and nitrate content were the main environmental factors influencing NC10 bacterial community structure.【Conclusion】These findings demonstrate significant differences in nitrite-dependent AOM activity, NC10 bacterial abundance and community structure between rhizosphere and bulk soils under different fertilization treatments. The findings demonstrate that the rhizosphere serves as an active hotspot for nitrite-driven AOM, providing a deeper understanding of the AOM process and offering theoretical basis for mitigating methane emission from paddy fields.
-
Study on the Community Characteristics and Ecological Functions of Periphyton
ZHANG Zhike, SHI Qing, ZHAO Bin, WEI Yuquan, ZHANG Hao, CAI Linying, SONG Yinan, CHEN Weisheng
DOI: 10.11766/trxb202502170064
Abstract:
Periphyton (PHT), widely distributed in aquatic ecosystems, function as critical multi-interface carriers across water-sediment-atmosphere boundaries, playing vital ecological roles in energy flow, element cycling, and pollutant remediation. This work reviews recent advancements in the fields of PHT research, both in domestic and international contexts, emphasizing on the analysis of community structures and the corresponding characteristics exhibited under varying environmental conditions. The ecological functions of PHT within aquatic ecosystems are explored, along with the identification of key environmental factors like environmental conditions and media that influence its growth and ecological functions. PHT plays a crucial role in nutrient cycling within aquatic ecosystems. As primary producers, they offer essential nutrients to the ecosystem and serve as effective bioindicators of water quality, with the ability to bioaccumulate heavy metals. Key environmental factors such as temperature, light availability, and pH regulate the growth of PHT, with dominant species in the community shifting in response to changing environmental conditions. Furthermore, anthropogenic activities, nutrient loading, and soil conditions significantly influence the composition, structure, and functional dynamics of PHT communities. Additionally, this work evaluates the potential of the application of PHT-based research to environmental management, sustainable agricultural practices, as well as ecological amendment, with an emphasis on innovative eco-engineering solutions. According to these findings, present study recommends that future work should undertake more in-depth and systematic investigations into the roles of PHT in the degradation and treatment of emerging contaminants, the integration with multidisciplinary approaches and advanced technologies, as well as their applications in other fields. This review aims to provide a theoretical framework and scientific guidance for interdisciplinary research and industrial development on identifying PHT community structures, enhancing ecological functions, and advancing sustainable ecological restoration practices.
-
Distribution Characteristics of Typical Antibiotic-Resistant Bacteria and Antibiotic Resistance Genes in Different Land Types in Jinji River Basin
Li Yeshan, Feng Shuo, Zhang Zhuoyi, Zhu Changxiong, Zhang Yanrong, Li Hongna
DOI: 10.11766/trxb202502130059
Abstract:
【Objective】 The application of antibiotics has significantly advanced animal husbandry and agriculture. However, the resulting contamination by antibiotic-resistant bacteria (ARB) and antibiotic resistance genes (ARGs) poses a severe threat to the ecological environment and human health. This study aims to systematically investigate the effects of different land use types within the same region on the distribution of ARB and ARGs in soil. 【Method】 This study collected 210 soil samples from six typical land use types (vegetable fields, wheat fields, flower gardens, orchards, nurseries and livestock farms) in the Jinji River basin of Beijing. The abundance of total cultivable bacteria, chlortetracycline-resistant bacteria, sulfamethoxazole-resistant bacteria, and representative ARGs in the soil was measured. Additionally, the structural characteristics of representative soil microbial communities were analyzed using high-throughput sequencing technology. 【Result】 The results indicate that the resistance contamination in Zhang Town and Longwantun Town of the Jinji River basin was the most severe. The abundance of ARB, ARGs, and intI1 in vegetable field soil was significantly higher than that in other land use types (P<0.05). Bacteroidetes, Firmicutes, Saccharibacteria, and Deinococcus-Thermus were the dominant bacterial phyla in the soil. Also, Lysobacter and Devosia were identified as the main host bacteria for ARGs, and they showed significant positive correlations with sul1, sul2, tetG, tetX, and intI1 (P<0.05). 【Conclusion】 Based on our results, the resistance level of vegetable field soil in the Jinji River sub-basin was significantly higher than that of other land use types. Thus, it is essential to focus on the optimized application of organic fertilizers to reduce the potential risks of soil microbial resistance and ecological health.
-
The Behaviors and Influencing Factors of Reactive Oxygen Species Generation at the Soil-Water Interface Containing Biochar Under Simulated Solar Illumination Conditions
WANG Haowei, HOU Yucheng, YAO Jiayi, LI Mengwei, FANG Jing, SHAN Shengdao
DOI: 10.11766/trxb202506200296
Abstract:
【Objective】Reactive oxygen species (ROS) at the soil-water interface play a crucial role in carbon/nitrogen cycling and pollutant transformation. However, it is still unclear how biochar influences the formation of ROS at the soil-water interface. Thus, this study aims to explore the formation behaviors and factors influencing ROS generation at the soil-water interface containing biochar. 【Method】Under simulated solar illumination conditions, the probe capture method was used to quantitatively analyze the generation kinetics and mechanisms of three typical ROS (hydroxyl radical ?OH, hydrogen peroxide H2O2, and superoxide radical (O2??) at the 10 gkg-1 biochar-amended soil-water interface. The effects of biochar pyrolysis temperature, dissolved biochar carbon (DBC), clay minerals (kaolinite), and dissolved organic matter (fulvic acid) on ROS formation were also examined at such interfaces. 【Result】The results showed that under light, substantial ?OH and H2O2 were generated at the biochar-containing soil-water interface, with concentration ranges of 0.43-0.83 μmolL-1 and 21.12-30.93 μmolL-1, respectively, which were 1.39-2.65 times and 1.31-1.91 times higher than those at the biochar-free interface (control group). In contrast, O2?? concentration was low (< 0.2 μmolL-1), significantly lower than that in the control. DBC played an important role in the formation of ROS, and after removing DBC, the generation of H2O2 in the water-soil interface containing biochar was significantly inhibited, but the generation of ?OH was not affected. Also, kaolinite significantly inhibited the capacity of biochar to mediate ROS generation at the soil-water interface under light (except for high-temperature biochar) and reduced the conversion efficiency of H2O2 to ?OH. Fulvic acid significantly enhanced H2O2 generation at the light-irradiated, biochar-containing soil-water interface but decreased ?OH concentration.【Conclusion】Light plays a critical role in mediating ROS formation at the biochar-amended interface: it not only promotes H2O2 generation and transformation, but also facilitates ?OH production and O2?? conversion. However, biochar-mediated ROS generation at the interface is not entirely dependent on light. The generation of ROS at the light-irradiated, biochar-amended soil-water interface is collectively determined by biochar surface persistent free radicals, oxygen-containing functional groups, as well as dissolved organic carbon and Fe2+ contents at the interface. These findings provide an important reference for understanding the formation and distribution of ROS in biochar-amended soils.
-
Interactive Effects of Poly-γ-Glutamic Acid and Irrigation Quota on Saline-Alkali Soil Properties and Cotton Yield
WANG Shan, ZHANG Jinzhu, WANG Zhenhua, ZHANG Jihong, LIU Mengjie, MA Zhanli, ZHENG Jiliang
DOI: 10.11766/trxb202506130284
Abstract:
【Objective】To establish scientifically grounded, synergistic regulatory approaches for the comprehensive mitigation of the persistent challenge of saline–alkali soil degradation in cotton-growing systems, this study conducted a controlled field experiment during the 2024 cotton season on moderately saline–alkali soils in Manas County, Xinjiang. The objective was to elucidate how the integrated application of poly-γ-glutamic acid (γ-PGA) and regulated irrigation influences soil biochemical processes, cotton physiological performance, yield formation, and fibre quality under field conditions.【Method】A two-factor randomized block design was established, involving three γ-PGA rates (F1: 7.5 kg·hm-2; F2: 15 kg·hm-2; F3: 22.5 kg·hm-2) and two irrigation quotas (W1: 4 000 m3·hm?2; W2: 4 500 m3·hm?2). Comprehensive measurements included soil physicochemical indices (Electrical conductivity (EC) -based salinity and pH variations across growth stages), key enzymatic activities (polyphenol oxidase, catalase, urease, sucrase), root morphological traits (length, diameter, biomass ratios), organ-specific dry matter accumulation, and yield and fibre parameters (boll number, lint percentage, composite quality index).【Result】Compared with F1 and F2, the F3 treatment effectively suppressed peak soil salinity and pH, concurrently elevating enzymatic activity, particularly urease, which increased by 30.13%-35.22 %. Nevertheless, the response plateaued beyond the F3 level, suggesting diminishing returns under higher γ-PGA concentrations. Enhanced enzymatic activity and improved rhizosphere conditions promoted root proliferation and biomass accumulation, resulting in a moderate but statistically significant yield increase (3.02%–27.96 %). Likewise, a higher irrigation quota (W2) alleviated surface salt accumulation and improved enzyme activities by 9.16%-48.33%, although excessive irrigation risked secondary salinization through capillary rise and nutrient leaching. Also, multivariate analyses (Principal component analysis and Pearson correlation) revealed a strong positive correlation (P < 0.05) between enzyme activity and yield traits. At the same time, soil salinity and alkalinity showed negative correlations with fibre quality indices, emphasizing the trade-off between osmotic stress alleviation and fibre maturation under saline conditions.【Conclusion】The combined application of 22.5 kg·hm?2 γ-PGA with 4 500 m3·hm?2 irrigation proved the most efficient configuration within the tested range, primarily by ameliorating the rhizosphere microenvironment (lower EC/pH and enhanced enzymatic turnover) and optimizing photosynthate allocation to reproductive organs. However, the overall improvement remains conditional on soil salinity thresholds, long-term stability, and economic feasibility. Thus, while the integrated γ-PGA–irrigation strategy significantly enhances cotton yield and fibre quality in saline–alkali soils, its scalability and sustainability under variable climatic and hydrological regimes warrant further investigation.
-
Isolation and Characterization of Poly(butylene adipate-co-terephthalate) Microplastic Film-Degrading Bacteria from Soil Co-Composting Environments
ZHOU Qian, DAI Guoli, PAN Chennan, JIANG Jiamiao, WEI Ji''an, ZHANG Jun, ZHANG Ming, ZHANG Daoyong, PAN Xiangliang
DOI: 10.11766/trxb202507050330
Abstract:
【Objective】Poly(butylene adipate-co-terephthalate) (PBAT) serves as a crucial alternative to conventional plastic mulch films. However, the presence of aromatic chains renders PBAT more recalcitrant to biodegradation compared to other biodegradable plastics (e.g., polylactic acid). Moreover, there are limited microbial resources exhibiting efficient PBAT degradation capabilities.【Method】This study employed a soil-compost enrichment approach to screen high-efficiency PBAT-degrading microbial strains. Microbial consortia were enriched at 60 ℃ under thermophilic composting conditions using PBAT as the sole carbon source, yielding six candidate strains (designated B1-B6). Degradation efficacy was comprehensively evaluated through mass loss, surface morphology analysis, and water contact angle measurements.【Result】Strain B3 demonstrated superior PBAT degradation efficiency, achieving a 17.85%±11.22% mass loss within 7 days, exceeding currently reported values for PBAT-degrading microorganisms. Atomic force microscopy (AFM) analysis revealed significant surface modification across all treatment groups, with B3-exposed PBAT exhibiting the most pronounced surface roughness (Ra = 44.84±26.48 nm). Concurrent physicochemical characterization showed a 15.6° reduction in water contact angle, collectively indicating substantial polymer matrix alteration. Taxonomic identification through 16S rRNA gene sequencing classified strain B3 as?Parageobacillus toebii.?In addition, characterization of the degradation performance of the mixed microbial consortium (designated as MIX) showed that MIX achieved a PBAT degradation rate of 12.48%±1.11%. Although the impact on surface roughness of PBAT was relatively minor, MIX induced the most significant changes in water contact angle, indicating a pronounced degradation effect. High-throughput 16S rRNA sequencing analysis revealed that, at the species level, the dominant strain within the MIX consortium was Parageobacillus toebii, accounting for 98.50% of the population. Other minor constituents included Aeribacillus pallidus (1.45%), unclassified_g_Lactobacillus (0.01%), unclassified_c_Bacilli (0.02%), unclassified_k_norank_d_Bacteria (0.01%), and unclassified_g_Clostridium_sensu_stricto_1 (<0.01%). These findings suggest that the PBAT degradation capability of the MIX consortium is primarily attributed to Parageobacillus toebii. Through whole genome sequencing and Kyoto Encyclopedia of Genes and Genomes (KEGG) gene function annotation, it was identified that strain B3 possesses genes encoding enzymes relevant to PBAT degradation, including carboxylesterase, arylesterase, long-chain acyl-CoA synthetase, aldehyde dehydrogenase, alcohol dehydrogenase, and catechol 2,3-dioxygenase. Based on the above results, the potential degradation pathway of PBAT microplastics by the degrading microbes could be inferred as follows: (1) Initial hydrolysis: PBAT ester bonds are first cleaved by carboxylesterases, releasing intermediate products such as terephthalic acid and adipic acid. (2) Aliphatic chain metabolism: Adipic acid is activated into its CoA derivative by long-chain fatty acid-CoA ligase and subsequently undergoes β-oxidation catalyzed by acyl-CoA dehydrogenase to form acetyl-CoA. Short-chain aldehyde/alcohol byproducts generated during aliphatic chain metabolism are further degraded by aldehyde dehydrogenase and alcohol dehydrogenase. (3) Aromatic ring degradation and ring-cleavage: Terephthalic acid undergoes hydroxylation to form catechol, which is then cleaved by dioxygenases, producing intermediates that enter the tricarboxylic acid cycle.【Conclusion】This study successfully isolated Parageobacillus toebii B3 as a high-performance PBAT degrader through multi-parametric characterization (mass loss, surface topography, and hydrophilicity changes). The findings provide both theoretical foundations and practical microbial resources for controlling biodegradable microplastic pollution.
-
Phytic Acid-modified Biochar Reduces Soil Cd Release by Regulating pH and Aggregates Structure
DI Dongliu, XIAO Jiang, GAI Xu, LI Pujun, CHEN Guangcai
DOI: 10.11766/trxb202507010321
Abstract:
【Objective】Phytic acid-modified biochar exhibits excellent adsorption capacity for cadmium (Cd) in aqueous solution; However, its effectiveness and mechanisms in remediating Cd-contaminated soils remain unclear. This study systematically analyzes the dynamic impact of phytic acid-modified biochar on soil properties, investigates its effect on Cd release in soil, and reveals the key mechanisms underlying biochar regulation of Cd movement in soil. 【Method】 Soil incubation experiments were conducted to systematically evaluate the remediation and amelioration effects of bamboo biochar (BBC), phytic acid-modified bamboo biochar (PABC), and sodium phytate-modified bamboo biochar (SPBC) on Cd-contaminated soils over various incubation periods (0, 10, 20, 60, 120, and 180 days). 【Result】The addition of biochar significantly altered the pH of both soil and soil solution and increased the electrical conductivity (EC). SPBC exhibited the highest EC and total carbon concentration in the soil solution, while PABC showed a distinct advantage in supplying total phosphorus, particularly in the short term. During the early and mid-phases (0-120 days), biochar treatment significantly reduced the Cd concentration in soil solution (24.60%-99.35%), with a significant dose-response effect, and SPBC exhibited the most effective remediation. In addition to their inherent adsorption mechanisms, biochar also inhibited Cd release indirectly by affecting the chemical (pH, total phosphorus, and total carbon), physical (aggregate structure), and biological properties (urease and acid phosphatase) of the soil and soil solution, with soil pH and micro-aggregate content identified as key factors influencing Cd release. In the later phase (120-180 days), enhanced soil aggregate stability further facilitated the remediation process, as biochar increased the activity of urease and acid phosphatase. 【Conclusion】 Phytic acid-modified biochar demonstrates strong potential for both Cd remediation and soil improvement in heavily contaminated soils, offering significant application value.
-
Effects of Biochar Application on Organic Carbon Composition of Different Density Fractions in Paddy Soil
ZHU Mengtao, MA Ruiling, CAI Ying, YI Qi, JIANG Shuo, LIU Zhiwei, BIAN Rongjun, ZHANG Xuhui, ZHENG Jufeng, LI Lianqing
DOI: 10.11766/trxb202502170063
Abstract:
【Objective】Soil organic carbon (SOC) sequestration in agricultural ecosystems is critical for mitigating climate change and maintaining soil fertility, with mineral-associated organic carbon (MAOC) playing a central role in long-term C stabilization. Paddy soils with higher SOC density exhibit distinct biogeochemical cycles due to periodic flooding and anaerobic conditions, making their SOC dynamics particularly complex. While biochar amendment has emerged as a promising strategy to enhance SOC storage, the specific mechanisms by which biochar interacts with soil mineral fractions and modulates native SOC stability remain poorly understood. Previous studies have primarily focused on total SOC changes, overlooking the differential responses of mineral-bound C pools to biochar input. This knowledge gap hinders accurate assessments of biochar"s long-term C sequestration potential in paddy systems. The present study aimed to address this gap by investigating how biochar amendment affects SOC distribution across density-based mineral fractions and alters native SOC dynamics through advanced spectroscopic and isotopic tracing techniques.【Method】In this study, a field experiment was established in a typical paddy soil in southern China, with two treatments: biochar application at 15 t·ha?1 (C15) and no biochar (C0). After two years of rice cultivation, soil samples were collected from the 0-15 cm depth and subjected to sequential density fractionation using sodium polytungstate solutions with gradient densities (1.65, 1.85, 2.05, 2.25, 2.45, 2.65 g·cm?3). Each fraction was characterized for SOC content, stable isotope composition (δ13C), and chemical functional group via Fourier-transform infrared spectroscopy (FTIR). Scanning electron microscopy (SEM) coupled with energy-dispersive X-ray spectroscopy (EDS) was used to visualize particle morphology and elemental composition, while X-ray diffraction (XRD) identified dominant mineral phases in each fraction. Isotopic mixing models were applied to quantify biochar-derived C versus native SOC contributions across density gradients.【Result】The results showed that (1) Based on SOC content and soil minerals categories, density fractionation successfully separated soil into three functionally distinct pools: particulate organic carbon (POC, <1.85 g·cm?3), clay mineral-associated C (1.85~2.45 g·cm?3), and primary mineral-bound C (>2.45 g·cm?3). XRD analysis confirmed that the 1.85~2.45 g·cm?3 fraction was enriched in 2:1 phyllosilicate (e.g., montmorillonite, illite) and Fe/Al oxides, whereas the >2.45 g·cm?3 fraction contained quartz and feldspars. Fourier-transform infrared spectroscopy (FTIR) demonstrated that the intensities of O-H stretch (2923 cm–1) for aliphatic structures and C=C stretch (1610 cm–1) for aromatic compounds gradually decrease in both biochar application (C15) and non-application of biochar (C0) treatments with increasing density, while SOC stability progressively increased. (2) SOC content of density-specific changes varied under biochar amendment: Contribution of SOC in the <1.65 g·cm?3 fraction increased by 150.1%, driven by biochar particles, while the 1.65~1.85 g·cm?3 fraction showed a 60.9% increase, due to biochar-derived C adsorption onto clay minerals. Conversely, the 1.85~2.05 g·cm?3 clay fraction exhibited a 37.4% reduction in SOC contribution. δ13C analysis confirmed biochar-C presence across all fractions, with the highest incorporation (64.5%) in the <1.65 g·cm?3 fraction. Native SOC depletion was observed in five density intervals, with the most severe loss (-41.2%) in the <1.65 g·cm?3 fraction, indicating strong positive priming. Notably, priming extended to the 1.85~2.25 g·cm?3 clay fraction (-14.6%), suggesting biochar-induced microbial activity stimulated decomposition of relatively stable mineral-protected C.【Conclusion】This study demonstrates that biochar amendment effectively enhances total SOC content in paddy soil within two years, but its C sequestration efficiency is offset by priming-induced native SOC losses across labile and mineral-protected pools. The findings highlight the need to account for biochar-microbe-mineral interactions when evaluating long-term C sequestration. By linking density fractionation with spectroscopic and isotopic tools, this research advances understanding of mineral-mediated C stabilization in biochar-amended soils, providing a basis for optimizing biochar application strategies (e.g., feedstock selection, application rate) to maximize C sink capacity in rice-based systems. Future work should focus on long-term monitoring of priming effects and microbial community shifts to refine sustainable soil C management practices.
-
Research Progress on the Classification and Application of Life History Strategy in Soil Microbial Community
LIANG Shuxin, SHAO Jiahui, YE Jinru, QI Yuhao, ZHANG Ruifu, SHEN Qirong, XUN Weibing
DOI: 10.11766/trxb202502180068
Abstract:
Soil microbial community drives biogeochemical cycles and is crucial for maintaining soil health and ecosystem sustainability. However, the complexity of microbial community composition and the diversity of microbial functions present significant challenges in classifying and understanding microbial community based on functional traits. Life history strategy theory links microbial metabolic characteristics with ecological processes, providing critical insights into the relationship between microbial communities and ecosystem services. This review systematically summarizes the theoretical frameworks and recent advances in soil microbial life history strategy, outlining the original theories and their developmental trajectory. It focuses on the two-way continuum (r-K life history strategy theory and oligotrophic-copiotrophy life history strategy theory) and the three-way continuum (C-S-R and Y-A-S life history strategy theories), highlighting their conceptual foundations and practical applications in soil microbial community researches. However, current studies primarily rely on descriptive analyses of microbial functional composition, lacking investigations into the dynamic expression and regulation mechanisms of microbial functions. Based on this, we propose future research directions on soil microbial life history strategies to support sustainable agriculture. First, integrating multi-omics technologies is essential for assessing the functional dynamics of microbial community. While current sequencing methods (e.g., amplicon and metagenomic sequencing) can identify potential microbial functions based on the genomic information, they fail to capture real-time microbial activity in fluctuating environments. A combined approach incorporating transcriptomics, proteomics, metabolomics, and single-cell Raman spectroscopy can provide deeper insights into real-time gene expression, metabolic processes, and other critical aspects of soil microbial communities. Second, elucidating the molecular mechanisms that regulating the microbial life history strategies is crucial. Microbes dynamically reprogram their functional traits in response to environmental changes, yet the signaling networks and genes governing this reprogramming remain largely unknown. Future research should focus on understanding the interactions among environmental factors, microbial gene expression, and microbial functional investments. Additionally, synthetic biology approaches can facilitate the engineering of programmable microbial strains, enabling precise control over microbial functions in complex ecosystems. Third, expanding current life history strategy theories to incorporate species interactions within ecosystems is necessary. Existing frameworks primarily emphasize microbe-environment interactions while neglecting biotic interactions, particularly in agricultural ecosystems. For example, rhizosphere microbes enhance plant stress resistance and growth by producing plant hormones such as cytokinins, yet these functions are not currently integrated into life history strategy frameworks. Future studies should explore how microbial life history strategies regulate soil-microbe-plant interactions and quantify their contributions to ecosystem services. We emphasize the need to establish a multidimensional, dynamic analytical framework for microbial life history strategies, elucidate the driving mechanisms underlying microbial life history transitions, and refine the response framework of soil microbial life history strategies in agricultural ecosystem services. We advocate for developing microbial life history classification into a core theoretical tool for ecosystem function regulation, providing microbiome-based solutions to address global change and food security challenges.
-
Characteristics and Ecotoxicity on Earthworms of Aging Microplastics of Different Types in Soils
LI Xia, LI Yanpei, ZHENG Yalan, DAI Yunchao, JIA Hanzhong
DOI: 10.11766/trxb202502190070
Abstract:
【Objective】The ecotoxicity of microplastics (MPs) to soil fauna is widely recognized. However, the degree of MP aging under different exposure durations, their differential toxic effects on soil fauna, and the dynamics of toxicity changes remain poorly understood.【Methods】In our study, microcosm experiments were conducted to compare both the aging degree of polyethylene (PE-MP) and polylactic acid microplastics (PLA-MP) exposed for 30/60 days and their ecotoxicities to earthworms. 【Result】The characteristic peak intensity of both aged PE-MP and PLA-MP exhibited significant alterations at 717 cm?1 and within the 1000-1257 cm?1 range. The carbonyl index (CI) of PE-MP and PLA-MP increased from 0.26 to 0.72 and 3.23 to 3.35, respectively. Also, scanning electron microscopy (SEM) demonstrated visible surface cracks and fractures, confirming aging on both MPs. Aging significantly enhanced the toxicity of MP on earthworms and the redox balance of earthworms was disrupted when exposed to both PE-MP and PLA-MP. This was associated with fluctuations in reactive oxygen species (ROS) and oxidative stress. After 60 days of exposure, the concentration of malondialdehyde (MDA) increased by 36.22% and 11.47%, while glutathione-S-transferase (GST) increased by 107.32% and 33.44% in PE-MP and PLA-MP treatments, respectively. In addition, the activities of superoxide dismutase (SOD), peroxidase (POD), and catalase (CAT) decreased by 27.07% & 30.62%, 24.78% & 55.51%, and 52.90% & 47.78%, respectively. SEM and histopathological analyses revealed more severe damage to the epidermis and intestinal tissues in PLA-MP-exposed earthworms than those of PE-MP. Intestinal MP bioaccumulation significantly increased from 2.50±0.28 μg·mg–1 to 6.17±0.13 μg·mg–1 with prolonged exposure, ultimately causing irreversible physiological impairment. 【Conclusion】The aging of PE-MP and PLA-MP in soil induced significant physiological damage and oxidative stress in Eisenia fetida. Notably, PLA-MP shows greater susceptibility to aging and induces stronger physiological toxicity compared to PE-MP.
-
Research Progress and Future Perspectives on Soil Nitrogen Cycling in Tropical Croplands of Hainan
JU Xiaotang, ZHANG Chong, ZHANG Limei, SONG Xiaotong, LI Tingyu, LIU Shuoran, LIU Siyi
DOI: 10.11766/trxb202503020097
Abstract:
Hainan is the only province in China entirely situated within the tropical region, characterized by abundant light, heat, and water resources, making it the most typical tropical agricultural production base in China. However, restrictive factors such as "poor, acidic, and leaky" soils, coupled with high nitrogen (N) fertilizer inputs in crop cultivation, led to significant risks for N loss in farmlands and severe environmental pollution. The agricultural non-point source pollution situation in Hainan is severe, N and phosphorus discharged from agriculture enter nearshore waters via short transport pathways, leading to serious degradation of coral reefs and seagrass beds. However, the generally weak foundation of research on N cycling in Hainan"s tropical farmland soils hindered the development of scientific and targeted N regulation measures. In response to the characteristics of tropical agricultural resources, we propose that future research should focus on four key areas: the characteristics of N transformation, the fate and loss pathways of N, the mechanisms of efficient N utilization in crops, and the principles and regulation measures for reducing N fertilizer application while enhancing efficiency. More attention should be paid to the effects of organic matter-mediated soil fertility and acidity improvement on soil N transformation in Latosols, the mechanisms underlying high ammonia emissions in acidic soils and nitrate accumulation in deep soil profiles, as well as the impact of organic material inputs on nitrous oxide emissions. We emphasize the need to clarify the relationship between the transformation and migration characteristics of N in farmland soils and crop N use efficiency, and to elucidate the mechanisms by which soil carbon (C) pool expansion affects N transformation, migration, retention, and loss prevention. Thus, to propose a principle for reducing N fertilizer application while enhancing efficiency, centered on "increasing C to retain N, coupling C and N, controlling losses, and coordinating N supply". This approach will form an innovative theory and solution. The finding would provide scientific and technological support for the development of efficient and green tropical agriculture and offer a scientific basis for understanding regional differences in N cycling across global climate-soil zones.
-
Research status on the pollution characteristics and control technologies of soil microplastics
Wang Kai, Zhang Jinrui, Xu Li, Liu Qin, Hu Can, Ren Siyang, Liu Xiuting, Zhu Tong, Yan Changrong, Liu Xuejun
DOI: 10.11766/trxb202504200184
Abstract:
Microplastics in soils pose potential threats to human health and food security, and the attention to this issue is increasing. However, there is still no clear and unified conclusion on the current status of soil microplastic pollution, as well as corresponding governance measures. Clarifying the current status of soil microplastic pollution is of great significance for its effective management. This article provides an in-depth exposition on the concept and development of microplastics, summarizes the pollution characteristics, sources, and ecological environmental effects of soil microplastics, and discusses the obstacles and uncertainties existing in current soil microplastic research. We have suggested potential research directions for soil microplastics according to the current research gaps. We have also proposed strategies for addressing and managing soil microplastic pollution, aiming to lay the foundation for research on soil microplastic pollution and its prevention and control.
-
Effects of Slope-to-tiered Measure and Crop Type on Soil Organic Carbon Pools and their Compositions in Sloping Cropland in Purple Soil Areas of China
ZHANG Sheng, WANG Guan, WANG Yuehuan, ZHOU Zihe, CHENG Jinhua
DOI: 10.11766/trxb202502120058
Abstract:
【Objective】Purple soil is a soil type unique to China, characterized by rapid weathering of the parent material, low permeability, and poor erosion resistance. A large number of slope conversions have been adopted to combat soil erosion, but the synergistic effect of this measure with crop types on the local organic carbon pools of sloping arable land and their composition is not clear. 【Method】In this study, Corn Slope, Corn Terracing, Citrus Slope, Citrus Terracing, Corn-Citrus Terracing in the East River sub-basin in Chongqing were selected as the research objects. Biomarker methods were used to compare the differences in soil microorganisms and organic carbon of plant origin from different types of sloping arable land and to reveal the effects of slope-to-staircase measures on soil organic carbon pools and their compositions.【Results】The results showed that: 1) The contents of SOC, POC, and MAOC in different types of sloping arable land was significantly decreased with the implementation of slope reclamation measures; 2) Slope reclamation significantly decreased the total lignin phenol content in maize sample plots compared to the significant decrease in the degree of oxidation of lignin phenol in citrus sample plots; 3) The main source of microbial organic carbon in all sample plots was fungal residue, which accounted for 74.50%~98.88%, and the slope conversion measures decreased the fungal content in the soil under the monocrop planting mode. 【Conclusion】Although slope conversion measures helped to reduce soil erosion, they had a complex impact on the soil organic carbon pool and its composition in sloping arable land in the purple soil zone. This provides a scientific basis for optimising agricultural management practices and achieving sustainable land use in the purple soil zone.
-
Characteristics and Potential Risks of Microplastic Pollution in Typical Karst Spring Water
AN Xianjin, ZHANG Yaqin, WANG Yanling, YAO Jiajia, FU Huicheng, ZHAO Tingjie, TIAN Yini, DU Penghui, AN Lihui
DOI: 10.11766/trxb202506190294
Abstract:
【Objective】Microplastics (MPs) represent a pervasive class of emerging contaminants that have been widely documented across global environmental compartments. Despite this recognition, significant knowledge gaps remain regarding their fate and behavior within fragile karst groundwater ecosystems, particularly those that serve as critical drinking water resources. The unique hydrogeological features of karst systems, characterized by rapid infiltration through fractured limestone, raise serious concerns about MP transport and human exposure pathways. These systems, however, remain severely understudied. This study aims to address these uncertainties through a comprehensive investigation of the occurrence, distribution, underlying mechanisms, and potential ecological and health risks associated with MP contamination in a representative karst groundwater system used for drinking water.【Method】To account for temporal variability in these dynamic systems, we systematically collected water samples every quarter across four seasons (spring, summer, autumn, winter) from both pristine karst springs (Raw Water, RW) and downstream household tap water endpoints (End Water, EW) in a typical karst terrain in Southwest China. Laboratory analyses employed high-resolution microscopic Raman spectroscopy for definitive polymer identification and characterization of isolated MP particles. Subsequent statistical analyses used the Mantel test to rigorously examine correlations between MP concentrations and a suite of water quality parameters. Additionally, the Pollution Load Index (PLI) was calculated to provide an integrated assessment of MP pollution levels and to quantify potential environmental and human health risks. 【Result】The findings revealed significant MP contamination throughout the karst aquifer system. A total of 2,273 MP particles were identified across all 72 water samples. The detected MPs exhibited distinct physical characteristics: fragments were dominant (50.37%), followed by fibers (40.61%). Particle size analysis showed a predominance within the 100–300 µm range (59.08%), and most particles appeared transparent (78.79%) under microscopy. Polymer composition analysis indicated that polyethylene (PE; 44.08%) was the most abundant polymer, followed by polyethylene terephthalate (PET; 35.02%) and polypropylene (PP; 16.89%). The mean MP abundance was 1.58±1.43 items·L⁻¹ across all samples. Notably, significantly higher concentrations were observed in raw water sources (RW: 1.89±1.70 items·L⁻¹) compared to finished tap water (EW: 1.26±1.05 items·L⁻¹), suggesting partial removal during transport or treatment. Pronounced seasonal variations were observed, in the following order: autumn (2.67±2.08 items·L⁻¹) > spring (1.58±1.30 items·L⁻¹) > summer (1.13±0.63 items·L⁻¹) > winter (0.94±0.53 items·L⁻¹) (P < 0.05). The calculated Pollution Load Index (PLI = 1.10) indicated that the current MP pollution level in this karst groundwater system poses a relatively low risk. 【Conclusion】Key correlation analyses provided insight into MP transport mechanisms. A significant positive correlation was found between MP abundance and dissolved organic carbon (DOC) concentrations (P < 0.05), suggesting that organic matter facilitated MP mobilization. A negative correlation was observed between calcium ion (Ca²⁺) concentration and MP abundance (R² = 0.40), possibly reflecting interactions influenced by aquifer mineralogy. In contrast, no significant correlation was found between MP levels and antecedent monthly precipitation (P > 0.05), indicating that direct flushing during storm events may not be a major influence. These results collectively underscore that intrinsic water chemistry plays a more decisive role in MP transport and accumulation within karst aquifers than transient hydrological events. Based on these findings, we recommend urgent strengthening of protective measures for karst spring water sources, establishing long-term MP monitoring programs in vulnerable karst regions, and developing mitigation strategies along water supply chains to prevent future escalation of MP pollution risks.
-
Effects of Different Organic Fertilizers on Rhizosphere Microbial Carbon Source Utilization, Nematode Community, and Nutrient Absorption of Jackfruit
CHEN Hongxing, MO Yuncong, XU Yadong, SU Lanxi, BAI Tingyu, WU Gang, XUN Weibing, XU Zhihui, ZHAO Qingyun
DOI: 10.11766/trxb202506120277
Abstract:
【Objective】This study aimed to investigate the regulatory differences of various organic fertilizers on the rhizosphere microorganisms, nematode communities, and nutrient absorption of jackfruit, so as to select suitable organic fertilizers to construct a healthy soil microecology, and provide a theoretical basis for targeted regulation of soil quality.【Method】Malaysian No.1 grafted seedlings were used as experimental materials, and the latosol formed by granite was used as test soil in this study. The experiment was designed to have six treatments: CK (no fertilizer), DF (soybean flour), YF (sheep manure), JF (chicken manure), NF (cow manure), and CF (chemical fertilizer only), for comparing the effects of different fertilizers on the biomass accumulation, nutrient absorption, and soil microenvironment of jackfruit. 【Result】The application of organic fertilizer generally promoted the biomass accumulation and nutrient absorption of jackfruit, and increased the soil pH and organic matter. NF significantly improved the proportion of soil organic matter, available nitrogen, and potassium nutrients, but significantly reduced the proportion of soil available phosphorus compared to other treatments. The application of JF also significantly increased the contents of soil available nitrogen, phosphorus, and potassium; however, YF treatment induced the weakest effect among all organic fertilizer treatments. Also, the YF treatment had the highest number of soil nematodes and nematode abundance in each trophic group, followed by the NF treatment. The Shannon-Weiner diversity index and evenness index of soil nematodes in the organic fertilizer treatment were significantly higher than those in the CK and CF treatments. In addition, the soil microbial communities under different fertilization treatments all exhibited relatively active metabolism towards carbohydrates, amino acids and carboxylic acids, while their metabolic capabilities towards polymers, phenolic acids, and amides were weaker. The diversity and evenness index of soil microbial community structure in the DF treatment were significantly higher than those in other organic fertilizer treatments. Mantel analysis showed a significant correlation between plant biomass, nematode community, nematode trophic groups, microbial carbon source utilization, and soil pH. Also, the Mantel analysis of nematode community, bacterial-feeding nematode, and omnivorous/predacious nematode with soil organic matter showed significant correlation. 【Conclusion】The application of organic fertilizer can promote the growth and nutrient absorption of jackfruit, increase soil organic matter, and improve soil microecology. Moreover, organic fertilizers from sheep and cow manure is beneficial for increasing the total number of soil nematodes and the number of nematodes in each trophic group, while soybean flour can enhance the activity of rhizosphere microorganisms and promote carbon source utilization. For practical applications, specific organic fertilizers or their combinations can be selected based on the basic soil conditions for targeted regulation of soil health, providing a theoretical basis for high crop yield and efficient resource utilization.
-
Spatiotemporal Variation Characteristics of Agricultural Environmental Costs Under Fertilizer Input in Northeast China
ZHANG Xilun, WANG Ping, WANG Jingkuan
DOI: 10.11766/trxb202505200230
Abstract:
【Objective】Northeast China is an important grain production base, and it is also one of the largest fertilizer consumption markets. Over the years, the application of many chemical fertilizers has led to increasingly prominent negative impacts on the agricultural ecological environment. Using the application rate of chemical fertilizer in Northeast China in the past three decades, it was estimated environmental cost (EC) from different potential pollution, and their comprehensive environmental cost (CEC) and environmental cost load (ECL). This research will provide a scientific basis for realizing agricultural sustainable development in Northeast China and ensuring China "s food security. 【Method】Combining energy analysis and disability-adjusted life year assessment, the spatial and temporal distribution characteristics of EC from different potential pollution sources, and their CEC and ECL were analyzed in Northeast China from 1990 to 2022. The EC in different provinces and cities and their potential causes were evaluated, and countermeasures and suggestions for reducing EC were put forward. 【Result】 (1) From 1990 to 2022, the CEC of fertilizer application in Northeast China gradually increased, from 42.12 million yuan to 3 200.55 million yuan, an increase of 76 times, with an average annual growth rate of 14.49%. The growth rates of the 1990s, 2000s, and 2010s were 22.69%, 16.67%, and 7.78%, respectively, which gradually slowed down. (2) In 2022, the total EC of air, water, and soil pollution caused by chemical fertilizer application was 542.37 million yuan, 749.36 million yuan, and 190.88 million yuan, respectively. Ammonia and nitrate, respectively, contributed the most to air, water, and soil pollution. Their ECs respectively were 467.92 million yuan, 691.76 million yuan, and 1 485.17 million yuan, reaching 82.64% of the total EC. (3) The largest change in CEC was mainly concentrated in the line from Jiamusi to Chifeng, while the smaller change was concentrated in the line from Yanbian to Dalian. The largest changes in ECL were mainly concentrated in most areas of Liaoning Province, Tongliao, Shuangyashan and the surrounding areas of Jixi, while the smaller changes were mainly in Siping, Yichun, Daxing"anling, and Xilinguole. 【Conclusion】 In the past three decades, the CEC of chemical fertilizer application in Northeast China has increased year by year, but the growth rate has gradually slowed down, indicating that the impact of chemical fertilizer application on the environment has been significantly alleviated. In addition, the EC and ECL showed obvious spatial distribution characteristics, which indicates that the impact intensity of the southern and southern coastal areas was stronger than the northern inland areas. In future research, it is recommended that the focus should be directed towards typical black, brown, and other types of soil in Northeast China, as well as typical cultivated areas such as the corn belt and miscellaneous grain area in Northeast China, to further explore the spatial differences of CEC. Although chemical fertilizer input can increase grain yield, it also brings high EC, which requires scientific fertilization measures according to local conditions. It is necessary to continue to promote scientific fertilization and reasonable intercropping/rotation to improve the utilization efficiency of chemical fertilizers. Finally, the effect of reducing fertilizer application and being environmentally friendly will be realized to ensure the sustainable development of agricultural production in Northeast China.
-
Screening of Alkali-Producing Strains and Their Amendment Effect on Acidic Soil
LIU Chong, LIU Yang, WANG Dan, LU Yusheng, ZHU Xiaoxuan, WEN Shuheng, WANG Yong, ZHU Zixin, LI Yaying, GU Jun, GU Wenjie
DOI: 10.11766/trxb202505230237
Abstract:
【Objective】Managing soil acidification in farmland soils is of great significance to ensure national food security and sustainable agricultural development. Microorganisms have important application value in soil improvement. However, the research on alkali-producing microorganisms and the mechanism of improving acid soil is still lacking. This study aimed to systematically explore the mechanisms of acidified soil remediation by alkali-producing microorganisms, with a focus on overcoming the limitations of functional microbial resource scarcity and field application technology gaps. 【Method】Systematic screening was employed to isolate alkali-producing microorganisms from acidic soils in South China. Indoor simulation experiments evaluated its pH elevation capacity through repeated inoculation. Genomic analysis revealed its urease gene cluster (ureABCEFGD), and field trials assessed the effects of single-dose application on soil pH and crop yield. 【Result】We screened 109 alkali-producing bacterial strains (65% belonging to Bacillus spp.) and 24 fungal strains (33% Trichoderma spp.). The alkali-producing ability and stability of alkali-producing bacteria were generally stronger than those of fungi, with Lysinibacillus fusiformis LW-3 identified as a key strain. Within 15 weeks of continuous culture, repeated inoculation of L. fusiformis elevated soil pH by 1.5 units, reduced exchangeable aluminum by 23.46%, and decreased hydrolytic acid by 31.80%. Genomic analysis revealed that L. fusiformis LW-3 carried a complete urease gene cluster (ureABCEFGD). Lysinibacillus fusiformis LW-3 could ameliorate acid soil by enhancing soil urease and protease activities, metabolizing ammonia, consuming hydrogen ions through bicarbonate, and reducing the content of active and potential acids in soil. Field application confirmed that soil pH stably increased by 0.2 units and enhanced Chinese cabbage yield by 11.6%. 【Conclusion】This study elucidated a multi-pathway synergy mechanism for acidified soil remediation, including alkali production, enzymatic activity regulation, and acid speciation transformation. These findings indicate that the strain L. fusiformis LW-3 has good application prospects in acid soil amendment, providing technical support for alkaline-producing microbiome-driven soil acidification management.
-
Improved Diffusion Method for Determination of Natural Abundance and Low-Concentration Labeled NH4+-15N in Soil Extracts
YOU Zhijie, YE Ping, ZHANG Siwei, DAI Shenyan, WEN Teng, ZHANG Jinbo
DOI: 10.11766/trxb202505080209
Abstract:
【Objective】The 15N isotope ratio of NH4+-N plays a crucial role in nitrogen transformation research and is widely applied to soil, water, and other samples with sufficient inorganic nitrogen content. While the diffusion method is the most effective technique for isolating and transforming soil NH4+-N, its application remains limited for low-concentration and natural abundance NH4+-N. 【Method】In this study, it is aimed to evaluate the feasibility of using the diffusion method alone for transforming and measuring low-concentration (≤1 mg·L-1) labeled and natural abundance NH4+-15N. To establish a diffusion system for rapid and accurate determination, this study improved the acid trap material and production method, incubation time, reaction volume, and incubation temperature. 【Result】The results demonstrated that: (1) The envelope diffusion packet acid trap exhibited higher nitrogen recovery?(95.0%) and better precision (standard deviation <0.010 atom%) compared to suspended acid traps. Envelope packets fabricated from domestic high-purity polytetrafluoroethylene (PTFE) could replace imported Merck Millipore PTFE, reducing costs by >90%.?The improved diffusion packet not only reduced the cost, simplified the operation and also increased N recovery to 99.8%. (2) The diffusion method accurately and sensitively measured the labeled NH4+-15N concentrations as low as 0.2 mg·L-1 with an error <0.006 atom%, and the difference between the corrected and the expected value was <0.020 atom%. In addition, diffusion method further exhibited robust performance in natural abundance NH4+-15N (≥1 mg·L-1), with an error ≤0.30‰ and a deviation from the expected less than 0.38‰. (3) Expanding the sample volume to 100 mL for low-concentration labeled samples and employing envelope packet acid traps for 8-day diffusion at 25 ℃ not only significantly enhanced recovery, measurement accuracy and precision, but also enabled accurate quantification of low-concentration NH4+-N (≥0.2 mg·L-1) with minimal isotopic deviation (Δ15N<0.020 atom%) after correction with standards. For even lower concentrations of labeled or natural abundance NH4+-N, it is advisable to combine diffusion method with additional methods. While heating can effectively shorten the incubation time and improve recovery, it also amplified interference from exogenous nitrogen impurities.?And heating may lead to increase the interference of dissolved organic nitrogen (DON) in natural soil or water samples, necessitating cautious application during practical measurements. 【Conclusion】Overall, diffusion remains a powerful method for transforming and measuring NH4+-15N in soil. This study enhances the concentration threshold and accuracy of labeled sample diffusion methods while significantly reducing experimental duration. The improved diffusion protocol can be used for measuring NH4+-15N at different concentrations and abundances, providing a theoretical foundation for accurate soil inorganic nitrogen analysis.
-
Effects of Soil Microbial Diversity on Soil Multifunctionality Under Sustained Intensive Forest Management
HUANG Cheng, WU Lin, LI Xu, FU Songling, FENG Chun, WANG Zhaocheng, LIU Hua
DOI: 10.11766/trxb202505240239
Abstract:
【Objective】Soil microorganisms serve as crucial mediators, bridging organic and inorganic environmental factors. They play a significant role in regulating multiple soil functions. Forest management represents the primary anthropogenic disturbance to forest soils, yet the mechanisms through which soil microorganisms influence soil multifunctionality (SMF) under continuous intensive management remain unclear. 【Method】This study investigated Carya cathayensis var. dabeishansis secondary forests in the Dabie Mountains to explore the mechanisms by which soil microbial diversity affects SMF under sustained intensive forest management. The authors analyzed 45 plots under varying management durations (0, 3, 8, 15, 20 years) and management metods (CK: no management; EM: extensive management; IM: intensive management) in Jinzhai County, Anhui Province. The soil microbial diversity (amplicon sequence variant, ASV) number, Simpson index, Shannon-Wiener index, and Chao1 richness index for bacterial and fungal communities) and 15 indicators related to four soil functions: nutrient supply (alkali-hydrolyzable nitrogen (AN), available phosphorus (AP), available potassium (AK), microbial biomass nitrogen (MBN), microbial biomass phosphorus (MBP)); nutrient storage (total nitrogen (TN), total phosphorus (TP), total potassium (TK)); nutrient cycling (acid phosphatase (ACP), urease (UE), sucrase (SC), β-1,4-glucosidase (BG), protease (Pro)); and carbon storage (soil organic carbon, SOC), microbial biomass carbon (MBC)) were measured. SMF was calculated using both the single-function approach and the averaging method. Two-way ANOVA was employed to compare management effects, while Pearson correlation, Mantel tests, and random forest models identified key functional indicators. Structural equation modeling (SEM) was constructed to analyze regulatory pathways. 【Result】The results indicated that short-term management (3 years) significantly enhanced soil microbial diversity and SMF (bacterial Shannon index peaked under IM at year 3; SMF increased by 0.94 compared to CK). However, both declined significantly with prolonged management, with bacterial ASV number and Shannon index decreasing by 19.63% and 3.46% after 20 years of intensive management, respectively. Management duration exerted a significantly greater impact on microbial diversity and SMF than management regime (P < 0.001), and IM amplified this temporal effect (e.g., carbon storage, nutrient cycling, and supply functions under IM-15 were significantly lower than CK). Random forest analysis identified SOC, TP, MBC, AN, TK, MBN, SC, and BG as key indicators of SMF (P < 0.05). SEM revealed that microbial diversity influenced SMF by indirectly regulating soil nutrients and enzyme activities (explaining 57.4% of the variation): bacterial diversity positively drives nutrient and carbon storage. In contrast, fungal diversity governed nutrient cycling and carbon storage. Nutrient supply and storage functions were the core contributors to SMF, where TP and TK indirectly affected SMF by regulating AN, MBN content, and SC/BG enzyme activities. Moreover, long-term management induced soil acidification, SOC loss, and phosphorus limitation (TP significantly decreased after 15 years), impairing microbial community function. This subsequently reduced enzyme activities (e.g., SC, BG) and nutrient turnover efficiency, ultimately leading to SMF degradation.【Conclusion】 This study revealed that the loss of soil microbial diversity is a key factor in SMF degradation under long-term intensive forest management. Thus, optimizing management strategies (supplementing carbon/phosphorus fertilizers, reducing nitrogen fertilizer application, decreasing understory vegetation clearance frequency) to maintain soil ecological functions is highly recommended. These findings provide a theoretical basis for the sustainable management of economic forests in mountainous regions.
-
Effects of Low Temperature-Acclimatized Rhizosphere Soil Microorgasims of Sphagneticola trilobata on the Cold Tolerance of Different Geographical Populations
LI Yifan, GONG Zongzhi, LIU Junzhen, QI Shanshan, CHENG Pengfei, DAI Zhicong, DU Daolin
DOI: 10.11766/trxb202504040158
Abstract:
【Objective】 The invasive plant Sphagneticola trilobata has been expanding to higher latitudes and colder regions since it invaded China due to its rapid adaptability to the environment. As a part of the rhizosphere environment, the rhizosphere microbial community plays an important role in plant invasion and resistance to abiotic stress. However, the effect of rhizosphere microorganisms on the cold tolerance of invasive plants remains to be elucidated. It is therefore hypothesized that rhizosphere microorganisms of S. trilobata acclimated to cold stress play an important role in the improved cold resistance of S. trilobata populations to spread to high latitudes (colder regions).【Method】In this study, two populations of S. trilobata from the southernmost (Sanya ) and northernmost (Wenzhou ) regions of China were used as the research objects, and the cold-acclimatized rhizosphere soil microorganisms of these two populations of S. trilobata were used as microbial agents. Afterwards, the feedback effects of rhizosphere soil microorganisms on the cold tolerance of host plants after low temperature acclimation was explored through soil feedback experiments.【Result】 Under low temperature stress, the inoculation of rhizosphere microbial community significantly increased the biomass, root growth, chlorophyll and leaf nitrogen content of S. trilobata. The maximum photochemical efficiency and photosynthetic performance index of S. trilobata were significantly enhanced by inoculation of rhizosphere soil microbial agents domesticated by the northern (Wenzhou) population, and the relative content of anthocyanins was significantly reduced, indicating that it was less affected by low temperature stress. 【Conclusion】 The results showed that S. trilobata could improve its tolerance to low temperature stress by recruiting rhizosphere microorganisms, and the effect of northern populations was better. This indicates that domestication and recruitment of cold-tolerant rhizosphere microorganisms could promote the expansion of S. trilobata to higher latitudes. Moreover, this study provides an explanation for the possible reasons for differential cold tolerance in different populations of S. trilobata from the perspective of rhizosphere microorganisms, and emphasizes the necessity and urgency of strengthening the supervision of the current invasion boundary regions of S. trilobata.
-
Sources, Behavior, and Effects of Tire Wear Particles in Soil
LIU Chunguang, WU Zhouyu, ZHAO Ziqing, LIU Xiaotong, WANG Lei, SUN Hongwen
DOI: 10.11766/trxb202507210355
Abstract:
With the rapid global increase in the number of motor vehicles, the release of tire wear particles is also growing significantly. Tire wear particles can enter the soil through multiple pathways, such as atmospheric deposition, rainfall, and surface runoff, and pose a potential threat to soil ecosystems. The complexity of separation and detection technologies has limited in-depth research on tire wear particles in soil. In recent years, with the continuous improvement of detection methods, research on the behavior and effects of tire wear particles in soil has developed rapidly. This paper summarized the sources of tire wear particles and their primary pathways into soil, analyzed the key behaviors of tire wear particles and their additives in soil, and reviewed the toxicological effects of tire wear particles and their released compounds on plants, soil fauna, and soil microorganisms. On this basis, it also identified the shortcomings of the current research and proposed future research directions, aiming to support a deeper understanding of the behavioral mechanisms of tire wear particles in soil and their ecological risk assessment.
-
Effects of Microplastics on the Characteristics of Soil Dissolved Organic Matter Components in Maize Cropping Systems
LU Lijia, DUAN Zhuoran, SUN Yuanze, JI Jianghao, SONG Ruiping, WANG Jie
DOI: 10.11766/trxb202507200354
Abstract:
【Objective】Soil serves as a significant sink for microplastics (MPs), with the annual influx of MPs into soil being 4 to 23 times greater than that entering the ocean. Therefore, the assessment of the potential environmental effects of soil MPs cannot be ignored. As a non-natural carbon source, the precise impact of MPs on dissolved organic matter (DOM) in soil-crop systems remains unclear. 【Method】This study investigated the behavior of conventional MPs (polyethylene, PE; polystyrene, PS) and biodegradable MPs (polybutylene adipate terephthalate, PBAT; polybutylene succinate, PBS; polylactic acid, PLA) in soil using maize-cultivated pot experiments. We measured dissolved organic carbon (DOC) concentration, DOM fluorescence characteristics, and DOM molecular composition and properties in the system after MPs addition. 【Result】The results showed that MPs increased soil DOC content, as well as the humification degree and stability of DOM. Simultaneously, MPs decreased the H/C ratio of DOM molecules and the relative content of amino acid, carbohydrate, and protein-like molecules in the soil-plant system, while increasing the aromaticity index (AI) and nominal oxidation state of carbon (NOSC) values. 【Conclusion】Overall, this study reveals the impact of different types of MPs on DOM components in soil-crop systems, providing an important theoretical basis for the comprehensive assessment of the environmental risks of MPs and the formulation of plastic control policies.
-
Research Progress and Prospects of Micro(nano) Plastic Labeling Technologies in the Soil-Plant System
LIU Zijian, TU Chen, FENG Kai, YANG Jie, MA Shiqi, ZHANG Jie, LIU Ying, MA Yini, LUO Yongming
DOI: 10.11766/trxb202507010319
Abstract:
Microplastics and nanoplastics (MNPs), defined as plastic fragments, fibers, and particles with diameters below 5 mm and 1 μm, respectively, are widely spread emerging contaminants in soil environments. Due to frequent material exchanges within the soil–plant system, MNPs can be transferred from soil into plants, accumulate and distribute across various plant tissues, and thus pose a potential threat to the health of the soil–plant system. MNPs can significantly alter soil physicochemical properties and migrate from soils into plant tissues, leading to adverse effects on plant growth and physiological-biochemical functions. To overcome the limitations imposed by the complexity of the environmental matrix, advanced labeling techniques provide a fast and efficient way for visually tracking and quantifying MNPs in soil-plant systems, which are essential for deepening mechanistic understanding. This review systematically evaluates four mainstream labeling methods. Fluorescent labeling is cost-effective and easy to implement, but limited by photobleaching and interference from environmental matrices. Metal-based labeling combined with inductively coupled plasma mass spectrometry (ICP-MS) allows for stable quantification, though it may change the physicochemical properties of MNPs. Stable isotope labeling (such as ¹³C or ¹⁵N) provides high specificity for tracing degradation pathways but faces challenges due to technical complexity and background signals as well. Radioisotope labeling (e.g., ¹⁴C, ³H) offers ultrahigh sensitivity but raises concerns regarding environmental biosafety and high costs. On this basis, this paper focuses on introducing rare earth element labeling technology, which uses the fluorescence properties of lanthanide chelates and their quantifiable characteristics to simultaneously realize visual tracing and precise quantification of MNPs. It is particularly suitable for studying environmental behavior and food chain transmission risks of MNPs in soil-plant systems. In the future, new markers that are more precise and efficient should be developed, and new labeling technologies that combine multiple labeling methods should be developed to more systematically and comprehensively reveal the environmental fate and ecological risks of MNPs, and provide a scientific basis for pollution control of MNPs in soil-plant systems.
-
A Rheological Approach to Study the Effects of Biochar Addition on the Mechanical Stability of Soil Structures
HE Bing, LI Jiangwen, ZHOU Lin, SUN Jian, XU Chenyang, DU Wei, HU Feinan
DOI: 10.11766/trxb202502220080
Abstract:
[Objective] Biochar plays an important role in improving soil physicochemical properties and enhancing soil structural stability. It achieves this by increasing soil organic matter content, enhancing nutrient retention and availability, and improving soil structure changes that further promote soil aeration, water infiltration, and root penetration, thereby strengthening soil structural stability. Soil structural stability is critical for sustainable agricultural production, as it influences soil erosion resistance, water-holding capacity, and overall soil health. However, few studies have explored the effects of biochar addition on the mechanical stability of soil structure from the perspective of rheological methods. [Methods] To address this research gap, a two - year field experiment was conducted. Soil samples with different biochar addition rates (0%, 1%, 3%, 5%, and 10%) were tested for basic physicochemical properties. Additionally, amplitude sweep tests were used to measure soil shear strength and viscoelastic parameters under varying water contents (30%, 37.5%, 45%, and 60%), aiming to analyze how biochar addition levels affect the shear strength and viscoelastic properties of the soils. The amplitude sweep mode is a robust rheological technique that allows for the assessment of soil behavior under different deformation conditions, providing valuable insights into soil mechanical stability. [Results] The results showed that biochar addition significantly improved soil structural mechanical stability by enhancing soil basic physicochemical properties, such as increasing soil cation exchange capacity and organic carbon content, which in turn increased soil energy storage modulus and shear strength This effect was particularly pronounced at lower water contents ranging from 30% to 37.5%. At these water contents, the soil structure was more stable and better able to resist external forces. Furthermore, biochar addition also resulted in an increased range of the linear viscoelastic zone and higher soil yield stress, thereby improving its structural stability. Notably, at a 10% addition rate, the soil maintained strong stability even under high water content conditions. [Conclusion] Biochar addition enhances the mechanical stability of soil structure by improving soil shear strength and viscoelasticity. These findings clarify the mechanical mechanism underlying soil structure improvement via biochar application, and thus provide a scientific basis for formulating targeted soil structure optimization measures in the Loess Plateau region.
-
Effects of Mixed Planting Rare Tree Species on Soil Chemical Properties and Microbial Communities in Cunninghamia lanceolata Plantations
WU Qinqin, YE Zihao, HU Hanwen, HU Zhaogui, WU Jiasen
DOI: 10.11766/trxb202503300148
Abstract:
【Objective】Cunninghamia lanceolata is a significant timber species in subtropical China with a long cultivation history. However, persistent monoculture management has triggered multiple ecological issues, including soil nutrient depletion, biodiversity loss, and declining forest productivity. To enhance ecological functions and economic returns while achieving sustainable development of Cunninghamia lanceolata plantations, precious tree species were introduced through interplanting and their effects on soil chemical properties and microbial communities were investigated.【Method】Soil samples were collected from pure Cunninghamia lanceolata plantations (PC) and four mixed forests: Taxus wallichiana-C. lanceolata (MTC), Ormosia hosiei-C. lanceolata (MOC), Phoebe chekiangensis-C. lanceolata (MPC), and Houpoea officinalis-C. lanceolata (MHC) in Qingyuan Forest Farm, Zhejiang Province. Soil chemical properties were analyzed via standard protocols. Microbial community composition was characterized using 16S rRNA and internal transcribed spacer (ITS) high-throughput sequencing, while co-occurrence network analysis and partial least squares path modeling (PLS-PM) were employed to decipher microbial interactions and functional linkages.【Result】(1) Interplanting significantly improved soil chemical properties. The MPC treatment increased soil pH by 11.2% (P<0.05), while the MTC treatment elevated soil organic carbon (SOC) content to 31.8 g·kg-1, a 26.2% increase compared to PC (P<0.05). The MOC treatment significantly boosted available phosphorus (AP) content by 3.96 times relative to PC (P<0.01). (2) The bacterial co-occurrence networks in mixed forests exhibited increased nodes, edges, and path lengths. Significant differences (P<0.05) were observed in degree centrality, closeness centrality, and eigenvector centrality among the treatments. Notably, the MTC treatment resulted in the highest degree centrality and eigenvector centrality within the soil bacterial co-occurrence network, indicating the formation of a more efficient and stable bacterial community structure. (3) Functional gene analysis revealed distinct metabolic pathways: PC treatment was dominated by nitrogen respiration and nitrogen fixation functions, whereas MTC and MPC treatments activated xylanoly and nitrate reduction functions, respectively. (4) PLS-PM demonstrated that soil chemical properties indirectly influenced the expression of carbon and nitrogen cycling genes by regulating key microbial taxa, such as those within the Actinobacteria phylum.【Conclusion】Interplanting valuable tree species significantly enhances the stability of Cunninghamia lanceolata forest ecosystems by optimizing soil physicochemical properties and strengthening the complexity and functional redundancy of microbial networks. The improvements in soil chemistry (pH, SOC, AP), the formation of more complex and stable bacterial co-occurrence networks (particularly under MTC), and the shift towards specific functional genes (carbon decomposition, nitrate reduction) collectively underpin this increased ecosystem resilience. Based on the superior performance in fostering stable microbial structures and activating beneficial functional genes, the Taxus wallichiana-C. lanceolata mixed model (MTC) is prioritized for future promotion in southern China. Supplementing this with interplanting Phoebe chekiangensis is recommended to synergistically optimize overall soil quality.
-
Responses of Soil Bacterial and Fungal Community Characteristics to Organic Materials Application in Urban Green Soils
Niu Yuhui, Wang Qingfeng, Ma Xiang, He Xiaoli, Liang Jing
DOI: 10.11766/trxb202412230502
Abstract:
【Objective】Adding organic waste materials into soils significantly affects microbial characteristics, however, the responses of bacterial and fungal diversity, community compositions and their interactions to the addition of different types of organic materials in urban green soils remain poorly understood.【Method】Using mesh bag method, six types of organic materials including green waste (GW), green waste compost (GWC), biogas residue (BR), biogas residue compost (BRC), peat (PT) and biochar (BC) were selected to investigate the effects of organic materials addition on soil properties, microbial communities and co-occurrence network in urban green soils through a 16-month in situ experiment.【Result】The addition of organic materials greatly increased soil electrical conductivity, soil organic carbon, and soil total nitrogen content by 12.7%-49.0%, 34.1%-87.0%, and 4.2%-14.7%, respectively. Soil bacterial alpha (?) diversity did not change among all the treatments, while soil fungal ? diversity was obviously increased after organic materials addition, which was mainly regulated by soil electrical conductivity. The dominant fungi were Ascomycota in urban green soils. Fungal communities in GW and GWC treatments obviously differed from other treatments, which was significantly influenced by soil pH and microbial biomass carbon. In contrast, Proteobacteria, Acidobacteria, Chloroflexi and Fimicutes were abundant in urban green soils. Bacterial communities in BR and BRC treatments were distinctly separated from other treatments, which was primarily driven by the aromaticity index of organic materials. Further analysis of occurrence-network revealed six main ecological clusters. The relative abundances of microbe in each module were different among all the treatments and were significantly correlated with soil nutrients and aromaticity index of organic material. Specifically, the highest relative abundance of bacteria community in module 2, 3 and 4 was observed in BR and BRC treatments, which was positively correlated with dissolved organic carbon, microbial biomass carbon, and soil total nitrogen, indicating that addition of biogas residue and biogas residue compost might enhance soil nutrient availability and subsequently facilitate microbial activity.【Conclusion】This study concludes that adding different types of organic materials can regulate urban green soil microbial community composition and interaction patterns by influencing soil physicochemical properties, thereby altering soil carbon cycling. Organic materials with low aromaticity index, which are more easily decomposed by microorganisms, may accelerate soil carbon cycling, whereas organic materials with high aromaticity index may favor carbon retention in soils. These findings hold significant implications for accurately assessing the resource utilization of urban organic wastes and the improvement of microbial diversity and ecological function in green space soils.
-
Microbial Multi-kingdom Interaction Mechanism Underlying the Control of Tomato Bacterial Wilt by Reductive Soil Disinfestatio
XU Shunan, XIE Yi, LU Zhiyu, LI Ruimin, YAN Yuanyuan, REN Yi, ZHOU Xing, CAI Zucong, HUANG Xinqi
DOI: 10.11766/trxb202506070264
Abstract:
【Objective】The interrelationships within soil microbial communities play a crucial role in maintaining plant health. As an efficient ecological regulation measure for controlling crop soil-borne diseases, the impacts of reductive soil disinfestation (RSD) on the interrelationships of soil microbial communities and its contribution to plant disease control efficacy remain unclear. 【Method】Based on two field experiments, this study systematically investigated the effects of RSD on the intra-kingdom and cross-kingdom interactions within soil bacterial, fungal, and protist communities, as well as the associations between community interactions and tomato growth. 【Result】The results showed that compared with the control, the incidence of tomato bacterial wilt significantly decreased by 90.2% after RSD treatment, while the plant height of surviving plants and tomato yield increased by 13.5% and 57.4%, respectively. RSD treatment significantly reduced the diversity indices of soil bacterial and fungal communities, and significantly altered the community structures of bacteria, fungi, and protists. The microbial groups enriched by RSD treatment included the bacterial phyla Proteobacteria and Acidobacteria, the fungal phyla Ascomycota and Mortierellomycota, and the protist groups Rhizaria and Archaeplastida. Following RSD treatment, the total cohesion within soil bacterial communities, protist communities, and cross-kingdom communities significantly increased. Correlation analysis revealed that compared with community diversity and compositional structure, the total cohesion of bacterial communities, bacteria-fungi communities, and bacteria-fungi-protist communities exhibited stronger and more stable relationships with plant disease incidence, shoot length, and yield, and was significantly negatively correlated with plant disease incidence, and significantly positively correlated with yield and shoot length.【Conclusion】This study highlights the critical role of bacterial and cross-kingdom community interactions in determining plant growth and provides new insights into the disease-suppressive mechanisms of RSD treatment.
-
Ecological Intensification Enhance Soil Multifunctionality: A Review
Xue Wenfeng, Cheng Saisai, Hu Feng, Liu Manqiang
DOI: 10.11766/trxb202505040204
Abstract:
With the exacerbation of global food demand and climate change, there is an urgent need for agricultural systems to deliver multiple ecosystem functions and services. However, conventional agriculture, with its emphasis on yield maximization, has often exacerbated ecological issues such as biodiversity loss, soil degradation, and environmental pollution. Ecological intensification, grounded in nature-based solutions, aims to harmonize agricultural production with ecosystem functioning while enhancing soil multifunctionality at minimal environmental cost, thereby driving the transition of agricultural systems toward more sustainable production models. This review synthesizes the mechanisms through which ecological intensification enhances soil multifunctionality and elucidates the regulatory pathways of key management practices, including conservation tillage, diversified cropping, organic amendments, and the inoculation of beneficial organisms. Furthermore, we identified the major challenges, including the absence of a comprehensive evaluation framework for soil multifunctionality, limited understanding of trade-offs and synergies among functions, and insufficient insights into the mechanisms underlying the synergistic effects of multiple practices, and proposed targeted solutions to address these gaps. Finally, this review outlines future research priorities, emphasizing the need to establish dynamic, multi-scale research frameworks of soil multifunctionality that incorporate spatial and temporal dimensions; to deepen mechanistic understanding through theoretical and methodological innovation; and to promote regionally adaptive, context-specific management strategies through the integration of multiple ecological practices. By bridging scientific research and practical application, ecological intensification offers significant potential to simultaneously enhance agricultural productivity and ecosystem services, thereby supporting the long-term sustainability of agricultural systems.
-
Cultivated Land Soil Security Evaluation Based on the Earth
fengzhe, wangyixin, kanglong, peiwei, liangmeng, chen''anqi, wukening
DOI: 10.11766/trxb202503250139
Abstract:
【Objective】 Ensuring the security of soils in the Northeast Black Soil Region, a critical commodity grain production base in China, is essential for safeguarding the national food supply and promoting sustainable resource utilization. However, existing evaluation systems lack a comprehensive integration of multi-sphere interaction mechanisms within the Earth’s critical zone, making it difficult to quantify the synergistic effects of natural substrates and human activities. Thus, this study aims to address this gap by developing a systematic decision-making tool for the sustainable management of cultivated land resources in the Northeast Black Soil Region. 【Method】This study focused on Suihua City, a typical black soil region, and constructed a four-dimensional evaluation system of "Condition (C1)-Capability (C2)-Capital (C3)-Connectivity (C4)" guided by the Earth""s critical zone theory. Seventeen indicators (such as black soil layer thickness, cation exchange capacity, soil organic matter content, etc.) were selected from aspects including soil physical, chemical, and biological properties to characterize the cultivated land soil security pattern of Suihua City. Also, the influencing mechanism of Earth""s critical zone elements on soil security was evaluated by combining with the Random Forest model. 【Result】The results showed that: (1) The C1 state scores exhibited a spatial variation with higher values in the northeast and lower values in the southwest; C2 scores were generally high; C3 capital scores showed an opposite spatial pattern to C1, with lower values in the northeast and higher values in the southwest; and C4 scores did not display a clear spatial pattern. (2) The comprehensive soil security scores ranged from 54.3 to 88.4 (average of 77.7), with 84.9% of cultivated land classified as moderately secure or higher. Higher security regions (56.5%) were concentrated in Beilin District, Anda City, and Hailun City, while critical and insecure regions (15.1%) were mainly distributed in Qing’an County and Mingshui County. (3) The average means square error increase (%IncMSE) for the 17 indicators was 1.3%, with black soil layer thickness and soil organic carbon content having %IncMSE values of 10.7% and 3.7%, respectively, significantly higher than other indicators. 【Conclusion】The results of the study demonstrate that the four-dimensional evaluation framework rooted in the Earth""s critical zone theory effectively quantifies the interplay between natural substrates and anthropogenic activities. This approach elucidates the response mechanisms of soil security within the multi-layered structure of the critical zone, offering a systematic decision-making tool for sustainable management of cultivated land resources in black soil regions. These findings provide actionable insights for balancing agricultural productivity with ecological sustainability in ecologically fragile agroecosystems.
-
Responses of soil nutrients and microbial communities to elevated ozone concentrations across different rice cultivars
JI Yang, DU Yiming, ZHAO Mengying, ZHANG yijia, Li Yuxin, SHANG Bo, FENG Zhaozhong
DOI: 10.11766/trxb202502060048
Abstract:
【Objective】Elevated near-surface ozone (O3) concentrations are an increasing threat to rice production, but the mechanisms and dose effects on below-ground ecosystems, including soil nutrient cycling and microbial communities, remain poorly understood. 【Method】This study targeted three major rice cultivars (HuaiDao 5, NanJing 5055, and WuYunJing 27) in the Yangtze River Delta. Using open-top chambers, we conducted an 84-day fumigation experiment with four ozone concentration gradients, including [NF (ambient air), NF20 (ambient air + 20 nmol·mol-1 O3), NF40 (ambient air + 40 nmol·mol-1 O3), and NF60 (ambient air + 60 nmol·mol-1 O3)], to systematically analyze the dose-response effects of elevated O3 concentration on soil nutrients and microbial communities in paddy fields. 【Results】The results showed that increasing O3 concentration significantly altered soil NO3--N and available phosphorus (AP) contents, as well as the abundances of methanotrophs (pmoA gene) and archaea during the rice filling stage, whereas no significant effects were observed for soil DOC, total carbon (TC), available potassium (AK), bacterial or methanogen (mcrA gene) abundances. The interaction between O₃ fumigation and rice cultivar significantly affected soil NH4⁺-N, NO3⁻-N, and AP contents. Specifically, O3 fumigation significantly reduced NO3⁻-N contents in HuaiDao 5 and WuYunJing 27, although the inhibitory effect weakened with increasing O3 concentration. In contrast, NH4⁺-N content in NanJing 5055 significantly increased under the highest O3 treatment (NF60). Similarly, NH4⁺-N in HuaiDao 5 decreased under O3 stress but the effect weakened at higher concentrations, whereas NH4⁺-N in WuYunJing 27 increased under NF60. AP content in HuaiDao 5 exhibited a negative correlation with O3 concentration, whereas no significant effects were observed in the other two cultivars. O3 fumigation significantly increased the abundance of pmoA gene in NanJing 5055 and WuYunJing 27, with the promoting effect intensifying under higher O3 concentrations. Soil bacterial community analysis revealed cultivar-specific responses, the relative abundance of Bacteroidota in WuYunJing 27 and Chloroflexi in NanJing 5055 was positively correlated with O3 concentration, while the relative abundance of Bacteroidota in NanJing 5055 and Desulfobacterota in HuaiDao 5 showed significant negative correlations. Moreover, the abundance of carbon and nitrogen metabolic pathways in NanJing 5055 and WuYunJing 27 exhibited nonlinear dose-response relationships with increasing O3 concentrations. 【Conclusion】Our findings demonstrate that soil nutrient dynamics and microbial community responses to O3 stress are highly cultivar-specific, with evidence suggesting the existence of threshold concentrations for O3 sensitivity. However, accurately quantifying the mechanisms underlying O3-induced alterations in below-ground elemental cycling and identifying key ecological thresholds will require long-term in situ observations. These findings offer critical insights for assessing the ecological risks of ozone pollution in rice paddies and guiding the selection of ozone-tolerant cultivars.
-
Mechanisms of High Cadmium Accumulation by Wheat Grown in Alkaline Soils and Prospects for Mitigation Strategies
GAO Yan, FAN Guangping, LI Yuntao, SHI Gaoling, TONG Fei, LI Jiangye, CHEN Wei, GE Chenghao, ZHOU Dongmei
DOI: 10.11766/trxb202502060046
Abstract:
Wheat, serving as a staple food for one-third of the global population, has long been overlooked in terms of its grain cadmium (Cd) accumulation capacity and the resulting dietary exposure risks. By integrating analyses of global literature and our recent research findings, this study preliminarily clarified that wheat grown in contaminated alkaline soils exhibited high Cd accumulation capacity with elevated risks of exceeding food safety thresholds. In rice-wheat rotation farmland systems, the Cd enrichment factor of wheat grains at the same sampling points was significantly higher than that of rice. Remarkably, wheat grains exceeded China"s food safety standard in alkaline soils even when the Cd concentrations remained below the national risk screening threshold. Elevated soil pH levels induced a pronounced increase in wheat"s contribution to adult daily dietary cadmium intake, while concurrently reducing rice"s contribution, demonstrating that alkaline soil conditions amplify Cd exposure risks specifically through wheat-derived dietary pathways. The article further discussed the Cd speciation in alkaline soils and their influencing factors, analyzed the mechanisms related to Cd migration and its chemical binding forms at the root-soil interface, and explored the interaction effects between Cd and trace elements during uptake and translocation by wheat. In order to develop wheat-safe production technologies adapted to the characteristics of alkaline Cd-contaminated soils, future research should strengthen investigations into the molecular mechanisms of Cd interface processes in the wheat rhizosphere and Cd-trace elements interactions on uptake and translocation by roots.
-
Effect of Polyethylene Microplastics on Soil Physical Properties: The Interactive Effect of Particle Size and Content
Lian xiaoqing, Zhang Shufeng, Yang Xiao, Hu Can, Wang Xufeng, Wang Zaibin
DOI: 10.11766/trxb202412240508
Abstract:
【Objective】The extensive use of plastic film in Xinjiang has led to the accumulation of a large amount of microplastics (MPs) in farmland soil, causing changes in soil physical and chemical properties and affecting crop yields. 【Method】In this study, the interaction effect of the particle size and content of polyethylene microplastics (PE-MPs) on soil physical properties was systematically investigated by simulating the residual environment of microplastics in farmland. By designing different microplastic content and particle size treatment test groups and comparing their indicators with the blank control group, the impact of microplastics on soil physical properties was evaluated. 【Result】The results showed that PE-MPs significantly changed soil thermal dynamics, structural stability and water transport characteristics through size-content synergism: In terms of temperature control, microplastics reduce thermal conductivity by increasing surface roughness and porosity, and increase the daily average temperature of 5 cm soil layer by 0.97 ℃ (1 700 μm-1% treatment), and the thermal effect decreases with depth (0.67–0.93 ℃ decrease with 25 cm). In terms of structural remodeling, the treatments of large particle size (≥550 μm) and high content (≥0.25%) significantly reduced the bulk density, increased the porosity (55.62%-59.41% in the 1 700 μm treatment group), and promoted the formation of large aggregates (>0.2 mm) by physical adsorption (93% increase in proportion, mean weight diameter up to 3.70 mm); The water transport characteristics show that the water loss rate of large particle size microplastics (≥550 μm) is 1.2 times higher than that of 48 μm treatment due to the formation of millimeter cracks at low content (0.1%-0.25%), and the particle size effect is covered at high content (1%). Correlation analysis further revealed the nonlinear coupling mechanism of soil parameters. Correlation analysis further reveals the nonlinear coupling mechanism of soil parameters, with a highly significant positive correlation between the proportion of large aggregates and average particle size, and a negative correlation between bulk density and porosity.【Conclusion】It is pointed out that when the particle size is >550 μm and the content is >0.25%, microplastics may lead to ecological risks such as soil erosion resistance degradation and hydrothermal coupling imbalance by reconstructing pore network and aggregate bridging structure. In the future, it is necessary to combine microbial function and crop physiology studies to quantify the cascade effect of microplastic pollution, and provide cross-scale theoretical support for farmland pollution control and risk assessment.
-
Microplastic Pollution Characteristics and Ecological Risk Assessment in Soils of a Historical Non-Sanitary Landfill and Adjacent Farmland
ZHANG Peng, PENG Cheng, CHEN Xiaoyi, LIU hui, SUI Qian, ZHANG Wei
DOI: 10.11766/trxb202507040328
Abstract:
【Objective】Historically non-sanitary landfills continuously release microplastics(MPs) into adjacent soils due to the absence of impermeable lining systems, thereby exacerbating ecological risks at the site and in surrounding environments. This study aims to investigate the distribution characteristics and ecological risks of MPs in a historically non-sanitary landfill and adjacent farmland soils in Jiashan County, Zhejiang Province, East China. The research aims to identify key pollution sources and evaluate the efficacy of multi-method risk assessment frameworks for informing targeted pollution control strategies.【Method】For landfill sites and surrounding farmland topsoil, the distribution characteristics and ecological risks of microplastic pollution were revealed through the combined application of micro-Fourier transform infrared spectroscopy (µ-FTIR), the Pollution Load Index (PLI), Risk Characterization Ratio (RCR), the Multi-characteristics Potential Ecological Risk Index (MPERI), and Monte Carlo simulation.【Result】(1) Landfill soils exhibited significantly higher MPs abundance (7,425.5–21,306.5 items/kg) than farmland soils (199.5–2,868.5 items/kg). Polyethylene terephthalate (PET) and polyethylene (PE) were the main MP types in both sites (>70% of total MPs). Small-sized MPs (<1 mm) accounted for 70.9% in landfill soil and 66.3% in farmland soil, while transparent MPs comprised 71.8% and 53.1% in landfill and farmland soil, respectively. The landfill was identified as a potential source of farmland MPs. (2) Multi-model risk assessment revealed that PLI classified the landfill as medium-to-high risk and farmland as low-to-medium risk, whereas RCR and MPERI indicated low-to-medium risk for both. Risk escalated significantly at sites containing acrylonitrile resin (PAN). (3) Monte Carlo simulations demonstrated that farmland had a higher probability of low PLI risk than the landfill. Nevertheless, both RCR and MPERI might underestimate ecological risks in the landfill. Sensitivity analysis identified MPs polymer type as the paramount parameter influencing risk outcomes.【Conclusion】The landfill acts as a critical source of MPs contamination in adjacent agricultural soils. Discrepancies in risk outcomes across models highlight the necessity of integrating multi-method assessments with probabilistic approaches (e.g., Monte Carlo) to quantify uncertainties. Polymer type is a decisive factor in ecological risk, necessitating prioritized controls for PAN-containing MPs. This empirical-modeling framework provides a scientific basis for hierarchical management of MPs pollution in non-sanitary landfills and surrounding environments, promoting the application of probabilistic risk models in contaminated sites.
-
Spatial Differentiation Characteristics and Driving Factors of the Silica Neoformation Accumulation Layer in Northeast Black Soil Region: A Case Study of Liaoning Province
LIU Siwei, SUN Zhongxiu†, GUO Long, DUAN Siyi, WANG Qiubing
DOI: 10.11766/trxb202503210129
Abstract:
【Objective】This study aims to systematically investigate the spatial distribution and driving factors of silica neoformation accumulation layers in the Northeast Black Soil Region, which significantly affect soil physical properties, impede plant root penetration and water transport, and exacerbate slope erosion. 【Method】Taking Liaoning Province as a representative region, a total of 333 soil profile samples were integrated, and advanced machine learning techniques were used to quantitatively analyze the spatial distribution and characteristics of silica neoformation accumulation layers.【Result】The results indicate that silica neoformation accumulation layers were predominantly distributed across Shenyang, Tieling, Fushun, Benxi, Dandong, and Chaoyang, encompassing a total area of approximately 4,261 km2 with a model prediction accuracy of 0.42. Notably, the layers exhibited deep accumulation in the central terrace and hilly regions, whereas they were relatively shallower in the eastern mountainous areas. Specifically, the was an abundance of silica neoformation peaks in the central region (6.66% to 27.35%), with higher densities observed in the central and western regions (132.70–611.94 g·dm-3). The depth of occurrence was greater in the central and northern regions (21.06–74.06 cm), whereas the thickness was thinner in the eastern region (31.78–97.71 cm). Furthermore, the distribution of silica neoformation accumulation layers was significantly influenced by annual mean ground temperature, relative humidity, and precipitation. In the eastern part of Shenyang, frequent groundwater activities and favorable climatic conditions contributed to the formation of profound silica neoformation accumulation layers. Conversely, in mountainous areas such as Fushun, limited groundwater influence, higher terrain, affected by biological enrichment processes and precipitation patterns, resulted in limited silicon leaching. Furthermore, the depths of leaching and deposition were shallow, and the silica neoformation accumulation layer remains superficial. 【Conclusion】This study provides an important solid scientific basis for understanding the spatial distribution and influencing factors of silica neoformation accumulation layers. It also offers practical guidance for developing effective soil improvement strategies, highlighting the importance of addressing the issues related to enhancing soil health and sustainability in the Northeast China Black Soil Region.
-
Response of Soil Properties and Productivity to Application of Calcium Carbonate and Organic Matter in Acidic Vegetable Fields
GENG Jinzhao, LI Zhenlun, ZHANG Min, CHEN Fuhui, MA Zheng, LIANG Kang, LUAN Huilin
DOI: 10.11766/trxb202503130114
Abstract:
【Objective】Vegetable production is frequently associated with high nitrogen fertilizer application and intensive crop rotation, resulting in soil acidification, structural degradation, and proliferation of harmful microorganisms. These factors significantly impede the sustainable development of vegetable farming. 【Method】Therefore, this study investigated the short-term effects of organic fertilizer, potassium humate, calcium carbonate, and their combinations on soil properties, organic carbon components, and microbial community structure in acidic vegetable fields with an untreated control (CK). 【Result】(1) Results showed that the sole application of full-dose organic fertilizer significantly increased total nitrogen, available phosphorus, and available potassium in non-rhizosphere soil, while significantly increasing easily oxidizable organic carbon (EOC) in non-rhizosphere (by 22.70%) and rhizosphere (by 9.76%) soils. The sole application of full-dose calcium carbonate significantly raised soil pH but reduced available phosphorus in non-rhizosphere soil and alkali-hydrolyzable nitrogen, available potassium, and organic carbon (SOC) in rhizosphere soil. Most notably, the combined application of all three amendments significantly increased soil pH and Chinese cabbage yield, compared to CK, while also increasing SOC, EOC, dissolved organic carbon (DOC), and the abundance of soil bacteria, fungi, Gram-positive bacteria, Gram-negative bacteria, and actinomycetes. (2) Correlation analysis between soil physicochemical properties and microbial community structure revealed that alkali-hydrolyzable nitrogen and EOC were significantly positively correlated with all measured microbial groups in the non-rhizosphere, where DOC correlated positively with bacteria. Also, in the rhizosphere, DOC correlated positively with bacteria and Gram-negative bacteria. Redundancy analysis showed that in non-rhizosphere soil, alkali-hydrolyzable nitrogen had the greatest influence on microbial communities. In rhizosphere soil, available potassium and DOC were the main factors affecting microbial communities. (3) Correlation analysis between soil properties and Chinese cabbage yield indicated that yield correlated positively with non-rhizosphere pH and rhizosphere exchangeable Ca2? and Mg2?, but negatively with rhizosphere alkali-hydrolyzable nitrogen. Structural equation modeling revealed that exchangeable Ca2+, available phosphorus, and alkali-hydrolyzable nitrogen had significant positive effects on cabbage yield, with Gram-negative bacteria indirectly influencing yield through available phosphorus. 【Conclusion】Based on these results, it can be concluded that the combined application of calcium carbonate and organic amendments effectively mitigated soil acidity, enhanced soil organic carbon sequestration, increased microbial biomass, and stabilized soil productivity. This study provides an important reference for research aimed at managing soil acidification and improving crop yields in acidic soils.
-
Information Statistics and Property Analysis of Commercially Acidic Soil Amendments
YU Junfeng, Guo Xinyi, LI Zhongyi, Fu Dengwei, WANG Yuanpeng, ZHOU Jia, WANG Shuai
DOI: 10.11766/trxb202503290145
Abstract:
【Objective】Direct application of soil amendments represents a crucial approach for ameliorating acidic soils. Grasping the fundamental properties of commercially available acidic soil amendments is vital for developing strategies to improve acidic soils in China. 【Method】In this study, detailed information regarding product registration and patent applications for acidic soil amendments in China was gathered and systematically organized. Subsequently, the basic properties; including particle size distribution, pH, contents of CaO and MgO, crystalline minerals, and functional groups, of 24 randomly selected commercial soil amendments were determined. The crystalline minerals and functional groups of soil amendments were identified by X-ray diffraction (XRD) and Fourier-transform infrared spectroscopy (FTIR) analyses. 【Result】The results indicate that a substantial number of acidic soil amendments exist in China, accounting for 78% of all types of soil amendments. Driven by market demand, raw material availability, and agricultural development characteristics, the manufacturers of acidic soil amendments are predominantly located in Guangdong and Shandong provinces. The authorization rate of patents for acidic soil amendments in China is less than 10%. Among the authorized patents, the primary raw materials are organic matter and by-products from industry and agriculture, followed by natural minerals and chemical products. Specifically, the main raw materials listed in product registrations were carbonate minerals and oyster shells and most of the amendments were available in powder and granular forms, with a product registration ratio of approximately 2:1. However, the adoption of the powder products face challenges in promotion due to dust generation during application. The pH value, CaO content, and MgO content are the core indicators that most effectively reflect the ability of acidic soil amendments to mitigate soil acidity and replenish soil base nutrients. Even though some of the soil amendments did not fully disclose these three parameters on their packaging, the experimental evidence indicated that they were highly alkaline and exhibited high pH values and CaO contents, and most products also contained small amounts of MgO. These measured indicators aligned with their labeled values or ranges and the XRD and FTIR analyses further demonstrated that the predominant component in the commercially available amendments was CaCO₃. In addition, other alkaline constituents such as Ca(OH)₂, CaO, CaMg(CO₃)₂, and MgO were also present in some of the soil amendments, depending on their raw materials and production technologies. Moreover, most of the amendments also contained silicate minerals or SiO₂. 【Conclusion】The results of this study revealed that the primary function of the commercially available amendments for acidic soils in China is the amelioration of soil acidity. However, due to the single functionality of these products, there are significant challenges in market promotion. To meet the diversified needs of agricultural production, it is necessary to further develop multi-functional acidic soil amendment products that can both regulate soil acidity and enhance soil fertility, thereby improving product practicability and market competitiveness. In addition, acidified soil amelioration is a systematic project. Besides strengthening the development of new products, it is also necessary to simultaneously advance various aspects of work such as soil acidification monitoring and early warning, and integration of acidified soil improvement technologies and models, in order to effectively promote the improvement and sustainable utilization of China""s acidic cultivated land.
-
Origins of Mineral-associated Organic Carbon (MAOC) Under Long-term Fertilization in a Vertisol
YU ZiZhou, GUO ZiChun, DING TianYu, WANG DaoZhong, HUA KeKe, GUO ZhiBin, GAO Lei, PENG XinHua
DOI: 10.11766/trxb202503120112
Abstract:
【Objective】Mineral-associated organic carbon (MAOC) constitutes the largest and most stable fraction of soil organic carbon (SOC), and increasing its proportion is essential for improving soil quality. Although long-term fertilization has significantly increased the MAOC proportion in SOC in Shajiang black soil, the accumulation patterns of plant- and microbial-derived carbon within MAOC, as well as their relative contributions to SOC, remain unclear. Therefore, this study aims to explore the accumulation characteristics of plant- and microbial-derived carbon and their contribution to MAOC in the 0-20 cm soil depth of Shajiang black soil under long-term fertilization. 【Method】Based on a 34-year field experiment, four treatments were established (no fertilizer and wheat straw return as CK, mineral fertilizer as NPK, mineral fertilizer with half amount of wheat straw return as NPKLS, and mineral fertilizer with full amount of wheat straw return as NPKHS). Biomarkers and chemometric methods were used to investigate the effects of long-term fertilization on plant and microbial-derived carbon in MAOC. 【Results】The results reveal that compared to CK treatment, NPKHS and NPKLS treatments significantly increased the content of MAOC by 29.6% to 54.3% (P < 0.05), with MAOC exhibiting a significant linear positive correlation with SOC (R² = 0.95, P < 0.05) and carbon input (R² = 0.98, P < 0.01). In terms of plant-derived components, the NPKHS treatment induced an increase of 14.8% and 13.3% in the contents of Vanillyl (V) and Syringyl (S) phenols, respectively, while the S/V and C/V ratios decreased by 1.27% to 9.46%. However, the differences in the acid-to-aldehyde ratios (Ad/Al)V and (Ad/Al)S were not significant (P > 0.05). For microbial-derived components, NPKHS treatment significantly elevated the amino sugar content, with an increase of up to 91.4% compared to the control (P < 0.05). Specifically, the contents of fungal residual carbon (FNC) and bacterial residual carbon (BNC) increased by 92.7% and 48.5%, respectively, with fungal necromass dominating (FNC/BNC=4.39). Biomarker analysis indicated that the microbial-derived carbon contribution rate was as high as 72.6% to 73.4%, whereas chemometric methods suggested that the plant-derived carbon contribution ranged from 74.0% to 82.6%. Compared to previous studies on grassland/forest ecosystems (53% to 65%), this proportion appears somewhat unreasonable, suggesting that the chemometric method may have overestimated the contribution from plant sources. 【Conclusion】Our findings indicate that long-term fertilization enhances the accumulation and stability of MAOC in Shajiang black soil primarily by increasing microbial-derived carbon content. This study provides an important reference for the efficient utilization of straw resources and for improving the quality of cultivated land in the Shajiang black soil region.
-
Long-Term Natural Aging Behavior of Polyvinyl Chloride and Polyamide Microplastics in Soil
XU Zehua, NI Zifan, ZHOU Shiyin, CUI Min
DOI: 10.11766/trxb202505220234
Abstract:
【Objective】Microplastics are ubiquitous in environments, posing potential threats to ecosystems. As a persistent contaminant, they can undergo aging during prolonged environmental exposure. Aging alters the physicochemical properties of microplastics, thereby modulating their environmental fate and ecological risks. Considering that various environmental factors, including radiation intensity, medium type, humidity, and temperature, play a critical role in the aging process of microplastics, it is evident that the natural aging behavior of microplastics differs significantly from that observed under controlled laboratory aging simulations. However, research on long-term natural aging of microplastics remains limited.【Method】In this study, two typical microplastics, polyvinyl chloride (PVC) and polyamide (PA), were selected. A multi-environment exposure system encompassing atmospheric, topsoil (0 cm), and subsurface soil (10 cm) environments was established to conduct a 12-month natural aging experiment. The physicochemical properties of microplastics before and after aging were characterized using microscopic, spectros-copic, and thermogravimetric techniques, combined with chemical and thermal degradation approaches to evaluat- the stability of aged microplastics.【Result】The results showed that the natural aging behaviors of PVC and PA microplastics differed significantly and were closely dependent on environmental conditions. Specifically, sunlight-induced photo-degradation was the primary natural aging pathway for PVC microplastics. This process was characterized by significant changes in their physicochemical properties, including the formation of oxygen-containing functional groups, the generation of conjugated bonds, and the cleavage of the polymer backbone. These reactions resulted in notable alterations in surface morphology, color, and particle size. Concurrently, atmospheric-exposed PVC microplastics exhibited a significant decrease in stability, as demonstrated by a lower pyrolysis temperature and a higher oxidative degradation rate. In contrast, soil-exposed PVC microplastics (both topsoil and subsurface) exhibited comparable aging levels. While PVC microplastics on the soil surface were also exposed to sunlight, surface attachment to soil particles and the shading effect of plants significantly reduced the extent of their photoaging. Consequently, due to the absence of sunlight-induced photo-aging, the aging level of soil-exposed PVC microplastics was lower than that of atmospheric-exposed PVC microplastics. This suggests that PVC microplastics demonstrate greater persistence in soil environments over extended periods. Atmospheric-exposed PA microplastics underwent marked photodegradation, exhibiting a significant decrease in particle size (P < 0.05). However, carbonyl index (CI) and stability analyses revealed equivalent aging levels between atmospheric- and soil-exposed PA microplastics. This finding is inconsistent with the behavior of PVC microplastics, suggesting that PA microplastics can undergo relatively significant aging even in soil environments lacking direct sunlight exposure.【Conclusion】This multi-environment aging study elucidates the divergent aging behaviors of PVC and PA in natural settings. These findings provide theoretical foundations for refining risk assessment frameworks and optimizing laboratory aging simulations for both microplastic types.
-
Dermal Uptake and Elimination of Europium-Labeled Nanoplastics in Earthworms
YANG Yu, ZHANG Jun, SU Yu, JI Rong
DOI: 10.11766/trxb202506030255
Abstract:
【Objective】The accumulation of nanoplastics (NPs) in soils poses potential threats to earthworm health. As key indicator species in soil ecosystems, earthworms play a crucial role in assessing the ecological risks associated with soilborne NPs. However, the quantification of NPs in complex biological and environmental matrices has remained a major challenge, limiting progress in this research field. Therefore, a comprehensive understanding of the absorption and excretion process of NPs by earthworms is essential for accurate exposure risk assessment.【Method】In this study, europium-labeled polystyrene nanoparticles were utilized as model NPs to quantitatively investigate the absorption, distribution, and excretion kinetics of NPs in earthworms. The organisms were exposed to the nanoparticles via three distinct administration routes: topical application onto the epidermis, direct injection into the body cavity, or introduction into the soil medium with or without oral exposure restriction (mouth sealing).【Result】Skin exposure experiments demonstrated that NPs were capable of penetrating the earthworm epidermal barrier, with absorption kinetics exhibiting a biphasic pattern: an initial rapid phase (0-3 h), primarily driven by concentration gradient–mediated passive diffusion, followed by a slower phase (3-24 h), significantly impeded by the resistance of the epidermal mucus layer and NP aggregation. Body cavity exposure studies revealed that NPs excretion via the skin also followed a biphasic pattern, characterized by rapid clearance (28.7% ± 1.4% within 3 h) and subsequent slow attenuation. The skin exudation rate was markedly lower than the penetration rate, indicating that the skin predominantly functions as an absorptive interface during NPs metabolism. Integrated sealing experiments further clarified the time-dependent shift in NPs uptake pathways: cutaneous absorption dominated during the early exposure phase (<3 h), accounting for 70.3%, whereas dietary intake became predominant after 24 h, contributing 62.5%. Notably, dermal penetration efficiency exhibited a clear dose-dependent trend, with NPs displaying organ-specific accumulation patterns in earthworms, the intestine being the primary target organ. These findings demonstrate that nanoscale plastic particles are capable of traversing the epidermal barrier of earthworms, undergoing trans-epidermal transport from the outer layer to internal tissues, as well as retrograde exudation from the inner epidermis. The significantly higher skin penetration rate compared to the exudation rate suggests that the epidermis primarily functions as an absorptive interface during NPs metabolism. Under conditions of reduced or ceased feeding activity, dermal absorption emerges as the predominant pathway for NPs uptake and accumulation in earthworms, which can be attributed to the prolonged dermal exposure to NPs in the surrounding soil environment.【Conclusion】This study highlights dermal penetration as a critical yet previously underestimated route for the uptake of NPs in earthworms, thereby providing a robust scientific basis for refining ecological risk assessment models of soilborne nanoparticles. It also contributes valuable theoretical insights into the biogeochemical cycling of NPs within soil ecosystems.
-
Effects of Sheep Manure Combined with Wood Vinegar on Nutrients in Saline-alkali Soil and Salt Tolerance of Winter Wheat
QIE Ying, LI Yihong, WANG Guangen, JIANG Longgang, LI Dongxiao, ZHANG Yuechen, GUO Li
DOI: 10.11766/trxb202503030099
Abstract:
【Objective】This study aimed to explore the effects of applying different amounts of wood vinegar in combination with sheep manure on the improvement of saline-alkali soil in the low plain of Hebei and the salt tolerance of winter wheat from 2022 to 2024. 【Method】There were five treatments including conventional fertilization (CK), sheep manure at 27 t?hm-2 (T0), T0 + wood vinegar at 270 kg?hm-2 (T1), T0 + wood vinegar at 540 kg?hm-2 (T2), and T0 + wood vinegar at 810 kg?hm-2 (T3). The effects of the combined application of sheep manure with different amounts of wood vinegar on soil nutrients, salt tolerance characteristics of winter wheat, nutrient absorption and utilization, and yield were analyzed. 【Result】The results showed that at soil depth of 0-20 cm, the soil bulk density and electrical conductivity value under T2 treatments were significantly reduced by an average of 8.03% and 13.17% compared with CK (P < 0.05), while the total porosity, organic matter and available potassium contents significantly increased. The nitrate nitrogen content and available phosphorus under T2 were significantly increased compared with CK and T0. At a soil depth of 20-40 cm, the content of available phosphorus under T2 was significantly increased compared with CK. Compared with CK, T0, and T1, the content of soluble sugar and the activity of superoxide dismutase (SOD) at each filling stage, the soluble protein content and the activity of peroxidase at the early and middle filling stages, and the free amino acid content at the early filling stage in the flag leaf of T2 were significantly increased. Also, the content of superoxide anions radicals showed an opposite trend to the SOD activity while the total accumulation of nitrogen, phosphorus, and potassium under T2 in the aboveground part was significantly increased by 8.30% to 25.79% compared with CK, T0, and T1. The stomatal characteristic parameters of the flag leaf under T2 were significantly increased compared with CK, among which the stomatal size of the flag leaf under T2 was significantly increased by 21.23% compared with CK. Moreover, the yield of winter wheat under T2 treatment was significantly increased by 5.93% to 17.29% compared with CK, T0, and T1. Using mathematical modeling, it was observed that the optimal dosage of wood vinegar liquid following a simulation for a two-year period was close to the application amount of 540 kg?hm-2 of wood vinegar. 【Conclusion】Based on these results, it was recommended that the optimal amount of sheep manure to be applied should be 27 t?hm-2 while the amount of wood vinegar should be in the range of 535.46-551.03 kg?hm-2. This, could contribute to mitigating the negative impacts of saline-alkali soils and enhance winter wheat productivity in this region.
-
Revealing the Interaction Characteristics Between Selenomethionine and Iron Oxides over Surface Spectroscopy - Energy Spectrum Technique
WANG Rui, LIU Xin, HOU Ruicheng, YANG Hui, YANG Shunping, SHEN Xuele, LONG Ting, XIANG Wenjun, WEI Shiyong, TAN Wenfeng
DOI: 10.11766/trxb202503240131
Abstract:
【Objective】Organic Se is an important component of total Se in soil, and selenomethionine exists as one of the most common species among the organic Se. Given that the interfacial interaction between iron oxides in soil and organic Se species remains elusive, this study provides an avenue for understanding the migration and transformation of Se coupling with Fe-cycling in soil. 【Method】 In this study, the interfacial interaction between selenomethionine and iron oxides, ferrihydrite, goethite, and hematite was investigated through the analysis of surface species, coordination structure of iron atom (Fe) and adsorption configuration over the X-ray photoelectron spectrum (XPS), X-ray absorption fine structure spectrum (XAFS), and attenuated diffuse reflection infrared spectrum (DRIFTS-IR). 【Result】The results revealed that the binding energy (B.E.) of N1s was decreased to 399.7 eV and it was maintained for the main Se species adsorbed on ferrihydrite. The coordination structure of first- and second-sphere for Fe atom of ferrihydrite before and after interacting with selenomethionine did not change, while there was an adsorbed carboxyl-species with bidentate coordination mode. This result suggested that selenomethionine could be adsorbed on ferrihydrite through the bidentate coordination mode with a vertical adsorption configuration over carboxyl on the surface of ferrihudrite. After interacting with selenomethionine, the B.E. of Fe for bulk FeO6 at the goethite sub-surface was reduced by 0.4 eV. Also, the distance of first-sphere and coordination number of outer spheres for Fe atom in goethite showed an obvious change, compared to that of the fresh goethite. It indicated that goethite had undergone an obvious dissolution accompanied by obvious reduction effect after interacting with selenomethionine. Moreover, the Se atom mainly existed as the oxidized species on goethite. There was a monodentate coordination mode for the adsorbed selenomethionine on goethite with a horizontal adsorption configuration. For hematite, the B.E. of Fe both at sub-surface and surface were reduced to 0.4 eV, while the coordination structure of Fe atom for the Fe-sphere did not change but shortened in the first-sphere. This phenomenon revealed a characteristic weak dissolution interaction and a strong reducibility for hematite interacted with selenomethionine. Owing to the reduction by selenomethionine, there was a strong surface-enhanced infrared absorption effect for the adsorbed selenomethionine. Besides, the amino N and Se atoms might directly participate in the chemical adsorption of selenomethionine on hematite. Among the three iron oxides, there was a similar oxidization pattern for Se during the interaction process and this observation can be summarized as: 1) the complete oxidization of selenomethionine into selenite and 2) the incomplete oxidization species of selenomethionine. 【Conclusion】The interaction characteristic and mechanism of selenomethionine with ferrihydrite, goethite, and hematite was carefully revealed through surface analysis. The results revealed a differential response for the surface structure of mineral and change of selenomethionine when it interacted with iron oxides with different surface structure and properties. These findings provide an important reference for understanding the migration and transformation of organic Se in soil under different Fe-cycling processes. It also provides guidance for the unitization of Se resource and remediation of Se pollution in Se-rich area.
-
The Theoretical Framework and Technical Pathway of
LI Guangjie, YU Zhen, WANG Chong, SHI Weiming, WANG Zhaoyue, LI Yan, ZHANG Lin, LIU Zhaohui
DOI: 10.11766/trxb202503050101
Abstract:
Saline-alkali land is an important agricultural land resource, and in recent years, China has adopted various improvement measures for the management of saline-alkali soil. However, the improvement and utilization of saline-alkali land still face challenges, including high costs, severe water resource constraints, poor stability of improved saline-alkali land with a tendency to revert, and the need for enhanced low-water-consumption and high-efficiency technical support. To address these significant issues, this study proposes the concept of "rhizosphere suitable microzones" (RSM) for crops in saline-alkali soils. Focusing on the problems of "difficult emergence and establishment" of crops in saline-alkali land, as opposed to the overall soil improvement strategy, it expounds the theoretical framework of RSM. RSM refers to creating a specific local environment with unique physical, chemical, and biological characteristics within the small space of plant root systems, which differs from the surrounding environment and can support specific biological communities or life activities. This study proposes the technical path construction concept centered around "activating soil to promote root growth, using ions to nourish roots, acidification to regulate roots, and biological agents to protect roots". This will be achieved through cross-innovation of multiple theories, including soil fertility enhancement with carbon addition and salt reduction, balanced nutrient supply for salt inhibition, physical structure optimization to eliminate compaction, and enhancement of rhizosphere biological functions. Thus, it depicts the exploration of the construction principles and technical paths of RSM from a systematic perspective. This study outlines the key directions and contents of research on RSM and saline-alkali land improvement, aiming to break through the technical bottlenecks of saline-alkali soil improvement and promote the development of related disciplines. Specifically, the study considers salt-tolerant high-value crop varieties as pioneers, promotes the migration of sodium ions in the rhizosphere through water regulation, and considers the research and development of the technical path of RSM for crops in saline-alkali soils. This is centered on new slow and controlled-release fertilizers supplemented by anti-salt, growth-promoting, and biological strengthening factors.
-
Cover Crop Rotations Enhance Biopore Structure in Shajiang Black Soil: A Multi-scale Investigation
DING Tianyu, GUO Zichun†, HUA Keke, ZHANG Hongxia, PENG Xinhua
DOI: 10.11766/trxb202504260193
Abstract:
【Objective】Biopores constitute a critical component of the soil pore network, exhibiting significantly greater efficiency in facilitating the transport of water, solutes, and gases compared to nonbiopores. However, quantitative analysis of biopores at a single scale exhibits significant limitations in resolving morphological characteristics, elucidating developmental dynamics, and evaluating functional attributes. 【Method】To comprehensively characterize soil biopores distribution patterns, this study integrated a 5-year rotational field experiment on lime concretion black soil with high-resolution X-ray computed tomography (CT) scanning. The investigation was conducted at three distinct scales: (1) large column scale (10 cm diameter × 20 cm height soil columns), (2) small column scale (5 cm diameter × 5 cm height soil cores), and (3) aggregate-scale (3-5 mm aggregates). We systematically examined the effects of different cropping systems - conventional wheat-maize rotation (WM) versus cover crop rotations (wheat-Cassia occidentalis: WY, and wheat-Cassia tora Linn.: WJ) - on biopore characteristics within the 0-20 cm soil layer. Furthermore, we critically evaluated the applicability of each scale for biopore network analysis. 【Results】This study developed an improved biopores segmentation protocol comprising three key steps: (1) initial classification of pores into connected and isolated networks, (2) application of 3D distance transform watershed algorithms to separate biopores and nonbiopores, and (3) implementation of a Random Forest classifier leveraging morphological feature parameters (blobness, sphericity, compactness, and plateness) for scale-specific biopores segmentation across all three observational scales. Compared to the WM treatment, the WY treatment significantly increased bioporosity by 237%, 243%, and 119% at the large column, small column, and aggregate scales (P<0.05), respectively. Similarly, the WJ treatment resulted in an increase of bioporosity by 111%, 217%, and 114% at the large column, small column, and aggregate scales (P<0.05), respectively. At the large column scale, biopores exhibited significantly larger diameters than those at small column and aggregate scales, with mean diameters ranging from 1,444-3,374 μm and maximum diameters reaching from 4,792-8,854 μm (P<0.05). This scale effectively captured the biopores network architecture and directly revealed vertical continuity patterns throughout the 0-20 cm plow layer. However, large column scale analysis showed limited detection capability for fine biopores (<60 μm in diameter), reflecting inherent resolution constraints of the methodology. The small column effectively identified medium-to-fine biopores (>30 μm) and primarily correlates with soil physical properties governing hydraulic conductivity and gas transport. Microscale aggregate analysis can resolve ultra-fine biopores (>6 μm in diameter), with quantitative characterization revealing these biopores occupy 21.6-34.4% of total aggregate porosity. Aggregate scale analysis provides critical insights into root-soil architecture interactions and reveals fundamental mechanisms of soil organic carbon physical protection within microhabitats. 【Conclusion】This study demonstrated that cover cropping significantly enhanced soil biopore networks across multiple scales. We propose that future research adopt integrated multiscale approaches to fully unravel the spatial distribution and temporal evolution of these biopore systems.
-
Study on the Potential of Manure Application for Carbon Sequestration in Cropland Soil Profiles
LI Tiantian, ZHU Qi, SHEN Lidong, ZHU Tianshen, ZHANG Jiakai, MA Yuchun, XIA Longlong
DOI: 10.11766/trxb202502260087
Abstract:
【Objective】Soil organic carbon (SOC) in cropland is an important component of the terrestrial ecosystem carbon pool. The application of organic manure, as a critical agricultural management practice, has been extensively validated to significantly enhance soil organic carbon (SOC) content and stock. However, Current research mainly focuses on the SOC fixation and mechanisms in the 0~20 cm surface soil layer, with little attention given to the carbon sequestration potential of deeper soil layers. 【Method】This study used a meta-analysis method to systematically analyze the impact of animal manure application on SOC distribution and stock in the soil profile of global croplands. 【Result】The results showed that the application of animal manure increased SOC stock in different soil layers. In the surface layer (0~20 cm), SOC stock increased from 28.3 t·hm-2 to 36.4 t·hm-2, with an increase of 28.6%. In the 20~40 cm layer, SOC stock increased from 23.6 t·hm-2 to 27.5 t·hm-2, with an increase of 16.5% while in the >40 cm layer, SOC stock increased from 45.6 t·hm-2 to 48.7 t·hm-2 (6.8%). The new SOC sequestration efficiency (NCE) was highest in the 0~20 cm layer (146.0%), significantly higher than in the 20~40 cm layer (117.2%) and the >40 cm layer (64.3%). Also, it was observed that soil carbon sequestration efficiency was co-regulated by both natural factors (annual mean temperature, annual mean precipitation) and anthropogenic factors (fertilizer type, nitrogen application rate, land use type, and application duration). Specifically, the impacts of annual mean temperature and annual mean precipitation on sequestration efficiency vary across different soil layers. Moreover, the combined application of animal manure and an appropriate amount of nitrogen fertilizer significantly enhanced SOC stock in the surface soil layer. 【Conclusion】This study provides a theoretical basis for developing differentiated carbon sequestration strategies based on soil profile characteristics. Furthermore, the study highlights the significance of optimizing agricultural management to enhance soil carbon stock, mitigate climate change, and achieve sustainable agricultural development.
-
Effects of Adding Polyamide Microplastics Simulating Natural Aging on Heavy Metal Adsorption in Guizhou Yellow Soil
LI Fupeng, HUANG Yaohao, HE Linfeng, XIAO Jinnan, YANG Xiuyuan, ZHANG Zhenming
DOI: 10.11766/trxb202501110023
Abstract:
【Objective】Microplastic and heavy metal pollution are global problems that threaten ecosystems and human health. Microplastics in soil can interact with soil particles and affect the physicochemical properties of soil, which in turn affects the behavior of heavy metals in soil. 【Method】This study systematically investigates the sorption-desorption behavior of polyamide (PA) microplastics toward cadmium (Cd2+), chromium (Cr3+), and copper (Cu2+) using Guizhou yellow soil as the research object. By simulating PA"s natural aging processes through multiple freeze-thaw cycles, high-temperature exposure, and oxidation, the aging mechanisms and adsorption mechanisms are elucidated. 【Result】The results showed that the adsorption process of PA on the three heavy metals could be divided into two stages: rapid adsorption (0-90 min), slow adsorption (90-150 min) and equilibrium adsorption (150 min), and the adsorption amount reached more than 99% of the saturation amount. Also, the kinetic behaviors conformed to the pseudo-second-degree model (R2 > 0.999), which indicated that chemosorption was the dominant mechanism. Moreover, the adsorption data fitted better the Langmuir model compared to the Freundlich model (R2 > 0.978), and PA significantly enhanced the adsorption capacity of Cr3+ from the soil (KL value increased by 59.1%). After 21 days of aging, PA surface roughness, crystallinity, specific surface area (+44.49%), and negative charge density (?36.53 mV) increased significantly, resulting in an increase in heavy metal adsorption (P < 0.05) and a decrease in desorption. The largest decrease in desorption was observed for Cd2+ (18.7%) and the smallest for Cr3+ (4.2%). Furthermore, carboxyl (?COOH) and hydroxyl (?OH) groups generated by oxidizing the PA surface during aging strengthened heavy metal immobilization through coordination and electrostatic interactions, whereas the increase in the proportion of crystalline regions further inhibited desorption. 【Conclusion】 This study reveals the mechanism of adsorption enhancement of soil heavy metals by aged PA, which provides a theoretical basis for the risk assessment and management of microplastic-heavy metal composite pollution in karst areas.
-
Microbial Mechanisms Underlying the Effects of Elevated Atmospheric CO2 Concentrations on Nitrogen Fixation Potential in Paddy Soils
WU Yanlin, HUANG Wei, HU Zhenghua
DOI: 10.11766/trxb202412250509
Abstract:
【Objective】?Biological nitrogen fixation?, which converts inert nitrogen into plant-available nitrogen, is a critical process for maintaining the soil nitrogen cycle and supporting the productivity of agroecosystems. However, the effect of atmospheric CO2 on biological nitrogen fixation in paddy fields remains poorly understood. Thus, this study aims to elucidate the microbial-driven mechanism of biological nitrogen fixation in paddy soils affected by elevated atmospheric CO2. The findings of this study will provide a scientific basis for the optimization of nitrogen cycling in paddy fields and sustainable nitrogen management in agriculture under climate change scenarios.【Method】In this study, we investigated the microbial-driven mechanism of biological nitrogen fixation in paddy fields by elevated atmospheric CO2 concentration. Two treatments, CK (ambient CO2 concentration) and EC (elevated ambient CO2 concentration by 200 μmol·mol?1) were set up by using an open-top chamber (OTC)-based platform for the automated control of CO2 concentration. Soil physicochemical properties, nitrogen fixation potential (NFP), and the abundance and community composition of nitrogen-fixing bacteria (nifH gene) of paddy soils were analyzed by microcosmic cultivation, real-time quantitative PCR, and high-throughput sequencing.【Result】The results showed that across the whole rice plant growth period and compared with CK, EC treatment significantly increased the microbial biomass nitrogen (MBN) content by 3.3% and significantly decreased the NH4+?N content by 11.6%. Also, the NFP and nifH gene abundance were significantly increased by EC treatment. At the maturity stage, the community structure of the nifH gene in the EC treatment changed significantly compared with CK. In addition, the TN content was positively correlated with NFP, which was regulated by soil MBN content, SOC content, and nifH gene abundance.【Conclusion】This study reveals that elevated atmospheric CO2 concentration increased soil MBN content and nifH gene abundance, enhanced NFP, and increased the nitrogen content of paddy soils.
-
Regulatory Mechanisms of Biochar and Diatomite on Nitrification Processes and Ammonia-Oxidizing Microorganisms in Coastal Saline Soils
Ma Lan, Wang Jie, Shan Yan, Wang Xiangyu, Song Yanjing, Li Junlin
DOI: 10.11766/trxb202501170036
Abstract:
【Objective】 Biochar and diatomite have gained considerable attention as soil amendments; however, their effects and underlying mechanisms on nitrification processes as well as ammonia-oxidizing archaea (AOA) and ammonia-oxidizing bacteria (AOB) in coastal saline soils remain poorly understood. 【Method】 A 42-day indoor incubation experiment was conducted using typical coastal saline soil from the Yellow River Delta. Five treatments were applied: control without fertilizer (CK), urea (U), urea with dicyandiamide (DCD), urea with diatomite (DE), and urea with biochar (BC). The effects of these treatments on soil nitrification were evaluated, and the abundance and community structure of AOA and AOB were analyzed using quantitative PCR and high-throughput sequencing. 【Result】 The results demonstrated that DCD significantly inhibited nitrification in the short term, with an inhibition rate of 73.1%, however, its inhibitory effect diminished over time. Biochar also showed short-term nitrification inhibition but subsequently promoted AOA abundance. In contrast, diatomite did not significantly inhibit nitrification but notably enhanced AOB abundance. Correlation analysis revealed that the amoA gene abundances of AOA and AOB exhibited significantly opposite regulatory effects on the nitrification process. AOA showed significant positive correlations with ammonium nitrogen (NH??-N) content and nitrification inhibition rate (NIR), but a significant negative correlation with nitrate nitrogen (NO??-N) content. Conversely, AOB demonstrated significant negative correlations with NH??-N content and NIR, but highly significant positive correlations with NO??-N content and net nitrification rate (NNR). Notably, the correlation between AOB and NNR was significantly stronger than that of AOA. Cluster analysis indicated that the community structures of AOA and AOB in the BC and DCD treatments were more similar, which may be related to the fact that both regulate the soil nitrogen transformation process and microbial activity. 【Conclusion】 This study elucidates the differential regulatory mechanisms of biochar and diatomite on ammonia-oxidizing microbial communities in coastal saline soils, offering a novel theoretical foundation for the amelioration of saline soils.
-
Polarization‐Induced Covalent Bonding between H+ and Surface O Atoms Promotes Clay Mineral Dissolution
TANG Yuting, XIAO Shuang, DING Wuquan, LI Hang, LIU Xinmin
DOI: 10.11766/trxb202501090018
Abstract:
【Objective】Dissolution reactions of clay minerals are one of the essential processes contributing to natural soil acidification and mineral weathering. However, the surface reaction mechanism of mineral dissolution remains unclear. 【Method】The strong electric field generated by the surface charges of minerals induces a new type of covalent bonding between the oxygen (O) atoms on the mineral surface and the hydrogen (H+) ions, a phenomenon known as polarization-induced covalent bonding (PICB). In this study, we selected montmorillonite (MMT), illite (ILI), and kaolinite (KLI) to explore the interfacial reaction mechanisms promoting the dissolution of clay minerals by PICB using mineral dissolution analysis and hydrothermal experiments. 【Result】The dissolution density of mineral elements increases with decreasing pH, and the initial stage of mineral dissolution aligns with three processes of chemical weathering: desalination, desilicification, and ferrallitization. The PICB significantly enhanced the H+ adsorption energy density (γH(0)), and the absolute value of γH(0) increased with the decrease of pH, indicating an interaction between H+ and the mineral. Also, the surface was stronger under low pH conditions, and a consistent critical pH of 3.0 was observed based on both the theoretical analyses of γH(0) and the dissolution density of mineral elements as a function of pH. At a pH < 3.0, the PICB was significantly enhanced, resulting in a notably weakened Si-O bonding energy and a substantial increase in the dissolution efficiency of silicate minerals. Although the dissolution behaviors of various minerals exhibited significant variations in response to pH, they can be described as a function of γH(0), indicating that γH(0) has an important influence on the structure of clay minerals. Moreover, the enhancement of γH(0) resulted in a higher content of SiO2 in the hydrothermal reaction products of MMT, accompanied by a subsequent reduction in the residual products represented by Al2O3. 【Conclusion】This study quantified the impact of H+-mineral bonding on the chemical weathering of minerals and revealed that the PICB between H+ and surface O atoms of minerals enhanced the γH(0) of H+ on the mineral surface and weakened the Si-O bond energy, thus significantly affecting the dissolution reactions of clay minerals. The results of this study provide theoretical insights for proposing targeted modulation techniques aimed at enhancing the structural stability of minerals.
-
Variation Characteristics and Accumulation Mechanism of Organic Matter Molecular Components in Soil Aggregates Under Long-Term Rice Cultivation
Liu Tao, Wang Ping, Liu Yalong, Wang Jingkuan
DOI: 10.11766/trxb202408270343
Abstract:
Abstract: 【Objective】 As important carbon sources and sinks in terrestrial ecosystems, the accumulation process of paddy soil organic matter (SOM) is relatively well understood. However, changes in the molecular composition of SOM within soil aggregates and the mechanisms underlying SOM accumulation remain unclear.【Method】This investigation employed a paddy soil chronosequence in Cixi, utilizing Fourier Transform Infrared Spectroscopy (FTIR) and three-dimensional excitation-emission matrix fluorescence spectroscopy (3D-EEM). These methods were implemented to elucidate the variation patterns of SOM molecular components across different aggregate sizes and their contributions to SOM sequestration processes within the paddy chronosequence.【Result】Our findings revealed distinct temporal patterns in soil organic carbon (SOC) dynamics. Both macroaggregates (>250 μm) and microaggregates (<250 μm) exhibited rapid SOC accumulation within the initial century, followed by a gradual stabilization. Aliphatic SOM components demonstrated a substantial decrease from 12%-13% to 1% within the first 100 years of rice cultivation, while aromatic SOM components showed a progressive increase from 16%-17% to 30%-38%. In dissolved organic matter (DOM) fractions, tryptophan-like DOM increased from 16%-17% to 33%, whereas fulvic acid and humic acid components decreased from 41%-42% to 36%-37% and 31%, respectively, subsequently maintaining relative stability. The fluorescence index (FI) and autochthonous index (BIX) of DOM displayed an initial increase followed by a decrease, while the humification index (HIX) showed the opposite trend. These observations suggest an initial period of microbial activity characterized by high metabolic substance content, followed by microbial community stabilization and continuous production of complex humic substances during prolonged rice cultivation.【Conclusion】Despite relatively minor differences in SOC molecular components across various aggregate sizes under extended rice cultivation, our results substantiate that SOC accumulation in paddy fields is influenced not only by chemical adsorption and physical protection within soil aggregates but also significantly by microbial transformations. These findings contribute to a comprehensive understanding of SOC accumulation mechanisms in paddy soils and provide valuable insights for enhancing soil fertility sustainability.
-
Sustainable Utilization of Cadmium-Contaminated Soil: Safe Utilization Strategies Based on Mechanisms of Plant Cadmium Accumulation
HUANG Jiu, HU die, GAO Yongqiang, CHEN Changzhao, JIANG Mengmeng, WANG Haoyu, ZHONG Chongwei, ZHENG Lu, SHEN Rengfang, ZHU Xiaofang
DOI: 10.11766/trxb202502260089
Abstract:
Objectives: Cadmium contamination poses a significant threat to agricultural production and human health due to its persistence, toxicity, and potential to accumulate in crops and the food chain. However, there is a need for a comprehensive review that provides scientific guidelines for understanding Cd soil-solution chemistry, decreasing Cd levels in the food chain, and bridging the gap between laboratory research and field applications. Methodology: This study conducted an in-depth literature analysis of both laboratory and field research to provide a comprehensive analysis of the soil chemistry of cadmium, which is crucial for understanding its bioavailability and mobility. Results: The chemical behavior of Cd in soil is influenced by various factors, such as soil pH, organic matter content, and redox conditions. These factors determine the speciation of Cd, which in turn affects its uptake by plants and its potential to enter the food chain. The phytotoxic effects of Cd are manifold, impacting plant growth, physiological functions, and metabolic processes. Cd can suppress plant growth by inhibiting root and shoot development, reducing chlorophyll content, and disrupting photosynthesis. It also induces oxidative stress by increasing the production of reactive oxygen species (ROS), which can damage cellular components such as lipids, proteins, and DNA. The review also sheds light on the molecular mechanisms underlying plant responses to Cd stress. Two major molecular systems are highlighted: metal transporter families and regulatory transcription factor families. Metal transporters, including Nramp, HMA, ZIP, ABC, and YSL, play essential roles in Cd uptake from the soil, translocation from roots to shoots, and detoxification within plant cells. These transporters facilitate the movement of Cd through cellular membranes and into subcellular compartments, such as vacuoles, where it can be sequestered to reduce its toxicity. On the other hand, transcription factors like WRKY, MYB, bHLH, and NAC regulate the expression of genes involved in Cd tolerance and detoxification. They activate defense mechanisms that help plants mitigate Cd-induced oxidative damage and maintain cellular homeostasis. Based on the understanding of these molecular mechanisms, the review proposes innovative strategies for the sustainable utilization of Cd-contaminated soils. These strategies integrate molecular design approaches, such as engineering transporters to limit Cd uptake and enhance its sequestration, with phytoremediation techniques that utilize metal-tolerant plant species. By providing scientific guidelines for reducing Cd levels in agricultural products and enhancing food safety protocols, this study bridges the gap between laboratory research and field applications. It offers valuable insights for developing environmentally sustainable agricultural practices in regions affected by Cd pollution, thereby contributing to global food security and environmental protection. The proposed approaches not only aim to decrease Cd accumulation in crops but also seek to improve the overall health and productivity of plants grown in contaminated soils, ensuring safer food supplies for the growing global population. Furthermore, the review emphasizes the importance of these strategies in mitigating the adverse effects of Cd contamination on soil fertility and ecosystem health. By reducing Cd levels in soil and crops, these strategies can help maintain soil fertility, protect biodiversity, and promote the overall health of ecosystems. Conclusion: The integration of different approaches can lead to the development of more resilient agricultural systems that can withstand the challenges posed by Cd contamination and other environmental stresses. This comprehensive review thus provides a foundation for future research and practical applications aimed at addressing the complex issue of Cd pollution in agricultural environments.
-
Change characteristic of Soil Organic Carbon and Its Fractions during the Natural Restoration of Cultivated Black Soil
wuyanan, ZOU Wenxiu, WANG Shouyu, LU Xinchun, Han Xiaozeng
DOI: 10.11766/trxb202503140117
Abstract:
【Objective】The restoration of cultivated land to natural grassland can increase soil organic carbon (SOC) content. This study aimed to investigate the changes in black soil organic carbon during vegetation restoration.【Method】Based on a 19-year long-term field experiment, the temporal dynamics of SOC and its fractions were examined during the restoration of cultivated black soil to natural grassland vegetation (GL), with comparisons made to continuous cultivated land (CL) and bare land (BL) without vegetation cover.【Result】The results showed that: (1) Compared to the initial soil, the SOC content in the topsoil (0-20 cm) increased by 26.19% in the GL treatment, with an annual growth rate of 1.38% (0.41 g·kg-1·a-1). In contrast, the SOC content decreased by 7.99% in the BL treatment, while no significant change was observed in the CL treatment; (2) Across the entire 0-100 cm soil profile, GL not only significantly increased the SOC content in the topsoil (0-20 cm), but also increased the SOC content in the subsoil layers (20-60 cm). The increments in the 0-20, 20-40 and 40-60 cm layers were 26.19%, 12.08% and 8.70%, respectively. However, no significant changes in SOC content were observed below 20 cm in the CL and BL treatments; (3) Compared to the initial soil, the GL treatment increased the carbon contents of free light fraction (fLFC), occluded light fraction (oLFC) and heavy fraction (HFC) by 199.45%, 112.83% and 12.00%, respectively. Additionally, GL increased the proportions of fLFC and oLFC while reducing the proportion of HFC in the SOC; (4) For humus fractions, the GL treatment increased the contents of fulvic acid (FA), humic acid (HA) and humin (HM) by 74.82%, 29.69% and 11.46%, respectively, and decreased the HA/FA ratio, indicating a reduction in the humification degree of soil organic matter.【Conclusion】In conclusion, long-term restoration of cultivated land can effectively increase the organic carbon content of black soil and promote the accumulation of labile SOC fractions.
-
Effects of Tire Wear Particles on Soil Fertility and Physicochemical Properties: The Role of Typical Aging Patterns in the Environment
LI Kun, YE Zidong, CHEN Zhangle, LI Weiyi
DOI: 10.11766/trxb202410300414
Abstract:
【Objective】Tire wear particles (TWPs) are key sources of microplastic pollution, and their long-term impact on human health and the environment is receiving increasing attention. 【Method】This study investigated the release of heavy metals and sulfur from TWPs in soil, as well as their effects on soil physicochemical properties and fertility. It was also explored the role of different aging processes (photo-aging, lake water aging, and snowmelt water aging) on the properties of TWPs and their effects on soil fertility. Through laboratory simulations, fresh and aged TWPs were prepared and incubated in soil for various periods. 【Result】The results indicated that aging significantly altered the physicochemical properties of TWPs, including surface morphology, functional groups, and specific surface area, which in turn affected their heavy metal and sulfur release behavior in soil. After the addition of TWPs to the soil, a decrease in soil organic matter (OM) content was observed, although the impacts on cation exchange capacity (CEC) and pH were minimal. At the same time, TWPs significantly increased the content of available phosphorus and alkali-hydrolyzable nitrogen in the soil, with a slight impact on available potassium. The effects of TWPs on soil physicochemical properties and fertility varied under different aging processes, with photo-aging and snowmelt aging showing the most pronounced effects. Pearson correlation analysis revealed a significant internal relationship between the physicochemical properties of TWPs and the soil response. As TWPs were incubated in soil for longer periods, their adverse effects on soil fertility indicators, especially OM, gradually intensified. Furthermore, TWPs may interfere with soil nutrient cycling, particularly nitrogen cycling, by affecting CEC. 【Conclusion】This study provides important insights for understanding the long-term ecological impact of TWPs on soil and offers a basis for accurate risk assessment.
-
The Impact of Cover Crops on Organic Carbon and Microbial Community in Biopore Sheaths of Shajiang Black Soil
Xiewanyu, Liushuai, Guozichun, Gaolei, Chenyan, Shenxintao, Zhangzhongbin, Pengxinhua
DOI: 10.11766/trxb202412300513
Abstract:
【Objective】Cover crops are very important for regulating soil structure and enhancing soil organic carbon. Cover crops can improve soil pore structure by creating biopores through root penetration and subsequent decomposition. However, the effects of different cover crops on organic carbon accumulation and microbial communities in biopore sheaths remain unclear. 【Method】A field experiment was conducted in a typical Shajiang black soil, including four winter cover crop treatments (fallow, alfalfa, rapeseed, and a mixture of radish + hairy vetch) in rotation with summer maize. Soil organic carbon (SOC) and total nitrogen (TN) contents in the biopore sheaths of the 20–40 cm soil layer under different treatments were determined, while bacterial and fungal community structures were analyzed via high-throughput sequencing. 【Result】The results showed that, compared with bulk soil, SOC content in the biopore sheaths increased significantly by 33.4% under the alfalfa treatment, while TN content increased significantly by 24.6% and 18.5% under the alfalfa and radish + hairy vetch treatments, respectively. However, no significant differences in SOC and TN contents of the biopore sheath were observed among different cover crops. The microbial community structure varies significantly with the interaction between cover crop species and soil habitats. The bacterial α-diversity indices and niche breadth indices in biopore sheaths were significantly higher than those in bulk soil, particularly in the radish + hairy vetch treatment, whereas no significant differences were observed in fungal communities between the two soil compartments. Furthermore, microbial communities within biopore sheaths exhibited a shift toward copiotrophic taxa compared with bulk soil. The relative abundance of Pseudomonas and Bacillus was higher in alfalfa-derived biopore sheaths than in other treatments. Correlation analysis indicated that the relative abundance of core microbial taxa involved in carbon decomposition and transformation was significantly positively correlated with SOC content. 【Conclusion】In summary, SOC and TN contents in the biopore sheaths under the alfalfa treatment significantly increased. SOC content may regulate microbial community structures within biopore sheaths by influencing bacterial α-diversity indices, niche breadth indices, and the relative abundance of core microbial taxa.
-
Effects of Different Biomass Materials on the Physicochemical Properties and Water-Salt Transport Characteristics of Saline-Alkali Soil
sunyan, liujianqi, wujianxin, fengzhenlong, liuxianhe, huzifu, ye jin hao
DOI: 10.11766/trxb202409300379
Abstract:
【Objective】Salinization leads to a decline in soil fertility and reduced agricultural productivity, significantly limiting the high-quality development of arid region agriculture. Bioorganic materials have shown promising effectiveness in land reclamation for salt-alkali-affected areas. 【Method】The effects of adding different biomass materials (8‰ biochar (B), 8‰ biochemical fulvic acid (BF), and a mixture of 4‰ biochar and 4‰ biochemical fulvic acid (BBF)) on the physicochemical properties and water-salt transport characteristics of soda saline-alkali soil was investigated, through one-dimensional vertical infiltration experiments. Each layer of soil was completely mixed with bioorganic materials and subjected to an equal volume treatment. 【Result】The results showed that the application of biochar and biochemical fulvic acid both significantly reduced soil bulk density and increased porosity, with significant differences between treatment B and other treatments (P<0.05). Under the same infiltration time,the wetting front depth of B, BF, and BBF treatments was significantly smaller than that of the CK, with the BF treatment showing the smallest wet front migration depth. Both the Kostiakov and Philip models could effectively simulate the infiltration process, and the infiltration rate (S) showed a variation pattern of CK > B > BBF > BF. The B, BF, and BBF treatments significantly increased the soil volumetric water content in the 0-15 cm soil layer, with significant differences among the treatments (P<0.05). At the 15 cm soil depth, the soil salt content in the B, BF, and BBF treatments was higher than that in the CK, and the soil salt content in the 20-30 cm soil layer gradually increased with depth. The BF treatment showed the most significant effect on salt content. Also, the soil pH in all treatments was lower than the initial pH, but in the 0-15 cm soil layer, the pH of the B, BF, and BBF treatments was higher than that of the CK. Additionally, the concentration of soil salt ions in the 0-15 cm soil layer was higher compared to CK, especially the water-soluble Na+ concentration, which significantly increased. 【Conclusion】The result indicates that bioorganic materials, such as B and BF, exhibit significant effects in land reclamation for salt-alkali affected areas by significantly reducing soil bulk density and increasing porosity. Additionally, these materials decreased infiltration rates while enhancing cumulative infiltration, though increased Na? concentrations may affect long-term outcomes. Therefore, when improving salt-alkali soils, emphasis should be placed on considering the physical properties of bioorganic materials. It is recommended to select materials with suitable physical properties and low sodium content, followed by salt leaching treatments, to optimize land reclamation efforts.
-
Effects of Improvement Measures on Aggregate Stability and Humus Composition of Soda Saline Meadow Soil
lisiyan, liangxiaoyan, wangchen, wangyuqing, xiewei, yangdi, zhangmingcong
DOI: 10.11766/trxb202501060011
Abstract:
【Objective】This study was aimed to investigate the regulation mechanisms of different improvement measures on soil structure and humus characteristics of soda saline-alkali land.【Method】A field comparative experiment was conducted to study the effects of conventional (CK), biochar (T1), organic fertilizer (T2), and structural modifier (T3) on aggregate stability, humus composition, and soybean yield in soda saline meadow soil.【Result】The results showed that compared with CK, T1, T2 and T3 treatments significantly promoted the transformation of microaggregates to macroaggregates. The effect of T3 treatment was the most significant, and the mass fraction of >2 mm aggregates increased by 12.66% (P<0.05), which was significantly higher than that of T1 and T2. T3 treatment significantly improved nutrient availability by reducing soil pH by 3.02% and simultaneously increasing available phosphorus (67.84%) and alkali-hydrolyzable nitrogen (7.98%) content. The average weight diameter and geometric mean diameter of soil increased by 7.99% and 2.39%, respectively, and the organic carbon content of microaggregates (0.053-0.25 mm) increased by 24.58%-31.14%, which was significantly higher than other treatments. In terms of humus components, the contents of humic acid, fulvic acid, and humin in each particle size of T3 treatment increased by 19.95%-29.62%, 3.64%-6.48%, and 7.33%-36.92%, respectively, which were better than those of T1 and T2 treatments. T3 treatment significantly increased the complexity of humus, and the ratio of E4/E6 significantly increased by 84.84%. The PLS-PM structural equation model revealed that soil organic carbon (path coefficient 0.96) significantly affected aggregate stability by regulating total humic acid (1.13) and humin (1.29). Yield analysis showed that T3 treatment achieved a soybean yield of 2653.97 kg·hm-2 by increasing plant height (61.32%) and pod number per plant (11.96%), with an increase of 42.67%.【Conclusion】The results showed that the compound modifier (T3) complicated the molecular structure of large-grained aggregates by reconstructing the molecular structure of humus, promoted the increase of cementing materials, increased the content of organic carbon, significantly increased the mass fraction of aggregates with >2 mm particle size and the stability of soil aggregates, and effectively improved the soil structure of the plough layer of soda-saline meadow soil. This provides a theoretical basis for the improvement of soda saline-alkali land and the synergistic improvement of production capacity.
-
Effects of Bridge Construction on Mangrove Soil Fungal Diversity and Co-Occurrence Networks
GAO Guifeng, MA Cheng, YAN Subo, SONG Luyao, CHU Haiyan
DOI: 10.11766/trxb202412090480
Abstract:
【Objective】Bridge construction strongly affects the structure and function of soil microbial communities in coastal wetlands. However, its specific impacts on mangrove soil fungal communities have not been given much attention. This study aimed to investigate the impacts of bridge construction on mangrove soil fungal communities, focusing on two common construction methods (Steel casing pipe, SC; Sheet pile cofferdam, SP) compared to undisturbed areas (UD), providing insights for ecological conservation and sustainable management.【Method】Soil fungal communities across SC, SP, and UD habitats were investigated using high-throughput sequencing, functional guild annotation, and co-occurrence network analysis. Key soil properties were measured to identify environmental drivers.【Result】The results showed that the main fungal biomarkers in the soils of the UD and SC habitats were Ascomycota, whereas the SP habitat was dominated by Basidiomycota. Also, the species richness of the soil fungi in the SP habitat was significantly (P < 0.01) higher than that in the SC and UD habitats. In addition, the species richness of saprotrophic fungi was significantly (P <0.05) higher in SP than in SC and UD, and the relative abundance of saprotrophic fungi was significantly (P < 0.05) higher in SC than in UD. The soil C/N ratio, TN, and pH were the main environmental drivers affecting fungal guilds. Fungal co-occurrence network analysis showed that the network complexity (avgK = 1.94) was higher in the UD habitat than in the SC and SP habitats.【Conclusion】This study reveals that bridge construction methods differentially alter mangrove soil fungal communities through soil physicochemical alterations. These findings highlight the need for method-specific environmental assessments and offer a scientific basis for balancing coastal wetland conservation with construction activities.
-
Effect of Organic Substitution on Crop-Soil-Microbial Stoichiometric Characteristics and Soil Phosphorus Morphology
HUA Mingxiu, HU Can, CHEN Hao, CHEN Guanglei, WANG Lei, WANG Shenqiang, WANG Yu
DOI: 10.11766/trxb202412120486
Abstract:
【Objective】To address the limited understanding of the nutrient stoichiometric relationships among crops, soil, and microorganisms under different proportions of organic fertilizer substitution for chemical fertilizers in a rice-wheat rotation system.【Method】 This study utilized a five-year field experiment at the Yixing experimental site of the Changshu Agro-Ecological Experimental Station, Chinese Academy of Sciences, five treatments were established: no phosphorus fertilizer (CK), conventional chemical phosphorus fertilizer (CF), 30% substitution of chemical phosphorus fertilizer with organic fertilizer (TM), 50% substitution (FM), and 100% substitution (HM). The aim was to investigate the effects of organic fertilizer substitution on crop-soil-microorganism stoichiometric ratios and phosphorus availability under equivalent nitrogen, phosphorus, and potassium inputs. 【Result】Results from ten consecutive cropping seasons over five years revealed no significant differences in the grain and straw yields of rice and wheat or in the total carbon, nitrogen, and phosphorus stoichiometric ratios among treatments. The stoichiometric ratios of available nutrients in soil, including dissolved organic carbon: available nitrogen, dissolved organic carbon: available phosphorus, and available nitrogen: available phosphorus, ranged from 7.08-7.39, 23.1-26.8, and 3.59-4.06, respectively, under the TM, FM, and HM treatments. Compared with CF, these treatments did not significantly alter the total nutrient stoichiometric ratios in the soil but significantly increased the soil organic phosphorus fractions (by 49.7%-58.2%, dominated by moderately labile organic phosphorus, NaOH-Po). Additionally, soil microbial biomass carbon (MBC), nitrogen (MBN), and phosphorus (MBP) in soil increased by 14.3%-61.1%, 4.37%-36.2%, and 46.4%-50.8%, respectively. The microbial stoichiometric ratios under all treatments were as follows: MBC:MBN (11.6-14.5), MBC:MBP (68.3-106), and MBN:MBP (5.32-7.32). The TM and FM treatments significantly reduced the stoichiometric ratio of enzyme activity (EEA(C:N)) but did not affect the overall soil-microorganism stoichiometric balance. 【Conclusion】These findings demonstrate that substituting 30% of chemical fertilizers with organic fertilizers can maintain crop yields while effectively enhancing soil available phosphorus content. This study underscores the critical importance of scientifically regulating the substitution ratio of organic fertilizers to optimize soil nutrient management, improve soil fertility, and promote sustainable agricultural development.
-
Effects of Biological Fertilization on the Phosphorus Solubilizing Bacterial Community and Maize Productivity in Upland Red Soil
Peng Ziyi, Zheng Jie, Zhu Guofan, Shi Guangping, Wang Xiaoyue, Ding Yanghuiqin, Zhou Shungui, Jiang Yu-ji
DOI: 10.11766/trxb202412310518
Abstract:
【Objective】Phosphorus solubilizing bacterial communities in the rhizosphere are critical functional components in soil phosphorus cycling. Their abundance, community composition, and diversity determine the activity of soil alkaline phosphomonoesterase (ALP) and phosphorus availability. Thus, this study aimed to explore the impact of different bio-fertilization regimes on phosphorus-solubilizing bacterial communities in red soil and maize productivity. 【Method】Based on a long-term (11-year) bio-fertilization experiment at the Yingtan Red Soil Ecological Experiment Station of the Chinese Academy of Sciences, four treatments were selected: chemical fertilizer + organic fertilizer (FO), FO + phosphate-solubilizing bacteria (FOP), FO + nematodes (FON), and FO + phosphate-solubilizing bacteria + nematodes (FOPN). Quantitative real-time PCR (qPCR) and high-throughput sequencing technologies were employed to elucidate the mechanisms through which biological amendments affect rhizosphere phosphorus solubilizing bacterial communities, ALP activity, and maize productivity. 【Results】(1) Compared with the FO treatment, bio-fertilization treatments (FOP, FON, FOPN) significantly improved soil fertility and maize yield, with the combined inoculation treatment (FOPN) showing the most pronounced effects. Soil organic carbon (SOC), total nitrogen (TN), available nitrogen (AN), available phosphorus (AP), and maize yield increased by 8.08%, 24.2%, 30.5%, 20.2%, and 39.7%, respectively. (2) Bio-fertilization significantly increased the abundance of rhizosphere phosphorus solubilizing bacteria, showing notable interactive effects, while the Shannon index remained consistently lower than that in the FO treatment. The abundance of phosphorus-solubilizing bacteria exhibited significant positive correlations with TN and AN. (3) AN, phosphorus solubilizing bacterial abundance and ALP activity were identified as the key drivers of maize yield. Structural equation modeling revealed that AN not only directly promoted maize yield but also indirectly enhanced yield by increasing phosphorus-solubilizing bacterial abundance and ALP activity. 【Conclusion】Bio-fertilization significantly increased phosphorus solubilizing bacterial abundance, suggesting that microbial population dynamics may regulate phosphorus uptake in maize. These amendments enhanced upland red soil fertility by indirectly promoting phosphorus solubilizing bacterial abundance and ALP activity, thereby facilitating organic phosphorus mineralization and maize growth.
-
The spatiotemporal variation characteristics of soil enzyme activity in alpine meadow after adding yak dung
SUBINUER·wubuli, YIN Xiaoyue, FENG Jingying, SUONAN Jiangcai, WANG Changting[†]
DOI: 10.11766/trxb202501160033
Abstract:
Yak dung is an important factor affecting the nutrient cycling of soil in alpine grassland ecosystems, and changes in soil enzyme activity can effectively measure the soil nutrient cycling processes. To explore the temporal and spatial variations in soil enzyme activity under the addition of yak dung in alpine meadows, a fluorescence analysis method using 96-well microplate enzyme assays was employed. Key enzymes involved in soil carbon and nitrogen transformation processes in the alpine meadow soils of the eastern Tibetan Plateau:β-glucosidase (BG), peroxidase (PER), phenol oxidase (PPO), β-N-acetylglucosaminidase (NAG), and protease (LAP)—were studied to analyze the potential impacts of yak dung decomposition over different periods in warm and cold seasons. Also, the effect of the yak dung on the determined properties was considered at varying distances from the dung pile (under the dung (D0), 10 cm away (D10), and 20 cm away (D20)). The results indicate that (1) The decomposition of yak dung in both warm and cold seasons significantly increased the activities of BG, PER, PPO, NAG, and LAP, with the highest enzyme activity observed under D0. As the decomposition time progressed from warm to cold seasons and the distance from the dung increased, soil enzyme activity gradually decreased; (2) The decomposition of yak dung in both seasons significantly enhanced the total soil nutrients (total carbon, total nitrogen, total phosphorus) and available nutrients (ammonium nitrogen, nitrate nitrogen, available phosphorus), soil moisture, and pH, although the impacts of decomposition time on these soil environmental factors varied between seasons. The correlation between soil physicochemical properties and enzyme activity in the cold season was significantly stronger than in the warm season, with the C/N ratio in the cold season having the most pronounced effect on enzyme activity. The addition of exogenous nutrients led to the redistribution of nutrients and organic matter, with changes in enzyme activity exhibiting spatial and temporal gradient distribution characteristics, which were significantly correlated with the distance from the dung (radiating outward) and soil depth (extending downward).
-
Impact Characteristics and Mechanisms of Warming on the Decomposition of Soil Organic Carbon Three Pools in Grasslands of the Loess Plateau
Feng Junhao, Liu Xiaowei, Jing Yudu, Liang Ke, Yu Qiang, Guo Liang
DOI: 10.11766/trxb202411150440
Abstract:
【Objective】Grasslands, as one of the most extensive ecosystems, play an important role in regulating the global carbon cycle through the decomposition of soil organic carbon (SOC) pools. However, the effects of global warming on SOC decomposition dynamics, and the underlying microbial and enzymatic regulatory mechanisms remain unclear. Here, we investigated how warming alters the decomposition dynamics of active, slow, and passive SOC pools, with a focus on microbial community composition and extracellular enzyme stoichiometry. 【Method】This study was conducted using surface soil collected from semi-arid grasslands on the Loess Plateau in a long-term incubation experiment. Soil samples were incubated at two controlled temperatures (15 °C and 25 °C) under constant temperature and humidity for 553 days (~1.5 year). During the incubation, soil respiration rates, microbial biomass carbon (MBC), extracellular enzyme activities, and microbial community compositions were systematically monitored. 【Result】The results showed that incubation at 25 °C significantly increased soil respiration rates, cumulative carbon emissions, and the decomposition rates of the three SOC pools (active, slow, and passive) compared to 15 °C. However, the magnitude of this enhancement diminished over time. Among the SOC pools, the active pool exhibited the most rapid decline in respiration rate, followed by the slow pool, with the passive pool showing the slowest decline. Additionally, microbial biomass carbon and bacterial diversity decreased more rapidly at 25 °C, accompanied by significant shifts in microbial community composition. The relative abundance of copiotrophic microorganisms, such as Proteobacteria and Ascomycota, decreased during the incubation, whereas oligotrophic microorganisms, including Actinobacteria and Ascomycota, increased. Notably, copiotrophic microorganisms were more dominant at 15 °C, while oligotrophic microorganisms were more prevalent at 25 °C. Microbial oxidative metabolism, nitrogen demand, and phosphorus demand increased progressively throughout the incubation, with overall higher levels observed at 25 °C compared to 15 °C. Furthermore, the response of the three carbon pool decompositions to temperature increase was regulated by extracellular enzymes and microbial community composition. Stepwise linear regression showed that under 15 °C incubation, MBC and oxidases were positive regulatory factors for the decomposition of the active and slow carbon pools, respectively. Under 25 °C incubation, NAG (β-1,4-N-acetylglucosaminidase), and AKP (alkaline phosphatase) were positive regulatory factors for the decomposition of the passive carbon pool. The partial least squares path model analysis indicated that incubation temperature and time significantly regulated microbial community composition. The microbial community composition positively regulated extracellular enzyme activity and exerted negative and positive regulation on the decomposition of the slow and passive carbon pools, respectively. Also, extracellular enzymes, as key regulatory factors for the decomposition of the active and passive carbon pools, exerted negative and positive regulation on the decomposition of these pools, respectively.【Conclusion】This study reveals that shifts in microbial community composition, particularly the shift in species with different ecological strategies, play a key role in regulating extracellular enzyme activities and stoichiometry, thereby mediating temperature-induced changes in SOC decomposition dynamics. These findings provide critical insights into the microbial and enzymatic mechanisms that drive SOC turnover under warming conditions, offering valuable evidence to enhance our understanding of global carbon cycling and its feedback to climate change.
-
Vertical Differentiation Characteristics and Main Controlling Factors of Acid Buffering Capacity in the Strongly Acidic Red Soil Regoliths
CUI Zixiao, WU Huayong, SONG Xiaodong, YANG Shunhua, ZHANG Ganlin
DOI: 10.11766/trxb202503090107
Abstract:
【Objective】This study aimed to investigate the vertical variation characteristics and controlling factors of acid buffering capacity (pHBC) of strongly acidic red soil regoliths.【Method】The strongly acidic red soil regoliths with pH values less than 5.0 were selected as the study objects, which are developed from Quaternary red clay (including an upper uniform red clay layer and a lower reticulate red clay layer) underlain by sandstone bedrock located at a small agricultural watershed in Yujiang District, Yingtan City, Jiangxi Province. Approximately 8-meter-deep soil-rock core samples were collected from two upland boreholes using drilling, which were classified into four layers, including a uniform red clay layer, reticulate red clay layer, weathered sandstone layer, and sandstone bedrock layer. Regolith pHBC and other related physicochemical properties were measured. Multiple linear regression and random forest modeling as well as acid-base equilibrium theory analysis were used to quantify the relative contributions of regolith organic matter, mechanical compositions, mineral compositions, iron and aluminum oxides, exchangeable base cations, exchangeable acidity, and pH to pHBC variations across different layers.【Result】The red soil regoliths exhibited layer-specific acid buffering characteristics. The regolith pHBC were 2.53 ± 0.41 cmol·kg-1·pH unit-1, 1.93 ± 0.59 cmol·kg-1·pH unit-1, and 1.39 ± 0.22 cmol·kg-1·pH unit-1 in the uniform red clay layer, the reticulate red clay layer, and the weathered sandstone layer, respectively. The regolith pHBC increased with depth in the uniform red clay layer, decreased with depth in the reticulate red clay layer and the weathered sandstone layer, and increased from the weathered sandstone layer to the sandstone bedrock layer. Interestingly, the exchangeable base cations of the Quaternary red clay layer at a strongly acidic state were exhausted and played a limited role in the changes of pHBC. Moreover, the pHBC depended on the protonation process of crystalline iron oxide and organic matter in the uniform red clay layer, the dissolution of amorphous and crystalline aluminum oxides and the protonation of amorphous and crystalline iron oxides in the reticulate red clay layer, and on feldspar dissolution and exchange of exchangeable calcium and magnesium ions in the weathered sandstone layer. Also, the dissolution of carbonates plays a key role in the pHBC in the sandstone bedrock layer.【Conclusion】The acid buffering mechanism in the strongly acidic red soil regoliths primarily centers around the protonation and dissolution processes of iron and aluminum oxides. These research findings provide support for the acidification assessment and improvement of the red soil ecosystems.
-
Response of Dissolved Organic Matter Content and Quality in Greenhouse Soils to the Application of Organic Fertilizers with Various Carbon Components
Xu Yehong, Ba Wenwen, Wang Xuanqing, Lu Chao, Luo Jia, Ma Yan
DOI: 10.11766/trxb202411190446
Abstract:
【Objective】Dissolved organic matter (DOM) is the most active functional component in the soil carbon pool, and the application of organic fertilizer is an effective measure for carbon sequestration and soil fertility improvement in greenhouse soils. However, the response of DOM content and quality in greenhouse soils to organic fertilizer is still unclear, which hinders the elucidation of the regulation mechanisms of the active carbon pool in greenhouse soils and the development of precise application technologies for organic fertilizers.【Method】This study was conducted in situ and five treatments were included: no fertilization as control (CK), chemical fertilizer only (F), and three organic fertilizers with different carbon components replacing 30% of chemical N fertilizer (composted straw replacing 30% of chemical N, FMs; chicken manure replacing 30% of chemical N fertilizer, FMc; and spent mushroom replacing 30% of chemical N fertilizer, FMm). The content of dissolved organic carbon (DOC) and dissolved organic nitrogen (DON) were studied in the surface and subsurface layers of greenhouse soils under vegetable cultivation. Combined with three-dimensional fluorescence spectroscopy technology and parallel factor analysis method, the fluorescence spectral characteristic parameters and chemical composition of DOM in soil were analyzed.【Result】Compared with CK, the F treatment had no significant effect on the DOC content in both the surface and subsurface soil; it only significantly increased the DON content in the subsurface soil, with an increase of 1.22-folds. The results showed that compared with F, the FMc organic fertilizer with the highest content of labile carbon components significantly increased the DOC and DON content by 44.2% and 78.1%, respectively, in the surface soil. However, only the DON content in the surface soil significantly increased under the FMs and FMm treatments. Compared with CK, the application of chemical and organic fertilizers significantly reduced the DOC/DON ratio in the surface and subsurface soils, and the humification index (HIX) of DOM in the surface soil significantly increased by 1.06 to 2.07-folds, reaching the highest in the FMc treatment. Also, the fluorescence spectral characteristics of DOM in the subsurface soil did not significantly respond to fertilization. In addition, the content of DOC and DON were significantly negatively correlated with fulvic acid-like components with low molecular weight, while significantly positively correlated with humic acid and aromatic components with high molecular weight.【Conclusion】In summary, the application of chicken manure rich in labile carbon components can more effectively increase the content of DOC and DON and the humification degree of DOM in the surface soil, and increase the proportion of refractory components of DOM in the subsurface soil. Thus, it is more beneficial to apply chicken manure to achieve the "double improvement" of the content and quality of labile carbon pools in the entire tillage layer of greenhouse soils under vegetable cultivation.
-
Study on Colloidal Properties of Purple Soil and Its Aggregation Kinetics under Different Fertilization Treatments
Zhang Yiwei, Tian Rui, Wu Wenfei, Bi Linna, Lv Runze, Li Hang
DOI: 10.11766/trxb202411010420
Abstract:
【Objective】The aggregation and dispersion of soil colloids influence macroscopic phenomena such as soil structure, soil erosion, soil nutrients, and pollutant transport. This study aims to explore the process of purple soil colloid aggregation and its ion-specific effects under different fertilization treatments. Specifically, the study aims to elucidate the interactions and microscopic mechanisms from the perspective of the effect of fertilization on mineral composition, surface properties, and aggregation kinetics of purple soil colloids. 【Method】In this study, four fertilization treatments, no fertilizer (CK), urea alone (N), organic fertilizer replacing 10% urea nitrogen (LM), and organic fertilizer replacing 30% urea nitrogen (HM) were set up on a purple soil in Southwest China. After 60 d of incubation, the effect of fertilization on the colloid aggregation kinetics of purple soils and their causes were investigated by determining the colloid quantity, clay mineral composition and surface properties, and soil colloid aggregation process. 【Result】The colloids used in this study contained mainly hydromica, chlorite, montmorillonite, vermiculite, and kaolinite, and the short-term fertilization treatments had no significant effect on the colloid content and mineral composition. Compared to CK, the N treatment induced the highest surface charge density to the purple soil colloids, with the greatest electrostatic repulsion between particles whereas LM and HM treatments decreased the surface charge density, and the degree of decrease was directly proportional to the amount of organic fertilizer added. The aggregation kinetics of soil colloids differed under different fertilizations and the critical coagulation concentration (CCC) decreased in the order of N > CK > LM > HM. Under the same fertilization treatment, the CCC values of purple soil colloids showed an ion-specific effect, decreasing in the order of Na+, K+, Mg2+, and Ca2+. Also, correlation analysis showed that there was a strong positive correlation between the CCC values of purple soil colloids and the surface charge density and a strong negative correlation with the specific surface area and organic matter content. 【Conclusion】Different fertilization treatments affect the interaction force between soil particles mainly by influencing the surface chemical properties of purple soil colloids, thus, affecting the aggregation and dispersive behaviors of the colloids.
-
Uptake and Accumulation of Fibrous Microplastics in a Corn Plant
LIU lu, LI Lianzhen, CHEN Zhekuan, MI Yixuan, SU Shikang, LIU Sizhi, WANG Yanhao, LIU Shaochong, YU Yaqi, SHE Xilin
DOI: 10.11766/trxb202412200497
Abstract:
【Objective】Microplastic pollution has emerged as a significant global environmental issue, with fibrous microplastics constituting a substantial portion of this pollutant. These tiny fibers, often derived from synthetic textiles and industrial processes, can infiltrate various ecosystems, including soil and water. Understanding the behavior and fate of fibrous microplastics in plants is crucial to assessing their potential ecological risks and human health implications. This study aimed to investigate the uptake and transport of polyacrylonitrile (PAN) fibrous microplastics in corn plants, a widely cultivated crop. 【Method】To achieve this, PAN microfibers, with an average diameter of 200 nm and an aspect ratio of 20±5 were synthesized using electrostatic spinning and fluorescently labeled to facilitate tracking. Corn seedlings were exposed to these labeled fibers under hydroponic conditions for two weeks. The distribution and localization of the fibers within the plant tissues were subsequently examined using laser confocal microscopy and scanning electron microscopy. 【Result】The results revealed that the PAN microfibers were able to penetrate the root interior through nascent lateral root fissures. Once inside the root, the fibers were transported upward along the xylem ducts to the stems. However, the fibers were not detected in the vascular tissues of the leaves, suggesting that their translocation was primarily restricted to the root and stem systems. The ability of corn roots to absorb and accumulate these fibers highlights the potential for microplastic bioaccumulation in plant tissues. Also, the large surface area of fibrous microplastics may have contributed to their efficient adsorption by root surfaces, facilitating their entry into the plant whereas the fibrous morphology enhanced their penetration through root tissues. In addition, the accumulation of fibrous microplastics in plants could potentially disrupt plant growth, development, and physiological processes. 【Conclusion】This study provides the first direct evidence of fibrous microplastic uptake and transport in higher plants, and highlights the possible transfer of fibrous microplastics from plants to herbivores and humans through the food chain. The research results provide an important scientific basis for in-depth understanding of the migration and transformation laws of different shapes of microplastics in plant-soil systems, and also provide support for an assessing their impact on ecological environmental health and food safety. Our results necessitate the need for further research to investigate the factors influencing fibrous microplastic uptake and transport in plants, the potential ecological and toxicological impacts of fibrous microplastic exposure, and effective strategies for minimizing their environmental and human health risks.
-
Elemental Geochemical Characteristics and Chemical Weathering Intensity of Soils in the Shergyla Mountain, Qinghai-Tibet Plateau
ZHANG Chu, YANG Jinling, YANG Fei, YE Mingliang, GU Jun, CHEN Yamin, ZHANG Ganlin
DOI: 10.11766/trxb202503130113
Abstract:
【Objective】This study aimed to unravel the weathering intensity and elemental geochemical characteristics of soils in the southern mountainous regions of the Tibetan Plateau. 【Method】 Shergyla Mountain in Linzhi City was selected as the study area. Fifteen typical soil profiles were sampled across different landscapes and altitudes, and the geochemical characteristics of soil elements were analyzed, with weathering intensity estimated for different soil horizons. 【Result】The results indicate that the soils of Shergyla Mountain, influenced by the alpine climate, are weakly developed, with the soil types dominated by Gelic Cambosols. For the studied soils, primary minerals were predominant in soil minerals while secondary minerals were present in low abundance. The Chemical Index of Alteration (CIA) ranged from 47 to 62, suggesting that most soils were in a state of weak weathering. The low temperatures at high altitudes restricted chemical weathering of soil minerals, resulting in insignificant impacts of precipitation, temperature, altitude, slope, and parent material on soil chemical weathering. The weathering intensity indicators (CIA, weathering leaching coefficient ba, Weathering Index of Parker WIP) across soil profiles exhibited different distribution patterns from the surface layer downwards, primarily influenced by transportation and deposition processes driven by external forces such as wind, gravity, and runoff. Nevertheless, the results indicate that chemical weathering had a relatively small impact on soil formation. 【Conclusion】The alpine environment controls overall soil development thus weakening the difference between other soil forming factors. The findings of this study provide theoretical support for the evolution of pedogenesis and soil classification on the Tibetan Plateau and offer pedological insights into the rational utilization of land resources.
-
Combined Effects of Microplastics and Herbicides on Soil Respiration and Spectral Characteristics of Soil Dissolved Organic Matter
XIE Yanjie, LI Yi, CHENG Hu, SHI Renyong, JIANG Xin, SONG Yang
DOI: 10.11766/trxb202501190038
Abstract:
【Objective】Microplastics and herbicides are ubiquitous contaminants in agricultural soils; however, their combined impact on soil carbon cycling and dissolved organic matter (DOM) remains underexplored.【Method】In this study, polylactic acid (PLA) microplastics and fomesafen were used as model contaminants to investigate their effects on soil carbon dioxide (CO2) emission and characteristics of DOM through soil incubation experiments as well as ultraviolet/fluorescence spectroscopy techniques.【Result】The results revealed that both PLA microplastics and fomesafen enhanced the CO2 emission rates in Mollisols and red soil during the 7–45 day incubation period. However, by the 60th day, individual treatment of fomesafen reduced the CO2 emission rate in red soil by 14.8% to 21.6%. Notably, the combined presence of fomesafen and PLA microplastics exhibited a synergistic effect, further suppressing the CO2 emission rate in red soil by 54.3% to 79.7%. The addition of 0.1% and 1% PLA microplastics increased the DOM content in both soil types. Ultraviolet/fluorescence spectroscopy analyses indicated that PLA microplastics enhanced the DOM humification and aromaticity of Mollisols. Also, the high level of combined contamination accelerated the transformation of organic matter in red soil. PARAFAC analysis identified three fluorescent components: terrestrial humic-like, short-wave humic, and fulvic acid-like substances. Polylactic acid microplastics significantly increased the content of these components in Mollisols, whereas the combined contamination did not markedly alter the DOM composition in red soil.【Conclusion】This study provides critical scientific data and insights into the effects of microplastics and herbicides on soil carbon cycling, contributing to a deeper understanding of soil ecological health and informing management strategies.
-
The Relationship Between Microbial Necromass Carbon and Soil Aggregate Stability on a Global Scale
Kuang Yanyun, Hu Han, Li Sen, Liang Yuting
DOI: 10.11766/trxb202409030355
Abstract:
【Objective】 The soil organic carbon (SOC) pool is the largest carbon reservoir in terrestrial ecosystems, playing an essential role in mitigating climate change and maintaining soil fertility. Among the various components of SOC, microbial necromass carbon (MNC) constitutes a significant proportion, contributing approximately 30-80% to the total SOC, and playing a crucial role in stabilizing soil carbon stocks. Accumulation and stabilization of MNC in soil are closely linked to the formation and stability of soil aggregates, which provide physical protection against microbial decomposition. Despite the known connection between MNC and soil aggregation, no comprehensive studies have systematically explored the relationship between MNC and soil aggregate stability. This study aims to further explore the global association between MNC and soil aggregate stability.【Method】 To assess the relationship between MNC and soil aggregate stability, we compiled global observational datasets on soil amino sugars (biomarkers of MNC) and soil aggregates. Using machine learning techniques, we predicted the global distribution of MNC and analyzed its correlation with the stability of soil aggregates. The PLS-PM was employed to further investigate the pathways through which soil aggregate stability influences MNC sequestration, takin into account factors such as soil physical properties, nutrient availability. 【Result】 The results revealed that MWD is a key predictor of MNC, with a significant positive correlation between MNC and MWD on a global scale (P < 0.05). Further correlation analysis of global prediction data confirmed this relationship and showed that it is consistent across different ecosystems. The Partial Least Squares Path Model (PLS-PM) analysis revealed that soil aggregates protect MNC directly by forming physical barriers and indirectly by regulating soil physical properties and nutrient availability, which in turn influence MNC accumulation and stabilization. In particular, soil nutrients had the most significant positive impact on MNC (path coefficient = 0.67, P < 0.05). The process through which MWD influences MNC shows significant differences across different ecosystems, specifically in terms of the direction and strength of the pathways. For example, in agricultural ecosystems, the indirect effects through soil physical properties and nutrients are more pronounced, while in forest ecosystems, the direct effect is stronger. 【Conclusion】The findings of this study underscore the significant role of soil aggregates in stabilizing MNC, and highlight the potential of soil aggregation as a key factor in enhancing soil carbon storage. Also, the positive correlation between MNC and aggregate stability suggests that strategies aimed at improving soil structure; eg., practices that enhance aggregation and optimize nutrient management, can effectively contribute to greater carbon sequestration. By fostering more stable soil aggregates, we can improve MNC sequestration, mitigate climate change, and sustain soil fertility. Furthermore, these findings can inform the development of predictive models for MNC sequestration and the integration of soil aggregate stability as a critical indicator for assessing the carbon sequestration potential of soils.
-
Effects of Different Organic Materials on the Stability of Saline-alkali Soil Colloid
SUN Yuliang, LI Qirui, Li Wei, Wang Xiang, SHANG Jianying
DOI: 10.11766/trxb202408300349
Abstract:
【Objective】Soil colloid stability plays an important role in soil nutrient retention, structure formation and crop growth. The application of organic materials is an effective method for improving saline-alkali soil, but their effects on soil colloid stability in these conditions remain unclear.【Method】In this study, we investigated the effects of biochar (BC), cattle manure (CM), and maize straw (MS) on soil colloid stability at different salinity-alkalinity levels (non-saline-alkali, mild saline-alkali and moderate saline-alkali) through soil incubation and sedimentation experiments in the laboratory.【Result】(1) The addition of organic materials significantly reduced the diameter of saline-alkali soil colloidal particles, making it similar to the diameter of non-saline-alkali soil colloid. In mild saline-alkali soil, the effect of MS treatment was most effective, and the colloidal particles size decreased from 785.7 nm to 360.2 nm. In moderate saline-alkali soil, the effect of CM treatment was most effective, decreasing the colloidal particles size from 675.8 nm to 393.6 nm. (2) The stability of soil colloid is related to the degree of soil salinity. Compared with non-saline-alkali soil and mild saline-alkali soil, moderate saline-alkali soil colloid exhibited significantly high stability, likely due to elevated high pH and high alkalinity. (3) Organic materials had minimal effect on the colloid stability of non-saline-alkali soil and mild saline-alkali soil. However, CM and MS treatments significantly reduced the colloid stability of moderate saline-alkali soil, causing colloidal particles agglomerated. Therefore, in moderate saline-alkali soil, the application of cow manure and maize straw may be more effective than biochar for stability improvement.【Conclusion】The application of organic materials ameliorates the basic physicochemical properties of saline-alkali soil and optimizes the state of soil colloid. Compared with biochar, cattle manure and maize straw, due to their rich functional groups and nutrients, significantly reduced the colloid stability of moderate saline-alkali soil upon application, thereby inducing colloidal aggregation and promoting the formation of microaggregates.
-
Study on the Composite Pollution of Degradable Microplastics and Thiacloprid
DOI: 10.11766/trxb202409150367
Abstract:
【Objective】Microplastics (MPs) and neonicotinoid pesticides are widespread pollutants in agricultural soils, however, their interactions have not been fully studied. Thus, this study aims to explore the interactive mechanisms between biodegradable MPs [poly(butylene succinate), PBS] and neonicotinoid pesticide (thiacloprid, THI). 【Method】The interactive and adsorption mechanisms of THI on PBS were investigated through adsorption kinetics and isotherm models by considering the influence of common environmental factors like pH, salinity, and dissolved organic matter. Also, the desorption of pre-adsorbed THI from PBS using pure water and simulated intestinal fluid (SIF) as background solutions was evaluated. In addition, the bioavailability of THI in red and black soils treated with different proportions of PBS was compared and analyzed using thin film diffusion gradient (DGT) technology. 【Result】The results revealed that the adsorption process of THI on PBS was consistent with the pseudo-second-order kinetic model, indicating that chemical adsorption was predominant. Also, the adsorption isotherm analysis indicated that the adsorption of THI by PBS was multi-layered, and the experimental data fitted both the Henry and the Freundlich models well (R2 > 0.99). The results also showed that an increase in pH and salinity promoted the adsorption of THI while changing the concentration of dissolved organic matter had little effect on the adsorption process. Furthermore, the desorption experiments found that using SIF, the maximum amount of THI desorbed was 39.4 μg?g-1, which was 1.16 times higher than that desorbed by pure water, suggesting that THI is more easily desorbed in the SIF environment. Using the DGT technology, it was observed that the bioavailability of THI in soil increased after the addition of PBS, and the increase became more significant as the ratio of PBS added was increased. 【Conclusion】PBS can adsorb and desorb THI, and when added to soil, PBS can affect the bioavailability of THI. These findings provide important information for understanding the impact of MPs on the environmental behavior of neonicotinoid pesticides under actual environmental conditions and offer a new perspective on the environmental risk assessment and management of pesticides.
-
Response Characteristics and Influencing Factors of Soil Organic Carbon to Reduced Chemical Fertilizers or Organic Fertilizer Substitution
Wu Nengxiang, Wang Ping, Liu Yalong, Wang Jingkuan
DOI: 10.11766/trxb202408190332
Abstract:
Delving into the impacts of reduced chemical fertilizers (RCF) and organic fertilizer substitution (OFS) on soil organic carbon (SOC) is crucial for understanding the response processes of agricultural SOC pools to fertilization and achieving sustainable agricultural development early. This study aims to explore the impacts of RCF and OFS on SOC under different climatic conditions, initial soil properties, and land use patterns. Furthermore, it endeavors to estimate the key influencing factors and clarify the natural and anthropogenic conditions conducive to SOC accumulation.【Method】After collecting and sorting out 142 published literature, we analyzed the variation characteristics of SOC content under RCF and OFS using meta-analysis. Thereafter, the influence degrees of various factors on SOC were systematically investigated by the Random Forest Model.【Result】The results revealed that SOC decreased by 2.61% on average under RCF. Notably, greater SOC losses were observed in temperate regions (with annual mean temperature < 10°C and annual mean precipitation < 1000 mm), whereas SOC losses were not significant with changes in altitude. Soils with high initial SOC content favored SOC retention. With soil’s initial pH and available phosphorus content increasing, the overall loss of SOC tended to intensify, with the highest SOC reduction reaching 6.91%, however, the effect of initial available potassium was the opposite. The declines in SOC under RCF were similar in farmland and orchards, while changes in SOC in vegetable fields were not significant. In contrast, SOC significantly increased by 14.39% under OFS, with subtropical regions at low to medium altitudes and annual precipitation < 600 mm being more conducive to SOC accumulation. Except for low levels of initially available nitrogen (50 mg·kg-1), no significant differences in SOC were observed among soils with different initial SOC, total nitrogen, and available nitrogen contents. With initial pH and available phosphorus content increasing, the cumulative effect of SOC enhanced, whereas the effect of initially available potassium was the opposite. Among different land use types under OFS, paddy-upland rotation and vegetable field utilization were most favorable for SOC accumulation.【Conclusion】Under the two fertilization systems, the climatic and environmental conditions in subtropical regions are more conducive to SOC sequestration. Compared to the subsurface soil, the impact of RCF and OFS on SOC in the surface soil was more significant. The decline in SOC of RCF was similar in both farmland and orchards, while the change of SOC in vegetable fields was not significant. In contrast, paddy-upland rotation and vegetable fields were the most favorable practices for SOC accumulation under OFS. Additionally, pH and initially available nitrogen were the most critical factors influencing the changes in SOC with RCF and OFS, respectively. These research results are of great significance for achieving carbon neutrality and sustainable development in agriculture as soon as possible.
-
Effects of Microplastics with Different Concentrations and Particle Sizes on N2O Emissions from Agricultural Soils Under Different Temperature Conditions
SHI Mengxuan, LI Haochen, ZHOU Pengyu, WAN Quan, CHEN Zonghai, LI Yige, LU Ying, LI Bo
DOI: 10.11766/trxb202406040221
Abstract:
【Objective】Microplastic (MP), with its small size and low degradability, is recognized as a potential persistent organic pollutant in terrestrial ecosystems. MP enters terrestrial ecosystems and affects the soil nitrogen cycling process by changing the soil’s physical, chemical, and biological properties. These changes affect soil N2O emission. Despite having gained global attention, the key factors and mechanism of MP influence on soil N2O remain unclear. Therefore, this study aimed to investigate the effects of MP size and concentrations on N2O emission from agricultural soils at different temperatures and thus explore their potential mechanism. 【Method】Agricultural soils were collected from plots in South China for indoor culture experiments, and five different treatment sets were selected under three temperature gradients (10 ℃, 20 ℃ and 30 ℃): (1) no microplastics (CK); (2) addition of microplastics with a mass concentration of 0.1% and a particle size of 74 μm (Nlp-0.1%); (3) addition of microplastics with a mass concentration of 0.5% and a particle size of 74 μm (Nlp-0.5%); (4) addition of microplastics with a mass concentration of 0.1% and a particle size of 25 μm (Nsp-0.1%); and (5) addition of microplastic with 0.5% mass concentration and a particle size of 25 μm (Nsp-0.5%). Afterward, soil N2O concentration as well as inorganic nitrogen and microbial functional genes were determined. 【Result】Elevated temperature significantly increased soil N2O emissions from agricultural soils (P < 0.001), and the cumulative soil N2O emissions at 30 ℃ were 43.3 and 6.3 times higher than those at 10 ℃ and 20 ℃, respectively. In addition, soil NO– 3-N content gradually increased with increasing temperature. The abundance of AOB amoA, Comammox (com2), nirS, nirK, and nosZ functional genes was the highest at 20℃ and lowest at 30℃. The effects of MP of different sizes on soil N2O emissions and related nitrogen cycle functional genes varied widely. Compared with the CK treatment, the Nlp treatment significantly increased soil N2O emission by 37.5% and 838.7% at 10 ℃ and 20 ℃ (P<0.001). The Nsp treatment significantly decreased the abundance of com2 and nirK functional genes but significantly increased the abundance of nirS functional genes in soil (P<0.001). The correlation and random forest analyses showed that soil N2O emission was significantly and positively correlated with temperature and the concentration of NO– 3-N, but significantly and negatively correlated with the abundance of AOA amoA, nirK, nirS, and nosZ functional genes (P<0.05). Furthermore, it was observed that the nosZ functional genes and temperature were the main factors affecting soil N2O emission. 【Conclusion】Elevated temperatures significantly increased N2O emissions from agricultural soils, and different particle sizes and concentrations of MPs had different effects on soil N2O emissions, and there was an interaction effect between microplastics and temperature. The results of this study can provide a scientific basis for investigating the mechanism of MP on N2O emissions from agricultural soils under global warming conditions and for risk assessment.
-
Progress of soil temperature prediction equation
Zhang Jianbin, Gao Zhi Qiu, Tong Bing, Wang Linlin
DOI: 10.11766/trxb202210220581
Abstract:
Soil temperature (especially surface temperature) is a key physical quantity in the interaction between land and atmosphere, and plays a very important role in the earth system. Soil temperature prediction technology has always been the core scientific problem in land surface model, numerical weather prediction and climate prediction. This paper systematically reviews the research progress of soil temperature prediction equation, from the classical heat conduction equation to the heat conduction convection equation that takes into account the physical process of vertical movement of soil moisture, from the single sine wave approximation to the Fourier series approximation of the daily change of surface temperature, from the assumption that the diurnal change of convection parameters is constant to the consideration of its diurnal change, and emphatically summarizes the creation, improvement and solution of the soil heat conduction convection equation. Finally, this paper reviews the application of heat conduction convection equation in the study of surface energy balance, vertical movement of soil moisture, water flux, earthquake and frozen soil heat transfer. At the same time, it is pointed out that the influences of soil water phases and plant roots on the heat conduction-convection equation is warranted for the future research of soil temperature prediction equation.
About
Supervisor: Chinese Academy of Sciences
Sponsor:Soil Science Society of China
Editor-in-Chief:Xu Renkou
Address:71 East Beijing Road, Nanjing 210008, P. R. China
Zip Code:210008
Phone:+86-25-86881237
Email:actapedo@issas.ac.cn
ISSN:0564-3929
Qr Code
-
WeChat